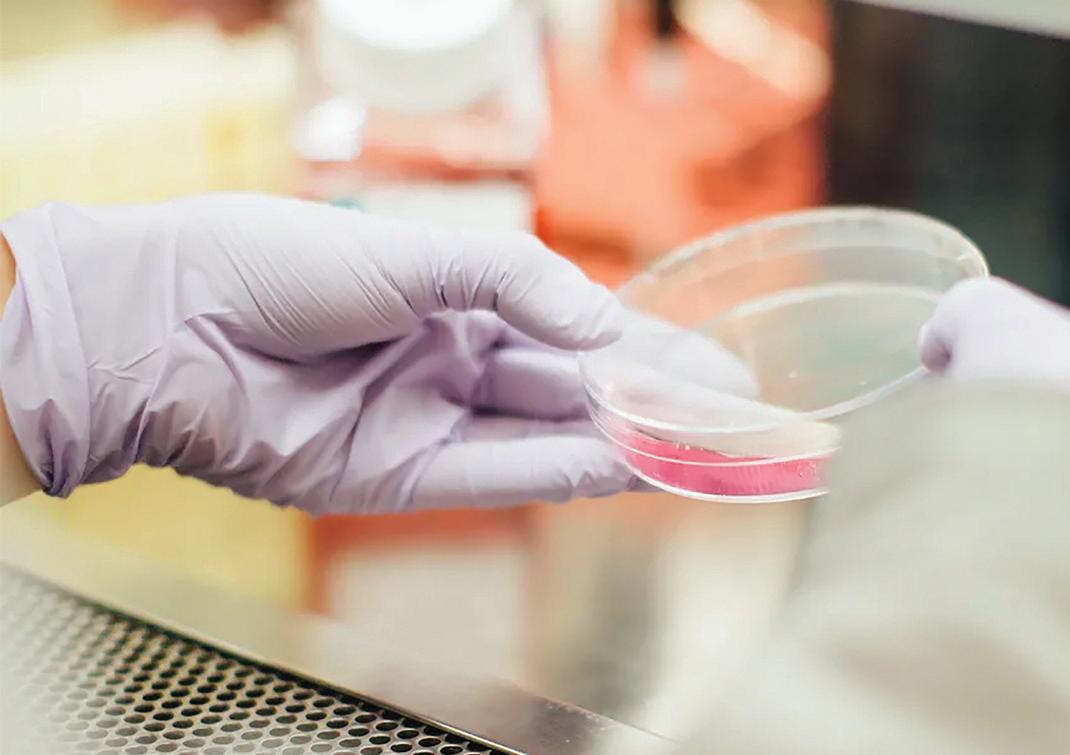

EXCLUSIVE INTERVIEW: PRECISION IN MOTION
MIDSTREAM & PIPELINE SECTORS: BIG FOCUS
AUTOMATION: DO’S AND DONT’S
A DEEP DIVE INTO THE CURRENT FPSO MARKET
Spring
2024 Helping Lead the Energy Transition
Emery Hill Media Ltd. © 2024
INNOVATION

www.oilandgasinnovation.co.uk
CEO Matthew Patten
Managing Editor
Simon Milliere
Publishing Director
Edward Findlay
edward@oilandgasinnovation.co.uk
Commercial Director & Advertising Enquiries
Nicholas Parker nparker@oilandgasinnovation.co.uk
Technical Director and Website
Nathan Bedmann web@oilandgasinnovation.co.uk
Office Assistants
Janet Elseberg admin@oilandgasinnovation.co.uk
Contributing Journalist
Emma Patten
Business Development Executives
Mylene Daugan
mylene@oilandgasinnovation.co.uk
Augusto Trinidad Jr
augusto@oginnovation.co.uk
Tim Martens
tim@oginnovation.co.uk
Janna Garcia
jannagarcia@oginnovation.co.uk
Anjel Miller
anjel@oginnovation.co.uk
Emery Hill Media
Dalton House
60 Windsor Avenue
London
SW19 2RR
Tel: +44 330 043 49
Follow Us



A NOTE FROM THE EDITOR
Navigating the Waves: A Deep Dive into the Current FPSO Market
The Floating Production Storage and Offloading (FPSO) market has been a cornerstone of the offshore oil and gas industry for decades, offering a flexible and cost-effective solution for the production and processing of hydrocarbons in remote and deepwater environments. As we sail into 2024, the FPSO market continues to evolve in response to shifting global energy dynamics, technological advancements, and environmental considerations.
The FPSO market is experiencing a period of transition and adaptation. Several factors are influencing its current trajectory. The volatility in oil prices over the past years has significantly impacted investment decisions in the oil and gas sector, including FPSO projects. While lower oil prices can delay investment in new projects, they also drive efforts to optimize existing assets, thus increasing demand for FPSO services.
The global push towards renewable energy sources and decarbonization initiatives has spurred discussions about the future of fossil fuels. However, oil and gas remain integral to the energy mix for the foreseeable future, particularly in meeting the rising demand from emerging economies. FPSOs, with their versatility and mobility, continue to play a vital role in offshore oil and gas production, offering operators the flexibility to adapt to changing market dynamics.
Technological Innovation: Advancements in technology have led to the development of more efficient and environmentally friendly FPSO designs. From enhanced processing capabilities to the integration of digital solutions for predictive maintenance and remote monitoring, these innovations are enhancing the reliability, safety, and productivity of FPSO operations.
Stricter environmental regulations and growing societal pressure to reduce carbon emissions are driving the adoption of cleaner technologies within the oil and gas industry. FPSO operators are increasingly investing in solutions to minimize their environmental footprint, such as incorporating renewable energy sources, implementing emissions-reducing technologies, and adopting stringent waste management practices.
Despite the challenges posed by market volatility and the energy transition, the FPSO market remains resilient, with several key trends shaping its future. As the energy landscape evolves, FPSO operators are exploring opportunities to integrate renewable energy sources, such as wind and solar, into their operations. Hybrid FPSO systems that combine conventional oil and gas production with renewable energy generation are emerging as a viable solution to reduce carbon emissions and enhance operational efficiency.
The adoption of digital technologies, including artificial intelligence, IoT sensors, and predictive analytics, is transforming FPSO operations. These technologies enable real-time monitoring of equipment performance, predictive maintenance scheduling, and optimization of production processes, leading to improved asset reliability and operational efficiency.
With many FPSOs reaching the end of their operational life, decommissioning activities are on the rise. However, operators are also exploring options to extend the life of existing assets through refurbishment, upgrades, and repurposing initiatives. This trend is driven by the desire to maximize the value of existing investments and minimize environmental impact.
The FPSO market is at a pivotal juncture, characterized by both challenges and opportunities. While the industry grapples with the uncertainties of oil price volatility and the energy transition, technological innovation, environmental stewardship, and market diversification are driving its evolution.
As FPSO operators navigate these uncharted waters, agility, innovation, and collaboration will be key to unlocking value, mitigating risks, and ensuring sustainable growth in the years to come. By embracing change and leveraging the latest advancements in technology and best practices, the FPSO industry is wellpositioned to chart a course towards a more efficient, resilient, and environmentally responsible future.


2
HILL MEDIA © 2024
Spring 2024 EMERY






COVER STORIES & SPECIALS
Interview: Precision in Motion
In the dynamic landscape of the oil and gas sector, innovation and precision are paramount. Enter ANT AG, a global leader renowned for its cutting-edge technology and manufacturing prowess in mobile waterjet cutting systems.
WORLD INDUSTRY NEWS
EXPLORATION & PRODUCTION
Continuous Production Logging From Tracers.
Tracking fluid connections using tracer is a well-known technique across multiple science disciplines, including oceanography, hydrology, meteorology as well as in petroleum science. In most applications unique tracers are introduced at specific locations as a neat liquid or as a small pre-mixed batch of liquid containing the tracer substance. Once introduced, the tracer provides direct proof of mass transport from one location to another.
Innovative Pumping Solutions
The Buzzard oil field, located about 100 kilometers northeast of Aberdeen, has been a central hub in the European oil and gas industry since its discovery in 2001. The field plays a pivotal role in the energy supply chain, contributing to the vast oil and gas network that sustains the region’s economic vitality. Despite its importance, the Buzzard field presented a unique challenge because of the presence of mercaptan in its crude oil, leading to a groundbreaking solution from SEEPEX that has transformed operations.
Keeping Oil and Gas Customers in Stock
Based in Newcastle, UK on the banks of the River Tyne, a family-run business with an abundance of knowledge and experience to share with the oil and gas industry.
Powering Up Subsea Operations
22 24 26 28



4
CONTENTS 8 22 8
Europe North America Africa Asia Pacific MENA 10 32 64 58 72 28








MIDSTREAM & PIPELINES
Enhancing Safety and Efficiency
Gas detection systems during shutdowns and the tracking and maintenance of your fleet.
Tank Inspection on FPSO, Gets Surveyor Approval On-The-Spot
TDBR has performed visual inspection on a large FPSO offshore of Brazil, using the Scout 137 Drone System from ScoutDI. This being a large unit, the tethered solution of the ScoutDI drone becomes indispensable with its unlimited flight-time.
Pathfinder® Foam Caliper Pig, The Next Generation.
The Pathfinder foam caliper pig is unique in the smart pigging arena. With more than 300 successful projects completed and over 10,000 km of pipeline surveyed since initial development in 2016, it has fast become an established geometry inspection technology supporting a range of pipeline pigging applications from construction through to decommissioning.
Automation Done Right – Do’s and Don’ts
One of the key components of any oil and gas project are pipes. Whether it is a refinery, a tanker, an offshore rig, or simply a crosscountry pipe-line, it is impossible to complete without extensive piping systems.
PROCESSING
Online TOC Analysis in Return Condensate and Boiler Feed Water
TOC analysers as money makers in refineries Crude oil refinement is a very energy intensive process. Steam and hot water are of a big concern for processing. HYDROGEN




6
CONTENTS
HEALTH, SAFETY & ENVIRONMENT EVENTS CALENDAR 56 50 38 36 36 40 56 50 42 56 80
HAMPRO® HIGH-PRESSURE PROCESS TECHNOLOGY
The high-pressure pumps of the HAMPRO® series are used in the Oil and Gas Industries to pump a very wide range of fluids, meet the stringent requirements of the relevant safety and reliability regulations and are characterized by a robust design and careful use of resources.
Our experienced team of experts will be happy to help configure the perfect solution for your individual application.














RECIPROCATING PUMPS
TO API 674
- Glycol pumps
- Leak test pumps
- Methanol pumps





- Produced water injection pumps
- Sea water injection pumps
Pressure: 50 – 4000 bar
Flow rate: 0,1 – 256 m³/h
Hammelmann GmbH
Carl-Zeiss-Straße 6-8
(0) 25 22 / 76 - 0 pp@hammelmann.de
D-59302 Oelde www.hammelmann-process.com
TAILOR-MADE AND
INTEGRATED
FULLY

Precision in Motion: Exploring ANT AG’s Innovations
In the dynamic landscape of the oil and gas sector, innovation and precision are paramount. Enter ANT AG, a global leader renowned for its cutting-edge technology and manufacturing prowess in mobile waterjet cutting systems. With over two decades of expertise, ANT AG has carved its niche by offering tailored solutions that merge safety, efficiency, and environmental consciousness. In this exclusive interview with OGI, we delve into ANT AG’s credentials, particularly its subsidiary, ANT UK, which has recently emerged to bolster customer service in the region. From pioneering Water Abrasive Suspension (WAS) cutting systems to its pivotal role in offshore decommissioning projects, ANT AG unveils its commitment to excellence, innovation, and safety in every facet of its operations.
OGI: Could you start by explaining ANT UK’s credentials and experience in terms of your products and services for the oil and gas sector? Could you tell our readers the breadth of your experience, how long the company has been active, and its reach?
ANT AG: ANT, a global leader in technology and manufacturing of mobile waterjet cutting systems, boasts 25 years of experience. We have collaborated with over 100 clients worldwide and actively engage in research and development, holding more than 100 patents globally. In the oil and gas sector, we offer tailored solutions, provide training, and assist clients with their projects. Our subsidiary, ANT UK, was recently established to enhance customer service.
ANT specializes in advanced abrasive cutting and eroding technology, offering integrated solutions for challenging tasks in a safe, efficient, and environmentallyfriendly manner. These solutions are particularly crucial for offshore structures in both the oil and gas and wind power industries. With over two decades of experience, we have partnered with global oil and gas companies and major industry service providers, successfully supporting various projects worldwide.


OGI: Could you explain to our readers the advantages of your Water Abrasive Suspension (WAS) cutting systems?
ANT AG: In WAS (Water Abrasive Suspension) systems, abrasive particles are directly suspended in water, resulting in a significantly more stable, precise, and powerful ANT suspension jet compared
to conventional waterjets. Moreover, ANT WAS systems operate without air inside the jet, eliminating the need for high pressure and conserving resources. This technology is versatile, capable of cutting a wide range of materials. The process is contactless, generates no heat, and prevents deformation.
This specialized waterjet cutting technique can be applied both in the air and underwater, as well as in potentially explosive and sensitive environments. Depending on the application, WAS enables safe and remote cutting of materials up to 1,000 mm thick from distances of up to 1,000 m, and up to 250 m underwater.

OGI: What are ANT UK goals in the UK?
ANT AG: Our primary goal at ANT UK is to prioritize customer proximity and service excellence. This is why we took the initiative to establish our presence here. With the rugged North Sea right on our doorstep, we are uniquely positioned to support and facilitate numerous
8
COVER STORY
External pile cutting with chain manipulation system.
Internal pile cutting up to 118’’ with DCH 4.
Liam Toovey, ANT Applied New Technologies AG
decommissioning projects in the region. Our commitment is to offer local expertise and dedicated service to our clients, ensuring that we are readily available to meet their needs and challenges in the UK market, especially given that many local service providers are our clients as well.
OGI: Can you talk about the work that ANT does in relation to decommissioning?
ANT AG: In the context of decommissioning, our products and integrated solutions are tailored to address challenging tasks safely, efficiently, and in an environmentallyfriendly manner. These solutions are particularly effective for sustainable repairs, demanding production enhancements, efficient decommissioning, and Plug & Abandonment operations.

the optimal cuts, tools to be used, and estimated cutting durations. This planning tool enhances project efficiency and reliability.
Our technology allows for the cutting of multistring conductors, piles, and structures up to 5 meters below the mudline using our unique cutting technology and equipment.
ANT’s expertise extends to cutting concentric multistring dual bore wells in a single pass without the worry of concentricity . They also offer manipulation systems designed for external cutting of piles and other offshore structures, which can complement an offshore cutting spread for internal cutting or be integrated into a customized WAS cutting system tailored to address a wide range of cutting challenges both offshore and onshore.
Certainly, when it comes to decommissioning, ANT offers a range of innovative solutions and services. Our cutting-edge technology includes remote-operable systems equipped with signals that provide real-time visualization of the cutting process. This feature allows operators to monitor and assess the progress of their cuts in real-time, ensuring precision and efficiency.
In addition to this, we provide our clients with the unique ANT Cutting Calculator. This invaluable tool enables our clients to plan their projects with precision, helping them determine
We understand the unique challenges faced by our customers, and we are dedicated to helping them find the best solutions for their business operations. Our solutions are suitable for ATEX zones, easy to set up, and have a small footprint.
We take pride in offering comprehensive support, including commissioning, system testing, onsite support withand thorough training to ensure our clients are well-prepared to utilize their waterjet cutting systems safely and effectively. Safety is paramount in everything we do.
Furthermore, our own service team is on hand to provide maintenance services, ensuring minimal downtime and reliable troubleshooting, including through augmented reality tools.
At ANT, we embrace challenging projects and have a dedicated research and development team with extensive experience, technological expertise, and a commitment to innovation. We also collaborate with universities and research institutes to drive innovation and continuously improve our solutions.
For P&A and challenging wells, we have
developed our own product called wellANT. This tool doesn’t cut but rather erodes, for instance, removing stuck plugs effortlessly with our two-phase jet.
OGI: What is the DCH 4 and it’s applications?
ANT AG: The DCH 4, or Downhole Cutting Head 4, is a specialized manipulation tool designed by our company in response to global market demands for offshore decommissioning projects. It stands out for its continuous clamping mechanism and stepless extendable cutting head, enabling it to cut a wide range of pipe diameters efficiently.
The DCH 4 Manipulation Tool is versatile and suitable for various offshore decommissioning applications, such as efficiently and accurately cutting piles with diameters ranging from 70” to 90” and from 90” to 118”.
OGI: What type of products do you have that suitable for ATEX zones?
ANT AG: All of our decom waterjet systems are ATEX zone certified, including our comprehensive range of products designed for operations in potentially explosive atmospheres. This includes all Downhole Cutting Heads/Manipulation Tools (e.g., DCH 1-4, PCH for internal cutting, Chain manipulator for external cutting), our Packer, capable of cutting in waters up to 250 meters deep, as well as our Pump, Lifting Unit, Control Container, and Systems. Furthermore, our central component, the Abrasive Mixing Unit (AMU), is fully approved for ATEX Zone II 3G IIB T3 environments, ensuring that our entire product range is suitable for use in such zones while maintaining the highest safety standards.

OGI: Thank you for your time. •
If you would like to know more about how ANT Applied New Technologies AG can help your company and its operations, please contact them:
ANT Applied New Technologies AG
T.: +44 7904 244738
E: decom@ant-ag.com
W: https://www.ant-ag.com

9
Plug Removal & Rigless Sidetracking with wellANT.
KROHNE Reaches Important Milestone in Ethernet-APL technology
In December 2023, KROHNE made Ethernet-APL demo devices available to selected customers. This step marks an important milestone in the company’s own Ethernet APL development project for various sensor types.
Ethernet-APL technology is a revolution in the process industry: for the first time, a high data rate (10 Mbit/s) is combined with intrinsic safety for the field level. In addition, the technology enables a two-wire operation including power supply. KROHNE was a founding member of the Ethernet-APL consortium in 2018 and has thus actively promoted the technical design of the standard.
Customer interest in Ethernet-APL has been growing steadily for several years, particularly in the chemical industry, but also beyond. “With Ethernet-APL, we are fully digitalizing the field level,” explains Dr Christoph Spiegel, Head of Strategic Product Management in the Electronics Division at KROHNE. “Our demonstrators already have most of the functions that are possible with this technology. They provide the implementation of PROFINET according to the PA (Process Automation) profile 4.0 with generic or alternatively manufacturer-specific GSD file. There is also an FDI package for use with all modern asset management systems and an integrated web server with a convenient user interface for simple commissioning and diagnostics.”
“We hope that we can obtain early feedback and test results via the demonstrators, including interoperability test results with various host systems,” continues Spiegel. “We want to strengthen our customers’ trust in KROHNE as a reliable partner that brings the latest technology into practice at an early stage. Ethernet-APL is still a very young technology, which is why we are working particularly closely with users here. Looking at the progress of the project, I am confident that KROHNE will be able to present the first Ethernet-APL devices by the end of the fourth quarter of 2024.”•

Global LNG Demand to Grow Beyond 2040, Driven by Industrial Demand in China and Economic Development in South Asia and SouthEast Asia
London
– Global demand for liquefied natural gas (LNG) is estimated to rise by more than 50% by 2040, as industrial coal-to-gas switching gathers pace in China and South Asian and South-east Asian countries use more LNG to support their economic growth, according to Shell’s LNG Outlook 2024.
Global trade in LNG reached 404 million tonnes in 2023, up from 397 million tonnes in 2022, with tight supplies of LNG constraining growth while maintaining prices and price volatility above historic averages. Demand for natural gas has already peaked in some regions but continues to rise globally, with LNG demand expected to reach around 625-685 million tonnes a year in 2040, according to the latest industry estimates.
“China is likely to dominate LNG demand growth this decade as its industry seeks to cut carbon emissions by switching from coal to gas,” said Steve Hill, Executive Vice President for Shell Energy. “With China’s coal-based steel sector accounting for more emissions than the total emissions of the UK, Germany and Turkey combined, gas has an essential role to play in tackling one of the world’s biggest sources of carbon emissions and local air pollution.”
Over the following decade, declining domestic gas production in parts of South Asia and South-east Asia could drive a surge in demand for LNG as these economies increasingly need fuel for gas-fired power plants or industry. However, countries in South Asia and South-east Asia would need significant investments in gas import infrastructure.
The Shell LNG Outlook 2024 shows that gas complements wind and solar power in countries with high levels of renewables in their power generation mix, providing short-term flexibility and long-term security of supply.
European energy security
LNG continued to play a vital role in European energy security in 2023, following a slump in Russian pipeline exports to Europe in 2022, with new regasification facilities helping to improve security of energy supplies. European LNG imports remained at similar levels to 2022, despite an overall decline in European gas demand in 2023.
Relatively mild winter temperatures in countries that rely on gas for heating, combined with high gas storage levels, stronger nuclear power generation and a modest economic recovery in China, all helped balance the global gas market in 2023.
This helped bring down and stabilise gas prices in the key importing regions of Europe and East Asia compared to the record highs and unprecedented volatility seen from late 2021 through 2022. However, gas prices and volatility remained significantly higher in 2023 than in the 2017-2020 period. •

10
NEWS - EUROPE
SMART PIPE-SHOP AUTOMATION

Eni, Fincantieri and RINA Establish Partnership for Maritime Transport Decarbonization

Rome, Eni, a global energy company, Fincantieri, one of the world’s largest shipbuilding groups, the only one active in all high-tech marine industry sectors, and RINA, a multinational inspection, certification, and engineering consultancy, have signed an agreement to develop joint initiatives for the energy transition. The partnership formalises the commitment to develop joint projects, in line with the partners’ strategies, to decarbonise the maritime sector in the medium to long term with the goal of Net Zero by 2050. Additionally, the establishment of a permanent global observatory regarding future technological, regulatory, and market developments will be evaluated.
The three companies will conduct a comprehensive analysis and evaluation of the most sustainable alternatives to support the maritime decarbonisation pathway. This will also be based on the development of complementary solutions to fuels already available for other hard-to-abate sectors. The partnership’s areas of interest also include an analysis of the reference energy infrastructure and the development of new logistic structures, including the investments that the sector requires.
Giuseppe Ricci, Chief Operating Officer for Energy Evolution at Eni, commented: “The collaboration with Fincantieri and RINA, two major Italian players, is a further step in our journey towards the transition and decarbonisation of maritime transport. To meet the objectives of the UN 2030 Agenda, it is important not only to manage what is immediate but also to act with a medium to long-term perspective, developing partnerships to create more sustainable solutions and products. The ability to network among the partners, with their wealth of skills and technological capabilities, can make a significant contribution to finding more effective solutions for decarbonising maritime transport and meeting the needs of shipowners and logistics operators, always leveraging a holistic approach”.
Pierroberto Folgiero, CEO and Managing Director of Fincantieri, said: “We are highly committed to supporting our clients in addressing the industrial challenges of the maritime energy transition, and this initiative is aimed at initially creating a hub of study to harness Italy’s extraordinary expertise in new technologies, novel fuels, and their profound industrial implications for the ship system. We are very pleased to join forces with Eni and RINA in an alliance to materialize existing solutions and to pave the way for the future with a proactive ecosystem approach. Indeed, new technologies must be industrialized on board ships, just as new fuels must be produced and distributed at the dock. Only with a concept of “operationalizing innovation”
can we lead our industry and project our shipbuilding leadership into the future”.
Carlo Luzzatto, CEO and General Manager of RINA, said: “We strongly believe in the value of collaboration and the opportunities it brings, particularly when it involves players of international calibre such as Eni and Fincantieri. Together, we have the opportunity to share knowledge and experience and to contribute to more sustainable solutions that support the shipping supply chain. RINA brings to the partnership its engineering and technological skills, developed across various sectors, to support shipping in its journey towards reducing its carbon footprint, without excluding any energy options”.
The understanding may be the subject of subsequent binding agreements that the parties will define in compliance with the applicable legislation, including that relating to transactions between related parties. •
Siemens @ Hannover Messe 2024
Cedrik
Neike, Member of the Managing Board of Siemens AG and CEO of Siemens Digital Industries, will share the solutions Siemens is developing for a sustainable, resilient and intelligent industry.
In order to become more sustainable along the entire value chain, industrial enterprises need to drive their digital transformation forward. Artificial intelligence, sustainability and competitiveness are focus of the motto “Accelerate Transformation”. Find out what it means for industrial companies to quickly become a sustainable and resilient Digital Enterprise. At this year’s Hannover Messe, Siemens will use showcases from the automotive, chemical, food and semiconductor industries to demonstrate how we connect the real and digital worlds to design, manufacture and recycle products. •
OPTIBAR FC 1000: new flow Computer Complements the KROHNE DP Portfolio
WithOPTIBAR FC 1000, KROHNE introduces a compact, high performance flow computer for volumetric flow calculation and heat quantity measurement of liquids and gases, including saturated steam and superheated steam. The device complements the extensive portfolio for differential pressure flow applications that KROHNE has been steadily expanding since 2010.
Its compliance with IAPWS-97 for water and steam calculations with condensate detection, makes this flow computer particularly useful for differential pressure (DP) flow measurement of saturated and super-heated steam. In addition, a variety of other calculation methods are available for the correction calculation of gases and liquids. For highly accurate measurements, the KROHNE flow computer provides correction of linearity errors of DP flow elements in real-time and in accordance with ISO 5167 requirements. •

12 NEWS - EUROPE

Repsol Begins Large-Scale Production of Renewable Fuels in Cartagena, the First Plant of its Kind in the Iberian Peninsula
• Repsol is the only company in Spain and Portugal with a plant fully dedicated to the production of renewable fuels on an industrial scale.
• The new plant has the capacity to annually produce 250,000 tons of renewable fuels from waste, such as used cooking oil. The fuel can be used in airplanes, ships, buses, trucks, or cars.
• Renewable fuels are an already available alternative that can be used in existing vehicles and infrastructures to help speed up the decarbonization of transport.
• The renewable fuels manufactured in Cartagena will avoid the emission of 900,000 tons of CO2 per year.
Repsol marks a milestone in the decarbonization of transport in the Iberian Peninsula with the start of large-scale production of renewable fuels at its industrial complex in Cartagena (Spain). This plant is the first on the Iberian Peninsula dedicated exclusively to the production of 100% renewable fuels. The company has invested €250 million in the construction of the unit, which has a production capacity of 250,000 tons per year. It can produce renewable diesel and Sustainable Aviation Fuel (SAF), which can be used in any means of transport: cars, trucks, buses, ships, or airplanes, and with existing refueling infrastructure.
The renewable fuels are produced from organic waste, such as used cooking oil or agri-food waste, thereby giving a second life to these types of residues. They are a quick and cost-efficient solution for the decarbonization of all transport sectors.
The production of 100% renewable fuels at the plant in Cartagena will avoid the emission of 900,000 tons of CO2 a year, since they reduce net emissions by 90% compared to the mineral fuel that they replace due to the lower carbon intensity of the former.
Repsol’s executive managing director of Industrial Transformation and Circular Economy, Juan Abascal, highlighted the milestone that the start of industrial-scale production of 100% renewable fuels represents for the company: “With this first plant on the Iberian Peninsula we are taking another step forward in our transformation towards decarbonization, with a cutting-edge technological project”.
The new plant will process 300,000 tons of organic waste a year - used cooking oil, among others - prioritizing residues of national and European origin. Repsol is certified under the ISCC-EU Voluntary Sustainability Scheme and the Spanish National Sustainability Verification System, ensuring traceability and the production of sustainable biofuels in accordance with Renewable Energy Directive (RED) standards.ENGIE obtained approval from the National Electricity Coordinator (CEN) to start commercial operation of BESS Coya, the largest battery energy storage system in Latin America to date. •

Innovative Liquid Flow Measurement Solutions
Titan is a leading design and manufacturer of innovative end user and OEM high-performance flow meters, used within a wide range of environments and applications.



• Compact, robust, reliable
• Excellent accuracy and repeatability
• Measure low to high flow ranges
• High chemical resistance
• OEM bespoke design capability

13
Ultrasonic
Turbine Flowmeters Oval Gear Flowmeters Instrumentation
Flowmeters
REQUEST A QUOTE TODAY +44 (0)1935 812790 sales@flowmeters.co.uk www.flowmeters.co.uk
Repsol and Bunge Create a Partnership in Spain to
Boost Supply of Renewable Fuels
• Through this strategic agreement, Repsol increases its access to the feedstock needed to reach its goal of producing up to 1.7 million tons of renewable fuels by 2027.
• The collaboration is another step forward in Bunge’s long-term strategy to create alternative paths towards the decarbonization of agricultural and oil supply chains.
Repsol and Bunge have agreed to partner in the development of new opportunities to help meet the growing demand for lower carbon intensity feedstocks for the production of renewable fuels. This alliance, the first of its kind in Europe, will help to accelerate the ramp-up of production of these fuels mandated by the European Union.
Through this strategic agreement, the multi-energy company Repsol acquires 40% of three industrial facilities that are part of Bunge Iberica, one of Bunge’s subsidiaries in the Iberian Peninsula, for a total amount of $300 million plus up to $40 million in contingent payments. The transaction is subject to customary closing conditions, including regulatory approvals.
Under this agreement, Bunge will continue to operate its three plants dedicated to the production of oils and biofuels in Bilbao, Barcelona, and Cartagena, near Repsol’s industrial complexes located in the same regions. Bunge will also continue to be a key producer of protein meals, vegetable oils and distributor of agricultural commodities in Spain.
Through the partnership, Repsol increases its access to a wide portfolio of low-carbon intensity feedstocks to produce renewable fuels, an immediate way to accelerate the reduction of emissions from transport, including cars, trucks, airplanes, and shipping.
Repsol’s current production capacity of 1.1 million tons of renewable fuels per year saves the CO2 emissions equivalent of more than 1.7 million electric vehicles. The company expects to increase its output by up to 55%, reaching 1.7 million tons in 2027. It is accelerating the rollout of renewable fuels at its service station network – the biggest in Spain – by adding pumps which supply with 100% renewable fuel. Currently, the company has more than 120 service stations with 100% renewable fuels, with the objective of reaching 600 by the end of the year and 1,900 by 2027.
Repsol is starting up its 250,000 tons-a-year advanced biofuels plant in Cartagena, Spain, the first of its kind in the Iberian Peninsula. The company is retrofitting another unit at its industrial complex in Puertollano, Spain, with a capacity to produce 200,000 tons of renewable fuel per year.
Under the partnership, the companies plan to explore other areas of cooperation and project development designed to increase the potential availability of non-food lipidic feedstocks for the renewable fuels market.
“With this agreement, Repsol has secured its leadership in renewable fuels in the Iberian Peninsula. It is clear proof of the
steadfast progress we are making in our ambitious roadmap to provide society with solutions to reduce the net emissions of CO2 from transport as quickly and efficiently as possible,” said Juan Abascal, Executive Managing Director for Industrial Transformation and Circular Economy at Repsol.
“This is an exciting step for Bunge in Spain and supports our commitment to create alternative paths towards the decarbonization of agricultural and oil supply chains in our industry. Together, thanks to our companies’ in-depth expertise in the agri-food sector and global connectivity for renewable feedstocks, we aim to unlock wider opportunities in the renewable energy space,” said Julio Garros, Co-President, Agribusiness at Bunge. •

Easy-Laser at APM in Singapore
Wewill be participating in the Asia Pacific Maritime (APM) exhibition, a leading maritime event in Singapore, scheduled for March 13–15, 2024.
At the exhibition, we will showcase our precision alignment tools designed to ensure the efficient operation and minimal wear of any type of rotating machinery onboard ships. Our alignment equipment is crucial for the installation and maintenance of propulsion systems, engines, and many other critical ship components.
By optimizing alignment, you can reduce energy consumption and extend the lifespan of components, which leads to fewer replacements. This, in turn, helps minimize the environmental impact associated with excessive fuel consumption and part failure.
We invite you to visit us at stand E-M01 to discuss your onboard alignment challenges! •


14
NEWS - EUROPE









North America’s Leading Event For Carbon Capture, Utilization & Storage www.ccus-expo.com FREE TO ATTEND REGISTER NOW Carbon Capture Technology Conference & Expo is dedicated to discussing the increasing role that Carbon Capture, Utilization & Storage (CCUS) will play in transition to a net-zero carbon economy. Leading experts from around the world will discuss the latest advances in new technology for carbon capture, storage and transport, as well as unique ways of utilizing CO2 to produce netzero fuels and for other manufacturing processes. 2023 WINNER Multi-Award Winning Show June 26-27 2024 NRG Center, Houston, Texas, USA 400+ EXHIBITORS 130,000Sq ft EXHIBITION SPACE 200+ SPEAKERS 8,000+ ATTENDEES 5 CONFERENCE TRACKS
Eni Welcomes UK Government’s Development Consent Order for HyNet CO₂ Pipeline
Eni welcomes the decision by the Secretary of State for the UK Government’s Department for Energy Security and Net Zero (DESNZ) to grant a Development Consent Order (DCO) for the HyNet North West CO2 pipeline. The DCO will allow the construction, operation, and maintenance of infrastructure to transport captured CO2 as part of the HyNet CCS cluster, where Eni is the transportation and storage operator.
The DCO is the first Anglo-Welsh cross border application for a Nationally Significant Infrastructure Project (NSIP) to be granted a DCO by DESNZ. It marks the completion of an 18-month determination process following Eni’s submission of the DCO application in October 2022. The DCO brings the HyNet CCS cluster closer to the execution phase, with FID expected by September 2024.
The UK Government’s decision to grant a DCO to the HyNet CO2 pipeline is an important milestone to allow for the world’s first asset-based regulated CCS business. A DCO is the consent required to authorise the development of any Nationally Significant Infrastructure Project (NSIP). The HyNet CO2 pipeline will transport carbon dioxide from capture plants across the North West of England and North Wales through new and repurposed infrastructure to safe and permanent storage in Eni’s depleted natural gas reservoirs, located under the seabed in Liverpool Bay.
Claudio Descalzi Eni CEO commented: “We see the UK as an attractive destination for Eni’s investments, particularly in the area of decarbonisation. We welcome the UK Government’s ambition to promote and develop the kind of groundbreaking projects we need to address climate change, especially within hard-to-abate sectors. Carbon Capture will play a critical role in meeting this challenge by safely eliminating emissions from industries that currently do not have equally efficient and effective solutions. This decision marks a significant step towards establishing a significant new industry for the country and consolidates the Eni’s leading position providing a service to decarbonise both its own and third parties’ industrial activities at a competitive cost and with a fast time to market. This position was further reinforced following our acquisition of Neptune Energy, which gives Eni access to three additional CO2 storage licences for a total gross storage capacity of about 1GT in the UK.”
Eni has established a leading position in the UK as HyNet’s CO2 transportation and storage operator. The Company also leads the Bacton Thames Net Zero project, which is looking to decarbonise the South East of England and Thames region. Eni has extensive experience in developing natural gas fields, operated over many decades, and will apply its know-how and skills to repurpose some of its existing assets into CO2 storage hubs, allowing the decarbonisation of its own, as well as third-parties’, industrial activities at a competitive cost.
Eni’s transportation and storage system at HyNet will have a capacity of 4.5 million tonnes of CO2 per year in the first phase, with the potential to increase to up to 10 million tonnes of CO2 per year after 2030 making HyNet a major contributor to the UK’s target of decarbonisation and CO2 storage. It will transform
one of the country’s most energy intensive industrial regions into one of the world’s first low-carbon industrial clusters. The project will help preserve local jobs by supporting the decarbonisation of hard-to-abate industries, as well as attracting investment and creating new jobs. •

Introducing Bore Alignment for Generation XT
Measure the straightness of bore center lines, bearing journals, and other cylindrical objects with the new EasyLaser® XT Bore alignment solutions.
The new bore alignment offer includes extension kits for the XT770 alignment system, a separate system for those who only perform bore alignment, and measurement software.
New XT app functionality
The Bore center program measures 3–50 points at each position (Multipoint) for highest accuracy. If required, you can set tolerances to align towards, which speeds up the work. The result can be displayed as raw data or best-fit calculated. Individual points can be re-measured at any time. Documentation with measurement data and photos is, as usual, provided with the XT Alignment app.*
More
power to XT770
With shaft alignment, flatness measurement and bore alignment combined into one package, you can now seamlessly handle all critical tasks for marine propulsion drive lines (motor, gearbox, propeller shaft, support bearings, stern tube) and rotating machinery installations, such as compressors. This ensures a versatile and cost-effective alignment solution.
These are the new XT bore alignment products:
• XT Bore bracket kit. This is an add-on kit for XT770, including a laser transmitter and brackets. The XT70-M measuring unit of your XT770 system is used as a detector. For bore diameters 130–500 mm [5.12–19.68”].
• XT Bore upgrade kit. Comes with the new wireless detector XT9 and brackets. Its compact size makes it possible to measure even smaller bores with diameters between 80–500 mm [3.15–19.68”].
• XT950 Bore alignment system. This is a complete system for those who only perform bore alignment. It includes all necessary brackets, detector XT9, and laser transmitter. Learn more

16 NEWS - EUROPE

Osbit’s Innovative Cable Test Rig Showcased at Flagship Launch

Cable installation equipment specialist Osbit showcased its ‘first-of-a-kind’ cable fatigue test rig at the high profile launch of Offshore Renewable Energy Catapult’s flagship National Floating Wind Innovation Centre today (Monday 18th March).
Humza Yousaf MSP, First Minister of Scotland joined 150 VIPs, dignitaries and offshore wind industry experts at the launch of the Offshore Renewable Energy (ORE) Catapult’s new Floating Wind Innovation Centre.
Osbit delivered and installed its cable test rig as part of a multi-million-pound project for ORE Catapult for its new floating offshore wind facility, which is set to accelerate the commercialisation of floating offshore wind projects.
The facility - a collaborative programme between the internationally recognised ORE Catapult, along with industry and academic partners – will fast-track floating offshore wind by providing world class testing facilities for R&D and certification of new technology.
The centre will not only accelerate the build-out of floating farms, but create opportunities for the UK supply chain, and drive innovations in manufacturing, installation, and Operations & Maintenance (O&M).
Osbit’s 60-tonne cable fatigue test rig is at the heart of the centre’s development, enabling ORE Catapult to offer globally leading cable testing capability to its customers, and maximising power cable reliability.
Responding to recently updated CIGRE TB862 industry requirements, Osbit has created a highly innovative design to carry out dynamic fatigue testing of subsea cables and bend stiffeners connected to offshore floating wind structures.
Osbit’s unique design provides a vast range of test capability and configurability allowing for adjustability for cable diameters and lengths, tensions and bend radii. The system is highly optimised for tension stability and simplified drive mechanisms for long machine life and efficient running.
The cable test rig was assembled and tested at Osbit’s Port of Blyth facility in Northumberland, England, prior to transportation and installation into the new centre in Aberdeen, Scotland this month.
The system is the second test rig Osbit has provided to ORE Catapult. The company previously delivered a state-of-the-art cable test rig to verify the performance and reliability of floating and tidal cables, for ORE Catapult’s Blyth facility, in 2018.
Osbit’s project with ORE Catapult is the latest in a string of contract deliveries for the company. These include twin wind turbine tower lifting tools to GE Vernova for use on the world’s largest offshore wind farm, Dogger Bank, and an upending hinge to offshore contractor Boskalis, to support key US and Scottish offshore wind projects. •
Building a Gas Plant in Voss
LABEntreprenør AS, a company within the AF Gruppen, has been selected as the contractor by BIR AS (Bergensområdets Interkommunale Renovasjonsselskap) for the construction and infrastructure of a new biogas plant in Voss. The contract is a turnkey project with an estimated value of approximately NOK 120 million (excluding VAT).
The facility, which will convert organic waste into biogas, will be located at Bjørkemoen in Voss. It comprises several buildings, technical infrastructure, and external tanks to accommodate the process plant, which will be delivered as a separate contract.
- We are very satisfied at being chosen as the contractor for this forward-looking project by BIR. The project adheres to various environmental requirements, including BREEAM certification, a fossil-free construction site, and specific material usage criteria. These challenges will contribute to the development of our organization, says Gard Kvalheim, CEO of LAB Entreprenør.
Construction work is scheduled to commence in early June 2024, with completion expected by December 2025.
The final contract is subject to approval by the BIR board. •


18 NEWS
Yinson Announces Private Placement of up to 120 Million Ordinary Shares to Support Energy Transition Businesses

Yinson has completed an accelerated book-building exercise, placing out 120,000,000 new ordinary shares, representing approximately 4.1% of the total number of issued shares (excluding treasury shares) of the Company, to a selected group of institutional investors. Putting this into perspective, Yinson raised RM283.2 million in proceeds from this energy transition placement exercise.
Kumpulan Wang Persaraan (Diperbadankan) [KWAP]
subscribed 50 million shares as the anchor investor supporting the transition placement. As a signatory to the UN Principles for Responsible Investment (UN PRI), KWAP’s commitment towards responsible investment practices underscores this mobilisation of capital.
The proceeds will primarily be used to expand Yinson’s renewables and green technology businesses. This move is expected to contribute positively to the Group’s earnings potential moving forward while further strengthening the Group’s equity and capital base. AmInvestment Bank has been appointed as the Adviser and Placement Agent for this exercise.
Commenting on the private placement, Yinson Group Chief Executive Officer Lim Chern Yuan said, “Prospects for our renewables and green technologies businesses have never been stronger, given the world’s critical need to strengthen global clean energy infrastructure to facilitate a just and equitable energy transition. Proceeds from this placement will enable us to accelerate our strategic plans for Yinson Renewables and Yinson GreenTech to capitalise on market opportunities, which we are confident will contribute to stronger, sustained returns over the long-term. We thank KWAP, as well as other valued institutional investors, for placing your trust in us.”
Hazman Hilmi Sallahuddin, Chief Investment Officer at KWAP commented, “We are proud to support Yinson’s energy transition endeavours as an anchor investor in this placement. •

Specialist Training for the Storage Tank Industry
Live online, classroom, blended, e-learning or in-house
• Gain or renew your 5-year Certificates of Competence*
• Courses based on EEMUA 159
• English, Dutch, German and French language options
• Select from courses throughout year, including:
TankAssessor courses*
20-23 May 2024 – in English
–classroom – London, UK
27-30 May 2024 – in English
–live online – Riyadh time
3-6 June 2024 – in Dutch
–classroom – Rotterdam, NL
10-13 June 2024 – in French
–classroom – Paris, FR
4-7 November 2024 – in German
–live online
Storage Tanks e-learning
On-demand – in English or Dutch
TankInspector courses*
16-18 September 2024 – in English
–live online – Houston time
23-25 September 2024 – in Dutch
–classroom – Rotterdam, NL
28-30 October 2024 – in English
–classroom – London, UK
TankBasics courses
16 September - 25 October 2024
–in English – blended learning (live online, e-learning, and more)
In-house courses
By arrangement for your choice of: time, language, location, or live online
Also... EEMUA Seminar – Engineering the Energy Transition 6 June 2024 – London, UK







More choices, information and registration at www.eemua.org and events@eemua.org
Above ground flat bottomed storage tanks A guide to inspection, maintenance and repair Publication 159 Edition5
Precision Flow Measurement Supports an EnergyEfficient Future
Precision liquid flow measurement supports innovation and diversification in the oil, gas and energy industries. The pressure towards sustainability is pushing the oil, gas and energy sectors to evolve innovative and diverse solutions in a move to create an energy efficient future.
Major transformations within the oil and gas industry in the form of adopting sustainable practices, developing new revenue streams and pushing the boundaries of technology, are being trialled and delivering success. Expanding into new areas such as renewable energy, advanced chemicals and biofuels, is driving innovation and diversification.
Titan Enterprises provides optimised and custom designed liquid flow measurement solutions for oil, petrochemical and green energy applications for OEM customers. These have included bespoke oval gear flow meters for marine fuel flow measurement, monitoring the volume of grease lubricating wind turbine bearing mechanisms, high pressure intrinsically safe units for offshore oil drilling additive injection, and for biodiesel plants converting bio waste into sustainable biofuels.
Monitoring
Grease Lubrication Flow in Wind Turbines
One of the fundamental requirements for ensuring reliable and efficient wind turbine operation is to keep the heavily loaded main bearings fully lubricated in all operating conditions. Fully IP65 / NEMA 4 compliant, Titan’s compact oval gear flowmeters are optimised for measuring the flow of viscous liquids. Designed to operate at pressures of up to 700 bar and temperatures up to 150°C, and with a standard flow range of 0.01 to 4.0 litres/min on 30Cstk oil, the OG1 or OG2 models can routinely achieve outstanding accuracy (0.75%) and repeatability (0.1%).
Optimum Flow Meter Accuracy Critical to Biofuel Production Titan’s Oval Gear (OG) flow meters are an intrinsic component within Green Fuels’ biodiesel plants converting bio waste into sustainable biofuels. Green Fuels’ award-winning research and pioneering process plants have powered buildings with sustainable fuel from used cooking oil, with ongoing development to convert fish oil and sewage sludge into biofuel. Simple, accurate and chemically resistant, Titan’s OG flow meters, with


the addition of the Namur switch, have proved the ideal solution for precise chemical dosing for Green Fuels’ biofuel plants within a potentially hazardous environment.
Adaptive Flow Measurement Designs for Petrochemical Applications
Titan Enterprises offer special options and adaptive designs of its Oval Gear (OG) flow sensors to meet specific high-pressure requirements, aid chemical compatibility, and ensure safe operation in potentially explosive atmospheres. Titan’s Oval Gear range include ATEX compliant IP65/NEMA 4 protection models, and devices that offer intrinsically safe options for processes that operate within harsh environmental conditions, such as explosive or corrosive atmospheres, where flowmeters are required to withstand tough environments whilst maintaining accurate and reliable measurement.
The pivotal role of oval gear flow meters lies in controlling precise liquid dosage for efficient and economical process operations. Within the petrochemical sector, a chemical injection system employs accurate low-flow measuring sensors to inject a precision dosage of chemicals required, including antifoaming scale inhibitors and methanol, into oil wells. Accurate chemical dosing is essential for the optimal functioning of the well system, promoting efficiency and heightened productivity without excessive costs. OG flowmeters are critical in preventing overdosing that can lead to unnecessary expenses, or underdosing that may trigger premature maintenance and suboptimal well performance.
For measuring high viscosity liquids like thick oils, bitumen and tar, precision-engineered flow meters are necessary. Titan’s standard OG flowmeters are designed to provide highly accurate flow measurement up to 1000 cSt. For viscosities above 1000 cSt, Titan provides High Viscosity OG options specially designed with profiled gears to facilitate additional flow of the liquid and prevent hydraulic lock.
Visit Titan Enterprises’ website for further information on flow measurement or to discuss specific OEM applications, please contact Titan Enterprises on +44 (0)1935 812790 or email: sales@flowmeters.co.uk. •

20
NEWS - EUROPE

Bridging Energy Access Gap Vital for Nigeria’s Economic Growth, Says NNPC Chief
The Nigerian National Petroleum Company Limited (NNPC Ltd) has emphasized the critical importance of bridging the energy access gap to the creation of economic prosperity of the country.
The Group Chief Executive Officer of NNPC Ltd, Mr. Mele Kyari, made this submission in a keynote address on industry operations with the theme, “Stability in the Energy Sector: Integrated Strategies for Infrastructure, Transportation and Security,” at the 2024 edition of Society of Petroleum Engineers Oloibiri Lecture Series and Energy Forum (SPE OLEF) held in Abuja, on Thursday.
To bridge the energy access gap in Nigeria, Kyari said NNPC Ltd was working on developing the right infrastructure to deliver oil and gas to drive prosperity for Nigerians.
“We are committed to developing gas infrastructure across the country,” Kyari stated, stressing that the company’s commitment was not just a statutory requirement of the Petroleum Industry Act, but a pledge to ensure energy security beyond fuel supply.
“We are dedicated to investing in critical infrastructure to enhance economic prosperity by supplying gas to the domestic market, targeting at least 8 billion cubic meters,” Kyari added.
He listed some of the infrastructural projects being undertaken by the NNPC Ltd to help bridge the energy access gap in Nigeria to include the Obiafu/Obrikom/Oben (OB3) and AjaokutaKaduna-Kano (AKK) pipelines, adding that they are designed to enhance the nation’s gas supply network.
On the global front, Kyari said NNPC Ltd was working on expanding gas supply to the international market primarily through the NLNG Train 7 project while efforts were also being made to kick off Train 8 as well as the various floating LNG initiatives.
Kyari called for support in leveraging Nigeria’s abundant gas resources for economic prosperity, emphasizing the need to bridge access gaps in electricity and clean cooking fuel.
He assured stakeholders and investors of the support of President Bola Ahmed Tinubu, whom he said is committed to the gas revolution. •
Immediate benefits for efficient, safe primary containment
From day one, Learners on the EEMUA MIPC® training build a unique workbook of mechanical integrity know how tailored to each Learner, site and company
EEMUA's MIPC course helps practitioner-level engineers to be where they are needed – on-site and on top of the latest industry developments and good practice in primary containment of hazardous substances, including for pressure systems.
Flexible, in-depth training for engineers on-site / on-call, EEMUA’s Mechanical Integrity Practitioner Certificate courses combine: live online classes; 1-1 sessions with expert Tutors; on-demand e-learning; and more – all enhanced by Mentor support and guidance throughout.
Covers: Inspection and Test Techniques; Asset Condition; Equipment Design Elements; Legislative Environment; Reporting; Risk and ALARP; Audit; User Responsibilities and Competencies; Postponement; Feedback; WSE; and more.
Adapts to engineering needs of each individual Learner, their company, and their site/s – via a 2-hour Induction...





Next MIPC course: Induction to fit work diaries from September 2024. Learning starts October 2024. Registration open now.


For details please contact EEMUA online-learning@eemua.org +44 (0)20 7488 0801
MIPC® shortlisted for the Best E-learning/ Online Education Initiative memcom membership excellence awards 2020 and 2022
www.eemua.org

Continuous Production Logging From Tracers.
Tracking fluid connections using tracer is a well-known technique across multiple science disciplines, including oceanography, hydrology, meteorology as well as in petroleum science. In most applications unique tracers are introduced at specific locations as a neat liquid or as a small pre-mixed batch of liquid containing the tracer substance. Once introduced, the tracer provides direct proof of mass transport from one location to another.
Whenthe amount introduced is known, sampling the produced tracer mass over time also provide information about the amount of flow in a system. This general tracer methodology was taken a significant step further in oil and gas applications by the invention of polymer tracer systems. In these systems the polymer acts as a deployment method and a source of tracer material over a time span of several years. In practice, specially designed polymer and tracer mixes are custom made and fitted into zonal completions, providing identification of flow from more than 50 different zones. Specific polymer tracer systems for oil, water and gas have been devised and have been deployed in more than 800 wells world-wide.
In addition to directly proving mass transport, tracers also provide flow rate information. Generally, this can be achieved either by comparing a continuously added tracer concentration to a sampled concentration or by measuring the time elapsed from injection to arrival of the tracer. For tracers deployed using polymer tracer systems, the latter method was introduced by (Nyhavn, 20101) and has since been used in numerous applications to quantify zonal inflow contribution in production wells. Briefly, whenever a quantification of inflow rates is desired, the well is shut for a short period of time, to allow accumulation of mass of individual tracer at the installation points. Upon

restart, the transient tracer signals are then characterized either by their decline or by the time of arrival of the signals.
When time of arrival of two tracer signals are compared and used together with information on volumes in the well-bore this gives a direct measurement of flow rate along the well-bore. On a fundamental level this methodology bears resemblance to the application of spinners used by a production logging tool (PLT) to estimate flow rate along the well-bore and hence provide a chemical PLT. Spinnerbased and chemical PLTs have ben compared

in a range of applications (Prosvirnov at al., 20162; Solovyev et al ., 20193; Zoshchenko at al ., 20184; Kolupaev et al. 20185; Shtun at al. 20176; Eviany 20237) and some interesting observations can be made from these studies. One obvious difference between chemical and spinner based PLTs is that the latter requires introduction of a tool into the well bore. The tracer systems are pre-installed, and no tool is required, hence any risk of a tool getting stuck is avoided. For this reason, a chemical PLT are often a preferred solution in the longest horizontal wells (Aljan et al 20238). In addition, during a chemical PLT sampling campaign, the flow is unrestricted whereas the presence of a tool in the well does introduce some restriction, that may impact the flow (Eviany 20237). Even if chemical PLTs have proven their usefulness, the requirement for a temporary shut-in and restart may pose challenges and has an economical impact, in the form of deferred production during the shut-in period. It has therefore been important to overcome these challenges and work towards providing measurement while production (MWP) from the tracer systems. Recently Resman reported significant breakthrough in MWP using tracers in the Eldfisk field in the greater Ekofisk area (Urdal et al. 20239). In the patented application, tracer pre-installed in the completions are displaced
22
EXPLORATION & PRODUCTION
in a controlled manner into the formations and provide continuous rate quantification for an extended period. One the appealing benefits of the MWP methodology is that no shut-in of the production is required. In every production sample the inflow contribution of oil and of water is available simply by interpreting the concentration data in that sample. Continued sampling of fluid from that well provides what can best be described as a PLT in every bottle. Continuous sampling over time thus provides a continuous stream of PLT data. This gives the opportunity to investigate the evolvement of production of hydrocarbon and water in all zones where tracer is installed.
As for all chemical PLTs, the MWP methodology also avoids any tools in the well. Additionally, as there is no need for a shut-in, the well is without crossflow or any other transient behaviour during or immediately after restart. This implies that the MWP using tracer systems provide information as the well is producing “naturally” without any observer effect. Changes occurring over time – such as influx of water can therefore allocated to single zones and remediated. In the greater Ekofisk Area example (Urdal et al. 20238) more than 20 production wells have been installed with Resman’s production tracer technology. Application of the MWP methodology is therefore possible across a number of wells, providing continuous zonal inflow rate contributions across all these wells for every sample. In total this provide a close to four dimensional PLT (4D-PLT) study for a field.
If you would like to know more about the topics discussed in this article, or learn more about their solutions, please contact RESMAN at: RESMAN AS https://www.resmanenergy.com contact@resmanenergy.com +47 91 67 13 33


1. Nyhavn, F. 2010. Extracting Well Inflow Rate Profiles from Transient Tracer Production Curves (in Norwegian). Norwegian Patent No. NO 342,835.
2. Prosvirnov, M. N., Kovalevich, A., Oftedal, G. et al. 2016. Dynamic Reservoir Characterization and Production Optimization by Integrating Intelligent Inflow Tracers and Pressure Transient Analysis in a Long Horizontal Well for the Ekofisk Field, Norwegian Continental Shelf. SPE Bergen One Day Seminar, Bergen, Norway, 20 April. SPE-180061.
3. Solovyev T., Soltanov D., Galimzyanov A., Naydenskiy K., Nukhaev M., Mukhametshin I.: “Successful Application of the Intelligent Inflow Tracers for Monitoring of Horizontal Wells on North Komsomolskoe Field”. SPE196831. SPE Russian Petroleum Technology

Figure 1. Figure adapted from Udal et al.8 displaying inflow tracer profiles for oil and water found using the MWP chemical PLT described in the text. A chemical PLT result is obtained in every sample bottle and gives an overview of the well performance over time. In the figure every line in the histogram correspond to one sample bottle taken over a period from 2019 to 2022. The letters in the figure corresponds to individual zonal oil and water tracer systems.
Conference, October 22–24, 2019
4. Zoshchenko O., Yury Trushin Y., Anton Aleshchenko A., Ilkam Mukhametshin I., Artem Galimzyanov A., Marat Nukhaev M.: “Novel Well Monitoring Technology Implementation for Multi-Zonal Well in Carbonate Kharyaga Oil Field”. SPE191556. SPE Russian Petroleum Technology Conference, October 15–17, 2018
5. Kolupaev D., Uchuev R., Bikkulov M., Matevosov M., Sheremeev A., Mukhametshin, Galimzyanov A., Nukhaev M.: ‘Selection of Optimum Monitoring Technique for Wells with Multistage Hydraulic Fracturing on Priobskoe Oilfiel’. SPE-191564. SPE Russian Petroleum Technology Conference, October 15–17, 2018
6. S. Y. Shtun, A. A. Senkov, O. I. Abramenko, V. V. Matsashik, I. R. Mukhametshin, A. V. Prusakov, M. T. Nukhaev: “The Comparison of Inflow Profiling Technologies for ERD Wells Including PLT, Fiber Optics DTS, Stationary Chemical Tracers: A Case Study from the Caspian offshore Yuri Korchagin Field in Russia”. SPE-188985. Annual Caspian Technical Conference and Exhibition, November 1–3, 2017
7. Eviany A., Mario C.C., Hakim A.L., Nugrahanto A., Pramana H., Murtani A.S., Rashed R., Koumouris S., Huseby O.: “A New Technology Approach Using Permanent Chemical Tracer for Water Source Identification in Ujung Pangkah Field”. SPE215343. SPE/IATMI Asia Pacific Oil & Gas Conference and Exhibition, October 10–12, 2023.
8. Alyan M, Parihar S, Al-Haji L, Leung E, Elder C, Othman A, Al-Tamimi A, Al-Harbi M, Al-Kiyoumi A, Wills J: “Novel Application of Inflow Tracers in Record Well for Assessing 1-MD Reservoir”. SPE-211403, ADIPEC, Abu Dhabi, UAE, October 2022.
9. Urdal J., Habib M.A., Mikalsen T., Chowdhury S., Cleveland K.O., Huseby O., Bergo C., Pride S.: “Application of Inflow Tracers to Complement Production Logs in a Carbonate Field”. SPE-214804-MS. SPE Annual Technical Conference and Exhibition, October 16–18, 2022

23
Innovative Pumping Solution by SEEPEX Revolutionizes Operations at Buzzard Oil Field
The Buzzard oil field, located about 100 kilometers northeast of Aberdeen, has been a central hub in the European oil and gas industry since its discovery in 2001. The field plays a pivotal role in the energy supply chain, contributing to the vast oil and gas network that sustains the region’s economic vitality. Despite its importance, the Buzzard field presented a unique challenge because of the presence of mercaptan in its crude oil, leading to a groundbreaking solution from SEEPEX that has transformed operations.
The Forties Main Oil Line, responsible for transporting 150,000 barrels of crude oil daily from the Buzzard oil field to the refinery of a global oil and energy company on the east coast of Scotland, has been a crucial artery in the European oil and gas infrastructure. However, the mercaptan content in the Buzzard field’s crude oil posed a major challenge for pipelines and discharge systems, particularly during maintenance. Mercaptan, also known as thiol, is not only a chemical compound but also a toxic substance with a distinctive and penetrating smell.
The project at Buzzard identified two critical challenges. Firstly, the maintenance of the main oil line required draining the crude oil, which contained up to 15% entrained gas. This created extreme process conditions with a low net positive suction head available (NPSHa) of 0.5m, making many conventional pump technologies unsuitable as they risked cavitation damage.

Above: SEEPEX range E pumps are semisubmersible progressive cavity pumps that empty barrels, pits, basins and containers. They are a cost-effective alternative to conventional pumping systems, especially in applications with critical suction heads or limited installation space.

NPSHa is a critical element defined by factors such as vapor pressure, density, system inlet pressure, geodetic level and loss level. Finding a pump with a low NPSHr (required) figure became imperative for overcoming this challenge. The second challenge required pumping a water-hydrocarbon solution from a 6m deep open drain tank, containing various hydrocarbons and water, to an oil/ water separation unit. The choice of pump was crucial to ensure that the pumping action would not emulsify the oil and affect the separation process.
SEEPEX, a leading provider of progressive cavity pumps and pump systems, approached these challenges with an innovative singlepump solution. The solution involved a vertically mounted BE pump installed in a can, designed to overcome the low NPSHa. SEEPEX’s engineers fitted two suction connections to the can, one linking to the main oil line and the other to the open drain tank. Individual isolation valves equipped both suction pipes, offering operational flexibility to either drain the main oil line or pump out the open drain tank.
One of the key advantages of the chosen progressive cavity pump was its low shear capabilities, preventing oil emulsification and ensuring the efficiency of the oil-water separation process. This feature proved crucial in handling shear-sensitive products with high gas fractions, characteristic of the Buzzard field’s crude oil. The pump, certified ATEX CE EX II 2G IIB T3 X, featured a 53B mechanical seal system to ensure product containment and prevent environmental leakage, considering the hazardous nature of the pumped hydrocarbon mixture.
Beyond the specific success at Buzzard, the SEEPEX BE CAN design pump is indicative of broader trends in the European oil and gas market, especially in the UK. The industry, with its rich history and technological advancements, constantly seeks innovative solutions to overcome challenges and optimize efficiency. SEEPEX’s ability to address unique challenges with a tailored, efficient, and long-lasting solution reflects the commitment to excellence in engineering, setting a benchmark for future endeavors.

The European oil and gas market, particularly in the UK, has witnessed dynamic shifts over the years. Focusing on sustainability, environmental consciousness and energy transition compels companies in this sector to adapt and innovate. The SEEPEX solution aligns with these industry trends, not only providing operational efficiency but also contributing to the overall sustainability goals. In the broader context of the European oil and gas industry, reducing investment costs and minimizing unplanned maintenance are paramount objectives. SEEPEX’s single-pump solution, handling two applications seamlessly, has resulted in reduced investment costs, highlighting the potential for substantial cost savings. This success story offers a valuable lesson for industry players seeking sustainable, efficient and cost-effective solutions.
In conclusion, the SEEPEX pumping solution at the Buzzard oil field stands as a testament to the innovative spirit driving advancements in the European oil and gas market. As the industry navigates the complexities of the modern energy landscape, solutions that address specific challenges while contributing to broader sustainability goals become increasingly vital. SEEPEX’s achievement at Buzzard exemplifies the capacity of engineering innovation to redefine operational standards and drive long-term success in the dynamic and evolving oil and gas sector. • If you would like to know more about how SEEPEX can help your company and its operations, please contact them at:
SEEPEX GmbH
W: https://www.seepex.com
T: +49 2041 9960
E: info@seepex.com
24
EXPLORATION & PRODUCTION
TO EXACTING STANDARDS API 676 PUMP


















The progressive cavity pump to fulfill your exacting requirements in Oil & Gas applications.
The BNA pump from SEEPEX ensures compliance with API 676 and API 682 while reducing costs in petrochemical applications.
YOUR BENEFITS
API 676 and API 682 compliant
Extremely robust design
High containment pressure and corrosion resistance
Simple integration into piping systems
Non-welded casing means reduced documentation and fewer inspections
Shorter lead time
High operational safety
Act now to experience the benefi ts of this API pump for yourself.
SEEPEX GmbH T +49 2041 996-0 www.seepex.com

Masfix, Keeping the Oil and Gas Customers in Stock of Their Fasteners and Consumables Through Sustainable Solutions and Experience in the Industry.
Based in Newcastle, UK on the banks of the River Tyne, a family-run business with an abundance of knowledge and experience to share with the oil and gas industry.
The Masfix roots were planted by Ron Slater and George Mordue in 1982, initially a duo with just one delivery vehicle, providing fixings and fasteners to local companies within a 15-mile radius. Today we are still very much a family business with sons, Mark Slater and Ian Mordue ensuring the continuation of their father’s legacy.
Now into our 42nd year of business, we have moved with the times and increased our offer to the North East manufacturing industry. With goals to become the largest independent fastenings distributor in the North East of England, offering over 40,000 individual SKUs we put our success down to the evolution of our product offering, diversifying to include tools, engineering consumables, hardware and PPE. All the necessities our oil and gas customers need.
Richard Ward, Sales Director stated: “We’re extremely passionate about the North East and want to support organisations throughout the region, although we’ve grown into a good size business, we’re still a small, family business at heart. We pride ourselves on the service we deliver to our customers. We introduced a new Kanban just-in-time stock management system to ensure our customers always have stock availability, without having to lift a finger.”


“Even our on-site vending machines are cloud-based, allowing for seamless stock control where our customers don’t have to do anything, and we handle it all for them.”
Richard continued: “95 percent of what we deliver is in our own vehicles and can be delivered next day. We’re always listening to customer demands and can adapt to suit their requirements, exactly like we did during the pandemic by going online.
We see our customers as partners. Our years of experience, vast product range and streamlined processes allow us to offer a service that is dedicated and satisfactory every time.”
Richard said: “Being based in the North East of England and having one of the biggest stock ranges of fixings & fastenings and engineering consumable products, allows us to be a one stop supply partner to the North East industry key players.
We supply to a wide range of small and large customers in the process sector, including robotics, gas and petrochemical, renewables,
automotive and everything in between.”
The benefits of a stock management solution are:
• Save money, by avoiding costly stock outs and downtime situations, reduce panic buying and one-off purchasing. Consolidate your supply chain and reduce admin procedures.
• Save time, eradicate lead times as stock can be managed to never run short. Strategically have your solution in the optimal location to reduce the time it takes to access parts. Minimises time taken on stock takes.
• Stock visibility, you can track low stock levels and identify the re-order points for each product, in turn avoiding the occurrence of stock-outs. Helps identify obsolescence and reduce the amount of stock required.
• Utilise data, Use the data provided to strategically plan your stock around future projects or fluctuations throughout the year. Get to understand
26
EXPLORATION & PRODUCTION

which department uses what and to what levels creating better business intelligence.
• Create Space, transform a disorganised work space into as streamlined operation through tailormade storage solutions. The space created can be utilised in more productive way.
Our Solutions are perfect for the oil and gas industry. Vending machines can be placed onsite to manage all consumable items from PPE to engineering tools. This allows 24/7 access, control operator access and is proven to reduce consumption. Our customers like the option of branding their vending machine which gives it a feel for the business it is placed within. The Kanban solution is very popular where we
supply all necessary racking, storage bins and labels. Both options are maintained by our fulfillment team where they do regular thorough checks to reduce the risks of errors occurring in stock numbers. Smart Store setups with RFID solutions are also something we can offer.
Our team will meet up and perform a site visit to assess the best solution for your business. Working with this information and date we will provide you with our recommended levels based on usage. We then get to work on setting up your solution. For our Kanban’s this includes unique bar-codes and bespoke labeling identifying the contents of the bin. For our Vending Machines this includes creating user access and permissions
along with product groups. Soon after we will arrange to install the solution on site with minimum fuss. You can then relax knowing your stock is being managed. We can provide reports and data on everything from usage down to the individual, cost savings and future trends.
With sustainability at the forefront of many businesses’ strategy plans, these solutions play an integral part in helping you reach these goals by reducing deliveries, packaging and waste.
With this in mind, we offer sustainable alternatives to your PPE and work-wear. We have partnered with brands like Globus, Rockfall, Uneek and Portwest to be able to offer our customers the best with no reduction in quality.

The future is exciting with plans to open a second site in Teesside, allowing us to replicate the thriving business we currently have in Newcastle. Although not too far away it will allow us to better serve our Teesside customers. We are always looking at ways we can improve our customer experience and by being close to all the great things going on in Teesside it was an easy decision for us. Already working with many Teesside businesses in various sectors, it will be great to be there on hand for all their needs.
If you would like to know more about our Vendor Managed Inventory or sustainable solutions for your business, please contact Masfix at: W: www.masfix.co.uk
E: sales@masfix.co.uk

27
+44
191 264 5333
T:
(0)

Powering Up Subsea Operations
In the ever-evolving realm of underwater technology, German firm SubCtech stands out with its innovative approach to ocean monitoring and subsea power solutions. Guided by the expertise of founder and CEO Stefan Marx, and COO Sören Johannsen, the company has carved out a significant niche in this highly specialised industry. Both are here talking about SubCtech’s pioneering products, the challenges of subsea engineering and the sustainability of modern subsea energy storage.
Based in Kiel, Germany, SubCtech has two primary business units – Ocean Monitoring and Ocean Power. The company began by manufacturing products to monitor seawater quality, and, over time, its focus evolved to meet the increasing demand for battery power underwater.
From its relatively small beginnings, crafting small underwater batteries, the firm now boasts a staggering 2 MWh battery storage system set to be in operational use from beginning in Q22024.
SubCtech’s Ocean Power unit manufactures subsea batteries that can be deployed aboard underwater vehicles – particularly unmanned vehicles – or as backups for oil & gas industry applications, offshore. To ensure its customers are comprehensively serviced, the Ocean Power unit is subdivided into three sectors: offshore energy, underwater vehicles, and standard subsea power products.
According to founder and CEO Stefan Marx, SubCtech’s Ocean Power unit offers both standard batteries and bespoke solutions: “We are able to offer solutions that fit into the customer’s available space and within its weight limitations – that’s where our roots lie, and that’s the service that has delivered our growth thus far.”
Record-breaking storage
The company’s engineering prowess was on full

display in late 2023, with SubCtech’s unveiling of the latest, greatest and biggest battery that it has ever produced: a jaw-dropping 2 MWh battery storage system.
The battery, which was produced to order for a client, is the first subsea MWh battery in the world. But it is also only one amongst many other batteries sold by SubCtech each year.
The company’s off-the-shelf battery solutions – that it calls ‘Big Jim’ and ‘Long John’, – are perennial best-sellers. Both battery units have standard physical dimensions and similar weights, but the innards can be customised

according to the customer’s specific requirements, including for both the capacity and voltage, both within set limitations.
For vehicle-based solutions, SubCtech offers three different standard battery housing diameters, namely 260mm, 310mm and 416mm internal diameter sizes, but. Bespoke sizes, energy, power and voltage ranges are meanwhile available on request.
Quality German engineering
SubCtech was founded in 2010 by current CEO Stefan Marx, who boasts over 30 years’ experience working in oceanrelated industries in various scientific and business roles. The company was originally headquartered in a small town near Kiel, but soon moved into Kiel proper, where its staff staff-count has gradually risen from 20 to 80, in order to accommodate growing demand for the company’s products.
Following several relocations around Kiel to accommodate its growing workforce and workload, SubCtech has put down roots via the construction of its own production space. Its new facility includes 1,300sqm of covered space and 1,500sqm of outdoor/storage areas. A move to a 4,000 sqm building is planned.
SubCtech’s products are qualified according to military standards, and all are certified by Det Norske Veritas (DNV), an internationally
28
EXPLORATION & PRODUCTION
accredited registrar and classification society headquartered in Norway. This DNV certification, which seeks to guarantee the safeguarding of life, property and the environment, ensures not only total peace of mind for users of the company’s products but crucially, it is also a legal qualification for any equipment fitted to the deck of a vessel. The importance of materials
SubCtech sources the highest-quality raw materials from around the world for the construction of its products. COO
Sören Johannsen highlighted highlights the reason that’s so important: “The steps from prototyping to operational use for any material and any product is a long process involving testing and certifications. There’s a big difference with the quality of materials used underwater and our task is to sell a fully qualified, 100 per cent cent-secure product.”
One of these materials is titanium, which is used for every battery’s pressure hull. The pressure hull and most of the battery’s internal components are manufactured at SubCtech.

“We build most of the components in-house, including the pressure vessel,” Mr Marx says. “We also develop and produce the battery management systems, hardware, software, testing, control systems and all battery components in-house. While we’d prefer to use existing products, so many components that our products need for deep-sea operations simply aren’t available on the market, and so we have to make them ourselves.”
The same applies to the company’s production machinery and even its testbed equipment, almost all of which had to be developed and built in-house since it simply didn’t exist to buy.
Perhaps mercifully, then, one of the most important components - – the lithium battery
cells themselves –- are sourced from wellknown producers with whom SubCtech has supply contracts.
Sustainable electric power
While rechargeable lithium-ion batteries have become commonplace in the daily lives of most consumers, it’s a relatively new technology where subsea operations are concerned. “It’s a big step forward for the subsea industry and it’s an important topic for us,” Mr Marx confirms. “Particularly in terms of the way in which it improves the sustainability of the industry.
“Firstly, because we’re replacing primary batteries with rechargeable batteries, and

secondly, because hydraulic systems are being replaced by battery-electric systems which have a design life of 25 years, so it’s very robust and that makes it very sustainable because clients don’t have to replace it frequently. Lowering CAPEX and OPEX costs is important – it’s beneficial to us, our customers and our partners, and ultimately it will lower energy prices.”
At the end of one of SubCtech’s battery lives, all of the components can be recycled. Customers can simply return the batteries to SubCtech, which then forwards them to specialist partners for recycling. Although they’re also fully recyclable, the titanium pressure hulls housing SubCtech’s batteries have an endless design life and are simply reused by the customer.
The recycling process must follow strict legal guidelines to ensure full transparency, as Mr Johannsen pointed points out: “The recycling is strictly regulated by German law, requiring that every item we recycle be documented so that the flow back to raw material is also documented.”
Concluding, Mr Marx highlighted highlights how the company’s best assets are driving it forward: “We’ve learned over the years that even as a medium-sized company, we’re able to move the world a little bit. Today, we have the best products with a great reputation and a high-quality team. In my 30 years in the industry, that’s the recipe for success.” •
If you would like to know more about how SubCtech can help your company and its operations, please contact them at:
SubCtech GmbH
W: https://www.subctech.com
T: + (49) 431-22039-880
E: info@subctech.com

29
ADNOC Announces First Production from Belbazem Offshore Block
Additional production capacity will help meet growing demand for Abu Dhabi’s lower-carbon intensity oil and gas
Belbazem is operated by a joint venture between ADNOC and CNPC and is maximizing value by leveraging operational synergies, AI and digital technologies
ADNOC announced today the start of crude oil production from its Belbazem offshore block, underscoring the company’s commitment to responsibly meet the world’s growing demand for energy.
The Belbazem offshore block is operated by Al Yasat Petroleum, a joint venture between ADNOC and China National Petroleum Corporation (CNPC). ADNOC’s innovative approach in developing the block includes leveraging operational synergies with adjacent fields, artificial intelligence (AI) and digitalization to enhance efficiency and safety while reducing emissions and cost.
Abdulmunim Saif Al Kindy, ADNOC Upstream Executive Director, said: “The start of crude oil production from the Belbazem offshore block is testament to the success of our strategic partnership with CNPC and the robust bilateral energy relationship between the UAE and China. ADNOC continues to maximize value from Abu Dhabi’s resources, while reducing our carbon footprint to ensure a secure, reliable,



and responsible supply of energy to customers locally and internationally.”
Production capacity at the Belbazem offshore block is set to progressively ramp up to 45,000 barrels per day (bpd) of light crude and 27 million standard cubic feet per day (mmscfd) of associated gas, contributing to ADNOC’s target of reaching 5 million bpd by 2027 and enabling UAE gas self-sufficiency for the UAE.
Al Yasat is pioneering the implementation of AI modelling and analysis tools across its offshore concession area. The Belbazem block uses WellInsight, an AI tool developed by AIQ, to analyze reservoir data and manage operations for enhanced safety and performance. The block will also integrate advanced technologies already deployed at Al Yasat’s Bu Haseer offshore field, to optimize production and reservoir management.
The Belbazem block is leveraging operational synergies by utilizing the facilities of Satah Al Razboot (SARB), an offshore field operated by ADNOC Offshore, resulting in cost savings and reduced environmental impact. Located 120 kilometers northwest of Abu Dhabi city, the Belbazem Block consists of three offshore fields; Belbazem, Umm Al Salsal and Umm Al Dholou. •
30
EXPLORATION & PRODUCTION
Denmark: TotalEnergies Restarts Gas Production at the Tyra Offshore Hub after a Major Redevelopment
Paris/Copenhagen, TotalEnergies announces the restart of production from the Tyra hub in the Danish North Sea, after the completion of a major redevelopment project of this hub. At plateau, the Tyra hub will produce 5.7 million cubic meters of gas and 22,000 barrels of condensate per day, once again making Denmark self-sufficient and a net exporter of natural gas. TotalEnergies operates the Tyra field on behalf of Danish Underground Consortium, a partnership between TotalEnergies (43.2%), BlueNord (36.8%) and Nordsøfonden (20%).
“We are pleased to restart the Tyra hub, one of the most technologically advanced offshore gas installations in the world. The success of this major redevelopment project owes a lot to the commitment of our teams, our partners and our contractors. The new Tyra leverages state-of-the-art digital solutions and technological innovations to produce more efficiently and with 30% lower greenhouse gas emissions than the former facilities”, said Nicolas Terraz President, Exploration & Production at TotalEnergies. “Importantly, the resumption of gas production from Tyra improves Europe’s security of supply.”
Discovered in 1968 by Maersk Oil, Tyra is located 225 kilometres west of the coast of Esbjerg. In September 2019, gas production was suspended to enable the redevelopment of Tyra. Following the decommissioning of the previous Tyra facilities, 8 new platform topsides, 2 jackets and 6 bridges were installed. As part






of this redevelopment project, 98.5% of the materials recovered from the retired installations have been reused or recycled.
Gas from the Tyra hub is delivered to Europe through two export pipelines to Nybro in Denmark and Den Helder in the Netherlands. •





Titan’s flow meters are:






Titan Enterprises is a leading design and manufacturer of innovative end user and OEM high-performance flow measurement solutions.
• Designed and manufactured to ISO 9001 with traceable calibrations.
• Robust and reliable delivering high accuracy and repeatability.
• Capable of measuring a wide range of liquid flows.
• Ideal for use in a variety of environments, temperature & pressure ranges, and chemical compatibility.
Titan’s flow meter and instrument range includes:
• Ultrasonic Atrato® and Metraflow® flow meters
• Low cost turbine flow meters
• Oval gear flow meters
• NSF-approved mini turbine flow meters
• OEM bespoke design
















To discuss your specific flow meter applications, contact us today: T: +44 (0)1935 812790 E: sales@flowmeters.co.uk W: www.flowmeters.co.uk










Breakthrough flowmeter technology
U.S. Coast Guard, BSEE and BOEM Sign Agreement to Advance Safe and Environmentally Sustainable Energy Development
To strengthen interagency cooperation in the advancement of safe and environmentally sustainable non-mineral (renewable) energy development, including offshore wind, on the Outer Continental Shelf (OCS), the U.S. Coast Guard (USCG) signed a Memorandum of Understanding (MOU) today with two Department of the Interior bureaus: the Bureau of Safety and Environmental Enforcement (BSEE) and the Bureau of Ocean Energy Management (BOEM). U.S. Coast Guard Deputy Commandant for Operations Vice Admiral Peter Gautier, BSEE Director Kevin Sligh and BOEM Deputy Director Dr. Walter Cruickshank signed the MOU during a ceremony at the USCG Headquarters in Washington, D.C.
The new agreement strengthens federal collaboration in support of the Biden-Harris administration’s priority to deploy clean energy to combat the global climate crisis. USCG, BSEE and BOEM share responsibilities for the planning, siting, construction, operation, maintenance and decommissioning of federal offshore non-mineral energy facilities. The memorandum will serve as a guide for coordination of respective roles for offshore safety and environmental protection in federal waters, and outlines agency leadership for specific oversight functions.
“I’m signing this historic MOU today to memorialize the partnership between the Coast Guard, BSEE, and BOEM. Our cooperation is vital to be prepared for the rapid growth in offshore activity supporting sustainable energy development. Together we will ensure that this activity will be safe, secure, and environmentally sound,” said Admiral Gautier.
“BSEE is committed to high standards for worker safety and environmental compliance during all offshore energy activities,” said BSEE Director Sligh. “The agreement signed today strengthens interagency communication and coordination, reduces gaps and redundancies in federal oversight, and helps us to leverage resources and expertise, all in the service of a mutual mission to provide for the safe and environmentally conscientious development of offshore renewable energy resources.”
“Government partnerships are essential for ensuring offshore renewable energy development is done efficiently and responsibly,” said BOEM Director Elizabeth Klein. “The agreement signed today focuses on enhancing interagency communication and coordination and leveraging institutional knowledge. Our agencies’ collective efforts can provide additional impetus to the advancement of offshore wind energy development for the benefit of all Americans.”
The MOU calls for USCG, BSEE and BOEM to:
• Coordinate on regulatory and policy development to promote consistency of regulations and policies where shared responsibilities exist.
• Strengthen communication and cooperation through information sharing, collaboration, synchronizing of information, and adoption of similar terminology, codes and standards, for clarity and consistency.
• Exchange services and personnel to support mutual work objectives when possible, allowing the agencies to leverage resources and expertise. The MOU does not obligate funds or staffing.
• Develop and implement additional Memoranda of Agreement under the MOU to provide specific guidance on each agency’s role and shared responsibilities for regulating various OCS activities and facilities. The MOU signed today replaces a previous agreement signed in 2011 by the USCG and the Bureau of Ocean Energy Management, Regulation and Enforcement, the predecessor agency to BOEM and BSEE.
The mission of the USCG on the Outer Continental Shelf is to ensure maritime safety, security, and environmental protection.
The mission of BSEE is to promote safety, protect the environment, and conserve resources offshore through vigorous regulatory oversight and enforcement of ocean energy, marine mineral, and carbon sequestration activities on the OCS.
The mission of BOEM is to manage development of U.S. Outer Continental Shelf energy, mineral, and geological resources in an environmentally and economically responsible way.
To address the climate challenges now and into the future, USCG, BSEE and BOEM support the Biden-Harris administration’s goals to deploy 30 gigawatts of offshore wind energy capacity by 2030 and 15 gigawatts of floating offshore wind energy capacity by 2035. •
Toray Plastics (America) Offers Torayfan® Polypropylene Film Made with Certified-Circular Resins
Toray Plastics (America), Inc., announces it is leveraging ExxonMobil’s Exxtend™ technology for advanced recycling and now offers its customers and partners its Torayfan® polypropylene film made with certified-circular resins. Toray’s decision to purchase ExxonMobil’s certified-circular resin helps the packaging industry move closer to a circular plastic economy.
“Choosing certified-circular resins for our Torayfan films is another important step in demonstrating our commitment to plastic circularity and delivering more value to our customers,” says Chris Nothnagle, Senior Director of New Business Development at Toray. “First, plastic is diverted from a landfill. Second, the mass balance accounting approach ensures that the plastic waste the manufacturer processes is accounted for as the certified-circular resin it sells. Toray fully supports ExxonMobil’s endeavor for a verifiable solution to help capture value from plastic waste.” •

32 NEWS - NORTH AMERICA
Stepan to Announce First Quarter 2024 Results Soon
NORTHBROOK, Ill., Stepan Company will issue its first quarter 2024 earnings results on Tuesday, April 30, 2024 at approximately 7:00 a.m. ET (6:00 a.m. CT). Supporting slides will be posted at approximately the same time on the Investors/ Presentations page at www.stepan.com. The Company will hold a conference call to discuss and answer questions about its financial and operational performance on the same day at 8:00 a.m. ET (7:00 a.m. CT).
The call will be hosted by Scott R. Behrens, President and Chief Executive Officer, and Luis E. Rojo, Vice President and Chief Financial Officer.
The call can be accessed by phone and webcast. To access the call by phone, please click on this Registration Link, complete the form and you will be provided with dial in details and a PIN. To avoid delays, we encourage participants to dial into the conference call ten minutes ahead of the scheduled start time. The webcast can be accessed through the Investors/Conference Calls page at www.stepan.com. A webcast replay of the conference call will be available at the same location shortly after the call. •
Chevron Announces its First Solar-To-Hydrogen Production Project in California’s Central Valley
San Ramon, Calif., Chevron New Energies, a division of Chevron U.S.A. Inc., announced it is developing a 5-megawatt hydrogen production project in California’s Central Valley.
The project aims to create lower carbon energy by utilizing solar power, land, and non-potable produced water from Chevron’s existing assets at the Lost Hills Oil Field in Kern County. This low carbon intensity (LCI) electrolytic hydrogen will be produced through electrolysis, which is the process of using electricity to split water into hydrogen and oxygen.
Chevron’s strategy is to leverage our strengths to safely deliver lower carbon energy to a growing world. Chevron believes in the value of delivering large-scale hydrogen solutions that support a lower carbon world. The facility is designed to produce two tons of LCI hydrogen per day, with the goal of supporting an expanding hydrogen refueling network.
“Hydrogen can play a vital role in our journey toward a lower carbon future,” said Austin Knight, vice president for hydrogen at Chevron New Energies. “Chevron already offers lower carbon fuels like sustainable aviation fuel, renewable diesel and others, and this project is expected to expand the portfolio of solutions Chevron could supply to the region. •

Omnetics specializes in application-specific connector to cable systems. Our expert designers have experience designing harnesses for complex and harsh environment applications. Omnetics designers have the necessary experience needed to meet the Quality and Performance specifications required by the US Military, NASA and ESA.
We design and manufacture a wide range of custom cable solutions to support all of our various product lines, while allowing your team to guide the design.
Omnetics Connector Corporation follows IPC/WHMA-A-620 for all cable assembly, test and inspection practices.
www.omnetics.com | sales@omnetics.com
Seadrill Announces Fourth Quarter and Full Year 2023 Earnings Release and Conference Call
Seadrill Limited (“Seadrill” or the “Company”) (NYSE & OSE: SDRL) will report its fourth quarter and full year 2023 results on Wednesday, February 28, 2024 after the NYSE closes for trading.
The Company will host a conference call to discuss its results on Thursday, February 29, 2024 at 09:00 CST / 16:00 CET. Interested participants may join the call by dialing +1 (888) 660-6819 (Passcode: 7310670) at least 15 minutes prior to the scheduled start time. The Company will also webcast the call live on its website, www.seadrill.com/investors, where a replay will be available afterwards. •
New Technology for Gas Pipeline Repairs Slashes Carbon Emissions By 95%

Innovative
new technology to isolate gas pipelines in need of repair or maintenance has shown to prevent gas leakages and cut carbon dioxide emissions by 95%.
National Gas, which owns and operates over 7,600km of gas pipelines underground, has successfully adopted new technology used to repair pipelines with STATS Group’s Remote Tecno Plug® (RTP) in a recent project near St Cyrus in Scotland. The RTP was trialled to reduce the emissions released during pipeline isolation, a crucial process used by operators to stop gas from leaking while they perform upgrades and maintenance on the pipes. Usually, this is done through reducing the volume of gas in the pipeline by a process called recompression and then venting the remaining gas to atmosphere. The efficient use of the RTP allows the work to be undertaken more quickly, with zero leaks during operations, improving safety and overall discharge of greenhouse gases significantly reduced.
Project managers estimated that traditional venting techniques would have emitted 233 tonnes of gas. However, the RTP reduced emissions to 9.5 tonnes, saving gas released into the atmosphere, but also resulting in significant cost savings of over £100,000 of gas not wasted.
This success has prompted National Gas to formalise a policy encouraging the use of this technology in future isolation projects across the UK – with potential for these tools to be adopted by the individual gas distribution networks across the UK in future.
The UK has a legal obligation to reach net zero emissions by 2050 to address climate change, but gas is still integral to the UK, keeping the lights on and industries fuelled. It’s also important for the country’s energy security, making it resilient to demand spikes or pressures on the system. The gas industry is working to ensure energy demand continues to be met, while making improvements where possible to help reach climate targets –including the implementation of new technology like the RTP.
STATS’ RTP technology successfully sealed a 56-km-long, 48inch pipeline, ensuring a leak-proof and fail-safe isolation. It maintained full pressurization at 55 bars in the initial use of RTP on the National Transmission System, which surpasses traditional methods like venting or recompression. The technology offered secure double blocking and monitored isolation, allowing safe and efficient maintenance activities, such as welding. •
ConocoPhillips Announces Winners of 2023 Supplier Recognition Award Program
ConocoPhillips today announced the winners of its 2023 Supplier Recognition Award program. The 2023 recipient companies were honored for exhibiting exceptional leadership in observance of the ConocoPhillips SPIRIT Values.
Suppliers were recognized for two distinctions: focus on execution and doing business better. The ConocoPhillips global business units generated nominations internally, with winners carefully selected by a cross-functional committee of senior managers.
“We rely on our suppliers to help us deliver continued value for ConocoPhillips and our stakeholders in a reliable, efficient and sustainable manner,” said Colin Stevenson, chief procurement officer. “These award recipients have gone above and beyond to demonstrate exceptional leadership and innovation, and we embrace the opportunity to recognize them.”
The 2023 award recipients are:
• Doing Business Better: Corva AI, LLC (Global Wells)
• Doing Business Better: Gesch Contracting, Inc. (Lower 48)
• Doing Business Better: Greenfern Dynamics Pty Ltd (Australia)
• Doing Business Better: Intero Integrity Services Canada Inc (Canada)
• Doing Business Better: Stream-Flo USA LLC (Alaska)
• Execution: Aker Solutions (Norway)
• Execution: Double EE Service, Inc. (Lower 48)
• Execution: Enermech Pty Limited (Australia)
• Execution: Halfway River Horizon North (Canada)
• Execution: Halliburton AS (Norway)
• Execution: Infinity Operators, LLC (Lower 48)
• Execution: Process Equipment & Service Company, Inc. (Lower 48)
• Execution: SwabPro (Lower 48)
• Execution: Veolia Environmental Services (Australia) Pty Ltd (Australia)

34 NEWS - NORTH AMERICA





WE PROTECT ASSETS Exhibiting at TIB Chemicals AG +49 621 8901-0 protegol@tib-chemicals.com www.tib-chemicals.com PROTEGOL® COATING SYSTEMS HALL 4 / C30

Enhancing Safety and Efficiency
Gas detection systems during shutdowns and the tracking and maintenance of your fleet.
The management of safety hazards is of paramount importance in industries where harmful gases are present. Shutdown or turnaround periods in industrial operations provide a crucial opportunity to assess, inspect, and maintain facilities. Gas detection systems are vital tools for ensuring safety and preventing potential accidents during these periods.
One common issue during shutdowns is the loss of portable gas detectors. Comprehensive fleet monitoring is essential to maintaining a safe work environment, ensuring the safety of workers, and preventing hazardous incidents. In this article, we will delve into the significance and benefits of gas detection systems during shutdowns and best practices for monitoring your fleet of portable gas detectors during a shutdown.
Benefits of gas detection
1. Early detection of hazardous gaseous leaks: Gas detection systems play a critical role in identifying the presence of hazardous gases that could pose risks to workers, equipment, and the environment. During a shutdown or turnaround, when various equipment is inspected or maintained, there is a likelihood of accidental leaks or the release of toxic gases due to system malfunctions or human error. By continuously monitoring the ambient air, gas detection systems can quickly detect the presence of harmful gases, triggering alarms and allowing for prompt response and evacuation, if necessary.
2. Ensuring occupational safety:
The safety of workers is of primary concern during shutdown or turnaround activities. Gas detection systems provide real-time monitoring
of the environment, providing workers and management with accurate data on gas concentrations. By identifying and alerting to dangerous gases, these systems help prevent incidents, protect worker health, and alleviate the risk of long-term exposure to harmful substances. Incorporating gas detection systems as a part of a comprehensive safety protocol ensures compliance with safety standards, enabling industries to create a safe work environment for employees.
3. Preventing equipment damage and losses: Leaks or abnormal gas concentrations can damage site systems and equipment infrastructure. With gas detection systems in place, early leak detection allows for timely interventions to mitigate further damages. Preventing gas accumulation or prolonged exposure significantly reduces the risk of explosions, fire, corrosion, or equipment failure. Detecting leaks early on by using portable and fixed systems helps reduce repair costs, extend the life cycle of vital infrastructure, and keep employees safe.
4. Compliance with regulatory standards: Industries are subject to stringent regulations regarding safety and gas emissions. Companies must adhere to various standards and regulations set forth by governmental or industry-specific bodies, such as


OSHA (Occupational Safety and Health Administration) or the EPA (Environmental Protection Agency). Gas detection systems play a crucial role in ensuring compliance with these regulations. By continuously monitoring gas concentrations and emissions, companies can demonstrate their commitment to environmental preservation and the wellbeing of their workers.
5. Improved operational efficiency: Utilizing gas detection systems during a shutdown or turnaround enables efficient workflow. By detecting leaks and malfunctions promptly, maintenance personnel can address potential issues quickly, minimizing downtime. Additionally, real-time monitoring and comprehensive data analysis provided by these systems empower organizations to optimize maintenance schedules, allocate resources more effectively, and reduce downtime associated with troubleshooting and investigations.
The consequences of losing portable gas detectors
The loss of portable gas detectors poses severe
36
MIDSTREAM & PIPELINES
consequences to the safety of personnel and the overall success of a shutdown. These devices are necessary to detect hazardous gases that could lead to accidents, injury, or even loss of life. Furthermore, a failed gas detection system can lead to production delays, financial losses, and regulatory non-compliance. Therefore, organizations must implement effective fleet monitoring strategies.
Best practices for fleet management
1. Pre-shutdown inventory:
Before commencing a shutdown, conduct a comprehensive inventory of all portable gas detectors. Identify the number of devices, conditions, and upcoming maintenance or calibration requirements. This ensures you accurately understand your fleet’s status and highlights potential shortcomings in advance.
2. Track and monitor:
Implement a centralized system to track and monitor the location and condition of each portable gas detector. Utilize technology, such as NFC or tagging, to keep an up-to-date record of the devices. This helps ensure accountability and enables immediate action in cases of loss or malfunction.
3. Regular inspections and maintenance:
Perform routine inspections and maintenance on all gas detectors to ensure proper functioning. Implement a consistent schedule for battery checks, sensor calibrations, and firmware updates. This proactive approach significantly reduces the risk of device failure during the shutdown period.
4. Risk assessment:
Conduct a comprehensive risk assessment of the shutdown environment to determine the potential gas hazards. Use this assessment to develop a gas detection plan that considers the required location and number of detectors based on the nature of the hazards present.
5. Security measures:
Implement appropriate security measures to prevent the theft or loss of gas detectors. These may include improved access control, surveillance systems, and assigning designated

personnel responsible for tracking and secure storage of the devices.
6. Training and education:
Ensure that all personnel involved in the shutdown are well-trained in properly using, handling, and maintaining portable gas detectors. Provide regular training sessions to educate workers on emergency response procedures and the importance of gas detection during shutdowns.
Your solutions
At WatchGas, we always have the right solution for your application. Whether you need portable or fixed, single gas or multigas. Please look at our compatible products or contact us directly at info@watchgas.com.
SST1 for Contractors
The SST1 single gas detector provides up to three years of maintenance-free operation. Its simple design makes it perfect for users looking for ultimate protection while being easy to use, durable, and cost-effective.
• Easy to use and limited training.
• 0-500PPM H2S levels.
• TWA & STEL alarms.
• NFC and WatchGas application.
• 3-year battery life based on alarms.
• Serviceable Battery and sensors.

• Solid Polymer Sensor Design.
• Largest LCD in its class.
• External filters.
SST4 Range
SST4 Diffusion covers CO/H2S/O2 and LEL, making it perfect for general use on-site. NFC is standard, with induction charging and a wide range of options for whatever the application.
SST-Pump is a pumped four-gas device designed for sampling confined spaces, silos, and pre-entry checks.
Coupled with WatchGas accessories, this makes pre-entry checks quick and easy.
SST Kiosk for Fleet Management
The WatchGas Compliance Kiosk works as a terminal to allow the user to check in the gas detector, providing a complete overview of the device status and any unforeseen events. The WatchGas compliance Kiosk automatically sends all data to a designated software site. This gives a cost-effective overview of fleet health, predictive maintenance, events, and alarms.
• Configuration verification.
• Health check.
• Action confirmation.
• Multiple mounting options.
SST Dock for Bump Testing
The SST Dock is an automated test station that allows Bump and Calibration testing and is compatible with the entire SST Range in one module. It can be connected via Wi-Fi, BLE, or Cellular, allowing for desk, wall, and hard case mounted, depending on your application.
• Easy setup;
• Rapid bump;
• Connectivity;
• Platform design;
• Low gas notification;
• Mounting options.
If you would like to know more about the topics discussed in this article, please contact WatchGas at:
WatchGas
W: https://www.watchgas.com
E: info@watchgas.com
T: +31 85 018 7709

37
WatchGas: Enhancing safety and efficiency.

TDBR Performs Cargo Tank Inspection on FPSO, Gets Surveyor Approval On-The-Spot
TDBR has performed visual inspection on a large FPSO offshore of Brazil, using the Scout 137 Drone System from ScoutDI. This being a large unit, the tethered solution of the ScoutDI drone becomes indispensable with its unlimited flight-time.
The job was to inspect deck transversals, nine in total, and the timing was communicated as “urgent” for getting the unit back into operation. The job was completed within a 2-hour time frame with the Scout 137 Drone System. A class society surveyor witnessed the inspection and immediately credited the tank afterwards.
Safety benefits
For a large and tall unit like this, it is of particular importance to avoid the need for humans working at height. A team of two is sufficient to bring the equipment in and out of the asset and perform the inspection, reducing human exposure to the conditions in the tank tremendously.
Operational benefits and efficiency improvements
The Scout 137 Drone System has several advantages that benefit this type of job:
• BVLOS inspection support by design means a larger part of the volume can be inspected without moving equipment and personnel around.
• Unlimited flight time means that the crew does not need to interrupt the inspection job to change batteries. This provides extra advantages for reducing stress, organizing the job and finishing sooner.
In this case, the team completed the tank inspection in less than two hours with a minimum of moving.
Benefits to job completion and approval
A class society surveyor was present during the inspection, watching everything. Pleased with how the inspection was done, and how the system allowed him to confirm everything live on site, the surveyor credited the tank on the spot, immediately after the job was done.
About TDBR
TDBR is a widely known inspection service

company, founded in 2017 and focusing on the energy market. They were the first company in Brazil to perform visual inspection of an FPSO using a drone.
TDBR is RIT-certified for class survey inspection with drones, by class societies ABS, BV, DNV, Lloyds Register and ClassNK .
Description of the drone inspection
The inspection target in this case was a large FPSO situated offshore Brazil. The call for the job was urgent and following other partial inspections. The customer, one of the world’s largest operators, had the unit ready to go back into operation and needed the final approval.
The main purpose of the job was visual inspection of 9 deck transversals and adjacent structures. With heights close to 30m, it would be a particularly dangerous situation for rope access technicians. This vessel being only a few years old, the tanks were relatively clean.
TDBR entered the vessel with a two-man crew to commence drone inspection from the morning and onwards, doing GVI and CVI in order.
To increase efficiency, the first half of the job was done from the first stringer level. For the second half, the drone crew moved down to the tank floor and did the remaining half from there. The inspection was not entirely BVLOS, but for large parts of the job the drone would temporarily be out of sight or hidden behind or under stringer levels or other structures.
Relying on the 3D Lidar point cloud, live video feed, Mini-Map and on-screen telemetry of the Scout App, the TDBR crew are comfortable flying the Scout 137 Drone System without line-of-sight.
“Having the Mini-Map makes my life so much easier.” Marcio Belleti, Chief Pilot of TDBR.
Spatial awareness
“For me as a pilot, I just love the MiniMap feature of the Scout App”, says Marcio Belleti, chief pilot of TDBR. “We can select the working distance, fly really close to the deck transverse and just know it won’t crash with anything”.
The Mini-Map of the Scout App serves as a

great spatial aid to the pilot, whether flying BVLOS or not. The point cloud can be zoomed and panned and provides an excellent aid both to get an overview of the volume and an idea of your drone’s position. But the Mini-Map shows at a glance the distance from the drone’s virtual anti-collision bubble to the nearest obstacles.
Detected obstacles are shown in the MiniMap as white dots. As soon as the brown ring touches a white dot, the drone will move no further in that direction. The diameter of this virtual sphere can be set to one of two working distances, one for close inspection and one for “transport”. The anti-collision system can also be switched completely off, which is useful if you need to squeeze through narrow passages or perform contact operations, as shown below.
The Mini-Map is a very good add-on to the point cloud, allowing you to understand immediately what’s going on in the vicinity of the drone. Also keeping an eye on the distances up and down to nearest obstacle provides excellent support while flying.
“Having the Mini-Map makes my life so much easier, I always look at the Mini-Map circle in the Scout App and rely on that”, confirms Marcio Belleti. “And once you understand how the vertical lasers work, they are really good too”.
Inspection and approval in two hours
The FPSO operator ordering this urgent inspection had appointed a class surveyor from American Bureau of Shipping (ABS)
38
MIDSTREAM & PIPELINES
Above: Typical mid-size FPSO, not the one from this case study.
Below: The tethered design of the Scout 137 Drone System provides unlimited flight-time. Perfect for inspecting large volumes, like an FPSO.

a pillar is seen to the right at <1m away.
to join the inspection job. The surveyor joined the drone inspection crew, watching the job together with the pilot.
Working side by side with the surveyor, the inspection crew was able to finish the job within a two-hour window. Having witnessed the inspection in its entirety and assessing the structures with the drone crew, the surveyor felt confident to credit the vessel on the spot, clearing it for operation immediately.
“We always report with a PDF with Scout Portal links in it and provide the client access to the Scout Portal”. But in many cases, when a confirmation of status is sufficient for the client to move on, it is fine to do the approval on the spot and keep the Scout Portal material for reports and archiving.
Conclusion
The team from TDBR performed visual inspection of nine deck transversals of this large FPSO unit within two hours. Thanks to the tight and keen follow-up from the surveyor, the vessel
was credited on the spot.
The inspection crew remained safe on stringer levels and tank floor throughout the entire job, with minimum exposure to the tank environment. The crew from TDBR are especially happy about the BVLOS features of the Scout 137 Drone System, which work very

Inspecting a large, tall and pitch-dark cargo tank is hazardous and time-consuming. This happy crew got the job done in less than two hours.
well for them, in addition to the unlimited flight-time allowing them to complete large jobs without unnecessary interruptions.
“What we want next is the UTM Payload for the Scout 137”, says Marcelo Belleti, executive director of TDBR.
If you would like to know more, contact us: ScoutDI
www.scoutdi.com | sales@scoutdi.com
T: +47 73 60 49 90
NEW! Scan to read more about the UTM Payload for the Scout 137 Drone System.



39
4K photo of a deck transversal 26m above floor level. No climbing involved.
The Mini-Map is found top right in the Scout App. Here, the Scout 137 Drone is approaching a wall for Ultrasonic Thickness Measurement (UTM), and anti-collision is switched off. Wall contact is imminent, and
Pathfinder® Foam Caliper Pig, The Next Generation.
David Cockfield, Chief Executive Officer Pipeline Innovations Ltd, UK
The Pathfinder foam caliper pig is unique in the smart pigging arena. With more than 300 successful projects completed and over 10,000 km of pipeline surveyed since initial development in 2016, it has fast become an established geometry inspection technology supporting a range of pipeline pigging applications from construction through to decommissioning.
The medium density foam Pathfinder body has a high degree of compression that allows the tool to safely pass through significant reductions or restrictions in diameter making it the first choice for pipeline proving and providing piggability assurance in pipelines that have little or no history or present other challenges due to geometry, configuration, pipewall deposition and or debris build up.
Changes in pipe ID are detected by measuring the compression of the body using embedded technology buried in the foam matrix that align with sensors located in a stainless steel electronics data pack housed in the center of the pig. Compression of the outer surface of the pig body results in sensor system response that by calibration can be converted into pipe radius measurements. The patented design provides a highly flexible bore measurement tool which is capable of passing through restrictions of up to 40% of the nominal pipeline bore depending on tool size with minimal risk of the pig getting stuck in the line.
Over the last 18 months the operating platform has been subject to an extensive design improvement and development program leading to the second generation, Gen2, configuration. Improved Pathfinder tool performance specifications provide a
new and improved technology platform to build upon in the future.
From the outside nothing has changed. Functionality and operation of the tool remains unchanged. There are no external moving parts, cables or connections. There is no requirement to provide a caliper tool technician when running Pathfinder maintaining its position as a cost effective, low risk, easy to use solution.
Improved feature highlights include:
• 100x faster data download. The data is downloaded infield and transferred to the UK office for analysis via a drop-box link or similar over the internet. Data download has reduced from several hours to several minutes allowing us to further reduce the time taken to issue the Preliminary Report which in turn reduces infield standby as a qualified decision on the next step can be made in a shorter time frame.
• 10x increase in sensor resolution. Improvements in sensor technology have increased resolution that will allow us to identify and size features and anomalies with an improved accuracy and probability of detection.
• Built-in battery charging circuit for faster, more efficient charging. An integral charging circuit has eliminated the need for additional bulky charging equipment and resulted in a reduced charging time for the electronic data pack.
• Improved efficiency to provide longer battery life. Redesign and configuration of the motherboard has improved performance and reduced power consumption resulting in a significant increase in battery life.
• Expandable interface for additional sensing technologies. This will allow us to add further options for the acquisition of additional pipeline data. In particular it will support the addition of pressure measurement, direct temperature measurement and a pressure start mechanism. These options will be available in 2024 with the pressure measurement function planned for service from September 2024 .
All of our standard and ATEX 8 channel, 16 channel and 24 channel tools have been upgraded across the board to enhance operational performance, accuracy and continued reliability. Run time improvements enabled by the Gen2 hardware are detailed, on the bottom left.
4”
6” & 8”
8” to 12”
14” to 20”
20” to 36”

These improvements have enabled us to use the Pathfinder in applications where an extended battery life has been required due to planned delays in deployment time from initial loading into the launcher or in long run applications where operational constraints during production can result in delays and an
40
MIDSTREAM & PIPELINES
extended run time. A recent example of such an application is highlighted below.
An increasingly common requirement for Pathfinder is to provide a contingency caliper tool capability during pre-commissioning during new pipeline construction. A standard BiDi gauging pig is frequently used as part of the pipeline flood, clean and gauge phase. In the event that the gauge pig has sustained gauge plate damage then the location and extent of the anomaly that has caused the damage has to be established to determine any impact on integrity and identify an acceptable remediation or repair solution. The running of a caliper tool is necessary to facilitate that. Having the Pathfinder on standby, without the need for a caliper technician and lower rental rates by comparison to a metal bodied caliper tool provides a more cost effective solution. In a recent 4” new pipeline construction workscope, that same approach formed part of the project methodology. However, this particular pipeline was offshore, 40km long, in 75m water depth and was pigged wet end to wet end meaning that pigs were launched and received via a subsea PLET and PLR.
The flood, clean and gauge pig train was successfully launched and received. Upon recovery of the pigs significant gauge plate damage was evident indicating that there was a potential restriction or reduction somewhere along the pipeline length.


The Pathfinder tool would need to be run to accurately locate and size the potential cause of such damage.
Information from the tool is used to locate and measure variations in internal diameter and identify any other geometric anomalies in the line, allowing informed decisions to be made on pipeline integrity.
The Pathfinder had to be pre-loaded into the PLR at the clients onshore facility before being transferred to the vessel in readiness to sail to the offshore location. Pathfinder has to be switched on manually prior to loading into the PLR. The 4” Gen2 Pathfinder now has 130 hours battery life. That’s a comfortable 5 days, compared to only 70 hours with the original design. Sailing time was 2 days. With 48 hours planned for deployment including PLR subsea installation, Pathfinder launch, run, subsea receipt and recovery. Even with the extended battery life there was no contingency for delay. The Gen2 specification has the option of a delayed start. This is a client user interface that can be easily and quickly configured on site. The delayed start period was determined and activated before loading into the PLR.

Planning for potential delay in offshore mobilization and PLR deployment due to weather, meant that the client had over 3 days of contingency battery life on tool run time. The infield operation went well and the Pathfinder run was executed in a timely manner without any delay.
It was received in good condition with superficial single point localized damage in a longitudinal plane from front to back. Data quality was excellent and complete with a 100% run success. Subsequent data analysis at the project specified reporting threshold identified an anomaly with a 7% reduction in nominal ID that was classified as an excessive girth weld penetration.
The new Gen2 Pathfinder extended battery life, combined with delayed start up from the initial switch on was an important factor in achieving a successful geometry survey. The potential risk of a failed run due to depleted battery life was effectively managed and mitigated with ample contingency. The addition of the pressure start up feature later this year will further strengthen Pathfinder’s capability in supporting similar subsea projects in the future. •
If you would like to know more, please visit www.pipeline-innovations.com for more information. If you have any specific applications for Pathfinder or would like to view the detailed case study from this project, then please contact:
David Cockfield dc@pipeinn.com



41
Figure 1: Gauge pig damage.
Figure 2: Cleaning pig damage
Figure 3: 4”ns Pathfinder as received.
Figure 4: . Diameter plot with excessive girth weld (Anomaly 1).
Figure 5: Expanded diameter plot Anomaly 1
Automation Done Right – Do’s and Don’ts
One of the key components of any oil and gas project are pipes. Whether it is a refinery, a tanker, an offshore rig, or simply a cross-country pipe-line, it is impossible to complete without extensive piping systems.
Considering both the ubiquity of pipes as well as the growing scarcity of skilled welders, it is quite reasonable to look into ways to automate their fabrication, in order to reduce both operating expenses and man-power needs.
However, there are a lot of potential pitfalls and mistakes that can cause significant challenges or additional costs for any company that attempts to automate their pipe-spool prefabrication. It is therefore crucial to be mindful of a number of things.
3R solutions is an expert in the field of pipeshop automation, and has implemented projects all over the world for more than 40 years. They have helped their customers reduce fabrication times by up to 50% compared to conventional fabrication, while their software suite has helped reduce the time some customers spent on planning, tracking, and documentation of workshop activities by up to 90%.
This article is intended to share some of their experience and expertise. However, while 3R solutions is an expert in pipe-spool prefabrication, a lot of the ideas and principles discussed here are also applicable for other aspects of fabrication, and can be modified accordingly.
Why should you automate?
The industry is changing. Every year there are new methods, new technologies, and new approaches on how to make fabrication more efficient. At the same time there is a problem of growing demand contrasted with a decreasing supply of skilled workers. Simply said, there is too much work for too few people.
This means that increasing the man-power

on your shop-floor is not a viable long-term strategy, as you will find it harder and harder to not only find new workers, but also to retain your existing work-force, which will of course be aware of the high demand their skills are in.
The solution therefore is to make use of your existing workforce as efficiently as possible. And this is where automation is an obvious approach.
However, you should never automate just for the sake of automation. Instead automation

should always have three goals in mind. It should make the processes:
• Faster.
• Cheaper.
• Safer.
If automating a process does not satisfy at least two of these three criteria, then you should reconsider, and carefully weigh the costs and benefits. If your worker can perform a task in three minutes, at no risk and with no extra costs, then there is no point in spending money on a system that will do the same job in the same or more time. On the other hand, if the task is risky, or takes a worker a long time, and a mechanized system can do the same job faster and without risk, then automation is a worthwhile investment.
How should you automate?
Unlike for example the automotive industry, in oil and gas it is usually not viable to automate the entire fabrication process. This is because of the different types of projects in the two industries.
In automotive production there is a very limited number of different parts, but these parts need to be fabricated in high volumes, sometimes tens or even hundreds of thousands of times. In oil and gas projects on the other hand you may have tens of thousands of
MIDSTREAM & PIPELINES
A shot blasting machine cleans the pipe’s outer surface, making welding processes easier.
By automating the infeed and measuring, cycle times at a band-saw can be reduced significantly.
different geometries, each of which has to be fabricated only a few times, often even only once. In addition the automotive industry often uses calibrated pipes, with small diameters and very low tolerances, while the oil and gas industry uses larger pipes and standards are more lenient when it comes to aspects such as out-of-roundness (ovality) or wall-thicknesses, often allowing tolerances of several millimetres.
For these reasons the use of robotic fabrication cells, which can be run autonomously without the need for any operators is quite feasible and common in the automotive industry, while a similar approach is significantly less viable for the oil and gas industry.

A better idea for companies in the industry is therefore a combination of mechanized systems, which assist the operator by automating part of the process, and conventional fabrication for all those tasks and processes where automation is not economically viable.
This can include loading fittings into an automated, mechanized welding machine, laying a manual root for a 2D or 3D joint that is then completed using an orbital welding machine, or manually marking a cut piece of pipe with an ID number, rather than using an inkjet barcode printer to print a 2D barcode representing that same ID number directly onto the pipe.
There are still a lot of tasks that can and should be automated, because they can help save significant time, even though other tasks are continued in a more conventional manner.
These tasks and processes include:
• Shot-blasting pipes in order to not only achieve metallically clean surfaces for welding, but also to reduce wear on bandsaw blades and bevelling bits.
• Using automated handling systems, like roller-conveyors and buffer tables, in order to reduce use of overhead cranes and floor transport.
• Automated length measuring for cutting, significantly reducing the time spent on incidental work and increasing utilization of your cutting machines.
• Use of software to provide work orders directly to the operators, fitters and welders, and to achieve full real-time traceability of materials and worker performance.
What to avoid when automating?
Just as automation can bring a lot of benefits, there are also a number of risks and drawbacks, which you need to be aware of, so you can avoid them.
These include, but are not limited to:
• Automating for the sake of automation: as mentioned earlier, automation should always serve the purpose of making your fabrication cheaper, faster, or safer. If a machine or system fails to meet any of these criteria, then there is no tangible benefit compared to conventional methods, and automation has become an end of itself, rather than a means to an end.
• Automating too little / the wrong process: always be aware of connections and interdependencies in your workshop.

Any changes you make to a process will impact other processes. Unfortunately, however, a lot of shop managers focus only on part of their fabrication, usually the welding, because it is the most important aspect of fabrication, and is the one where problems and bottlenecks become obvious. However, improvements in welding will only be a partial solution if the actual problem is in work preparation / planning, cutting, handling, or edge preparation. And if a welder spends only 20% of their time welding, and 80% doing other work, then the goal should be to reduce the time spent on this other work, rather than the time it takes to weld a joint.
• Automating too much: at some point investment in automation will hit diminishing returns. This is because for every fabrication process there are parts that can easily be automated, while others become significantly more complex. Because of this at some point increasing the level of automation becomes exponentially more expensive. Especially in the oil and gas industry with its extensive range of requirements in terms of materials and dimensions, it may be more economically viable to focus on a key range of dimensions and processes, rather than trying to automate everything. Or in other words, if you can achieve 80% automation for an investment of X, 90% may easily cost you 3X, while 100% automation may cost 8X or more.
In any automation project it is therefore a good idea to get outside help from people who have successfully implemented projects before. Better to invest a little money in a consultant like 3R solutions, than to incur significantly higher costs for a workshop that does not meet your needs. •
If you would like to know more about the topics discussed in this article, please contact them at:
3R Solutions GmbH
Web: www.3r.de
YouTube: www.youtube.com/c/3Rsolutions
an
or
for
but
work
An orbital welding system can be used to weld complex geometries.
With
automated transport system no machine
worker has to wait
material,
can
continuously.
The Right Connection, Easy as 1-2-3
Safetrack, established 1988, is the leading developer and manufacturer of patented electrical cable connection systems for the Railway, Grounding and Cathodic Protection industry.
One of these systems is the world-renowned PinBrazing System, which Safetrack has further developed to a patented automated, digitally controlled system.
Safetrack’s patented electronic PinBrazing system is an extremely efficient, low temperature arc brazing method used for attaching electrical connectors to steel structures within Cathodic Protection systems such as pipelines, vessels, reinforcement bars, wind power, grounding, etc, without the need for welding which can melt the base steel material. No need for different carbon molds for different wires. Safetrack’s application methods always use materials of the highest quality to ensure the best electrical conductivity, corrosion resistance and strength.
The secret behind the patented system is a specially developed silver-based alloy which melts (650ºC) through a strictly controlled energy distribution from a self-developed, patented, and an automated Brazing Gun. The automated Brazing Gun is connected to one of the lightweight, easy to use, battery powered, patented PinBrazing units which controls all the electronics. Installation of cable connections are made quickly and safely, in all weather, at any time. Rain or snow is no longer a problem for making installations. There is no risk for the operator or the material which is PinBrazed upon.
Safetrack’s PinBrazing is used in many industries to connect cables and is particularly suitable for use in the cathodic protection industry for connecting cables to pipelines, ships, rebar, etc.
Furthermore, Safetrack manufactures and distributes many other products, such as rail trolleys/scooters, connection clamps, overhead contact lines, powerful lightings, signaling systems, professional work tents and much more. Safetrack represents several international Railway and Cathodic Protection companies. The construction and utility industries are also areas where Safetrack’s product line and systems are being increasingly used.
The product portfolio also consists of many new product groups, such as different types of lighter rail vehicles, railway aids and equipment as well as products for police, crime scene and rescue service.
The process
The process of connecting cables through

Safetrack’s PinBrazing system is as easy as 1, 2, 3.
1. Grind the surface
2. Attach the grounding device
3. Pull the Brazing Gun trigger.
The automated equipment will distribute an exact amount of energy (patent) to the brazing pin. The flux cleans the surface and the special silver alloy melts onto the connected material and surface. In about 1 second, you have created an extremely efficient and reliable silver contact between the cable and the pipeline.
Safetrack® PinBrazing: Invented, developed and manufactured in Sweden
• Fast: The PinBrazing process only takes one second and the whole procedure is completed in minutes.
• Low temperature: Does not affect internal coatings.
• Safe for the material: Does not melt the work surface as exothermic welding does. Only a thin layer of silver is applied between the pipe and the cable wires.
• Safe in all weather.
• Suitable for use on pipe-laying barges, No need for special molds
• Safe for the operator: Battery-powered 36VDC system without hazardous materials.
• Strong molecular bonding: Silver ensures strong molecular bonding with the lowest possible transition resistance.
• Easy-to-use, automated process: Just press the trigger and the automatic 1-second process does the job.
For Pipelaying vessels, it is very important to connect the bracelet anodes to offshore pipes fast and safe, both in a horizontal and vertical position. PinBrazing has all these advantages compared to thermite welding or other welding methods; PinBrazing is easy and fast to use also on vertical surfaces, can be made in any weather conditions, does not melt the steel down in the pipe (which is not very popular among the infrastructure owners), PinBrazing just melts a layer of silver between the cable from the anode to the pipe which also gives the best electrical properties to the bonding.
Use the Safetrack PinBrazing system when attaching the Jumper Bonds over the joints. When you need the very best (silver) connection with the lowest possible transition resistance of your Cathodic Protection cables to steel, ductile or cast-iron pipe, vessel, tanks
MIDSTREAM & PIPELINES
“Installation of cable connections are made quickly and safely, in all weather.”

or reinforcement bars. No more confusion and maintenance with thermite weld molds and weld portions. Just Pin Braze your cables, easy and quick!
Cable Protection
One of Safetrack’s other important areas is Cable Protection through the brand Protectus. Protectus is a high strength divisible cable protection pipe which saves money and is environmentally friendly at the same time. Thanks to the use of recycled plastic, one reduces the environmental impact with 80%. The use of Protectus will save millions of liters of oil each year, thanks to clients caring for the environment and therefore preferring Safetrack products. Protectus is lightweight, divisible, can be angled 15º and requires no tools for installation. Protectus has been tested at the Technical Research Institute of Sweden to make sure that they meet the high demands from customers worldwide.
Background
The founder and entrepreneur Torsten Baavhammar, who worked for a long time in a subsidiary of the gas and welding company AGA and Esab, had for a long time been thinking about how to further develop and modernize the PinBrazing method to minimize or even eliminate the need for maintenance or training.
The only way to fully implement these ideas was to start a new company specializing in electrical cable connection systems. The year was 1988 and the company Safetrack Baavhammar AB was formed.
After years of hard work, Banverket (now Trafikverket) became an important customer for Safetrack moving forward. Outside of Sweden, Alstom were also one of the very first important companies to start cooperating with Safetrack
from the beginning.
Many successful years have passed and since the establishment 1988, today Safetrack have distributed electrical cable connection systems to over 70 countries worldwide within the Railway, Grounding and Cathodic Protection industry.
The CEO today is Johan Baavhammar, the son of Torsten. The company has developed several innovative cable bonding systems and has also branch offices in Australia which is a growing market for Safetrack. Most of the staff
that were hired in the early years still work there and have been of utmost importance to the success of the company. •
If you would like to know more about how Safetrack Baavhammar AB can help your company and its operations, please contact them at:
Safetrack Baavhammar AB
T: +46 (0) 40-44 53 00
E: sales@safetrack.se
W: www.safetrack.se

protection at site. Natural gas valve station.
Cathodic
Yinson Announces Private Placement of up to 120 Million Shares to Support Energy Transition Businesses
Yinson has completed an accelerated book-building exercise, placing out 120,000,000 new ordinary shares, representing approximately 4.1% of the total number of issued shares (excluding treasury shares) of the Company, to a selected group of institutional investors. Putting this into perspective, Yinson raised RM283.2 million in proceeds from this energy transition placement exercise.
Kumpulan Wang Persaraan (Diperbadankan) [KWAP] subscribed 50 million shares as the anchor investor supporting the transition placement. As a signatory to the UN Principles for Responsible Investment (UN PRI), KWAP’s commitment towards responsible investment practices underscores this mobilisation of capital.
The proceeds will primarily be used to expand Yinson’s renewables and green technology businesses. This move is expected to contribute positively to the Group’s earnings potential moving forward while further strengthening the Group’s equity and capital base. AmInvestment Bank has been appointed as the Adviser and Placement Agent for this exercise.
Commenting on the private placement, Yinson Group Chief Executive Officer Lim Chern Yuan said, “Prospects for our renewables and green technologies businesses have never been stronger, given the world’s critical need to strengthen global clean energy infrastructure to facilitate a just and equitable energy transition. Proceeds from this placement will enable us to accelerate our strategic plans for Yinson Renewables and Yinson GreenTech to capitalise on market opportunities, which we are confident will contribute to stronger, sustained returns over the long-term. We thank KWAP, as well as other valued institutional investors, for placing your trust in us.”
Hazman Hilmi Sallahuddin, Chief Investment

Officer at KWAP commented, “We are proud to support Yinson’s energy transition endeavours as an anchor investor in this placement. Our investment aligns with our commitment to responsible investing, which we have firmly committed to as a signatory to the UN PRI. By mobilising capital towards energy transition initiatives, we aim to foster positive environmental impact while delivering long-term value to our stakeholders.”
PETRONAS and JERA to Explore Feasibility of the Entire CCS Value Chain Between Japan and Malaysia
Kuala Lumpur, PETRONAS, through its subsidiary PETRONAS CCS Solutions Sdn Bhd (PCCSS), recently signed a Joint


Study Agreement (JSA) with JERA Co., Inc (JERA), to evaluate the feasibility of the entire carbon capture and storage (CCS) value chain including separation and capture of carbon dioxide (CO2) emitted by JERA in Japan, cross-border transportation, and CO2 storage in Malaysia.
This agreement will strengthen the collaboration and contribute towards building a global network for cross-border CO2 transport and storage.
The JSA represents a notable stride forward in efforts to reduce greenhouse gas emissions in the Asia Pacific region, especially in Malaysia and Japan.
PCCSS Chief Executive Officer, Nora’in Md Salleh said, “This agreement signifies a pivotal step towards enhanced collaboration with an important partner. This spirit of collaboration will speed up progression and enrich CCS delivery by leveraging the vast experiences of the two organisations. This is in line with PETRONAS’ commitment in accelerating the development of prominent CCS hubs in Malaysia, for the region.
PETRONAS is championing CCS as a key solution in addressing emissions from its operations as well as other industries. Recognising the importance of regional collaboration in addressing climate change, PETRONAS continues to form strategic collaborations as part of its deliberate steps in building a resilient and sustainable portfolio, while accelerating its NZCE 2050 pathway. •
46
MIDSTREAM & PIPELINES

Schäfer Pumps & Hydraulics
We are proud of our almost 100-year experience in the construction of positive displacement pumps at our location in Germany, which is characterized by our quality standards and our absolute customer focus. The products are uncompromisingly designed for long-term use. To ensure this, we supply our customers and products worldwide with original spare parts for many years
Pump Product Series


H HDP: The compact HDP high-pressure quintuplex pumps are equipped with five pistons for low pulsation and an integrated gearbox. Reliable design for the highest demands e.g. hydraulic supports in longwall construction. They are ideal suited for pumping process water in continuous operation at up to over 500 bar.

S SPH: The SPH high pressure and flow mud pumps are eqipped with three pistons, designed for a wide range of drilling fluids operating at pressures up to 530 bar. Its design has proven its reliability in a wide range of water hydraulic fluid applications and under the harshest conditions.

S SPN: The SPN are triplex piston pumps for medium pressure ranges up to 150 bar with flow rates of up to 3700 l/min. Thanks to their compact design, they demonstrate their potential above all in mobile applications for pumping drilling fluid suspensions with or without bentonite.
Durable Pumps for Water,
emulsions, drilling fluids like bentonit and many more.
Reliable Operation through longterm service and maintenance.
German engineering with a passion for precision and attention to detail
Schäfer Pumpen & Hydraulik GmbH D-45527 Hattingen, Henrichs-Allee 8



47
E
T
WWW
MAIL : INFO @ SCHAEFER - PH . COM
EL : (+49) 2324 / 439740
. SCHAEFER - PH . COM
Bridging Energy Access Gap Vital for Nigeria’s Economic Growth, Says NNPC Chief
The Nigerian National Petroleum Company Limited has emphasized the critical importance of bridging the energy access gap to the creation of economic prosperity of the country.
The Group Chief Executive Officer of NNPC Ltd, Mr. Mele Kyari, made this submission in a keynote address on industry operations with the theme, “Stability in the Energy Sector: Integrated Strategies for Infrastructure, Transportation and Security,” at the 2024 edition of Society of Petroleum Engineers Oloibiri Lecture Series and Energy Forum (SPE OLEF) held in Abuja.
To bridge the energy access gap in Nigeria, Kyari said NNPC Ltd was working on developing the right infrastructure to deliver oil and gas to drive prosperity for Nigerians.
“We are committed to developing gas infrastructure across the country,” Kyari stated, stressing that the company’s commitment was not just a statutory requirement of the Petroleum Industry Act, but a pledge to ensure energy security beyond fuel supply.
“We are dedicated to investing in critical infrastructure to enhance economic prosperity by supplying gas to the domestic market, targeting at least 8 billion cubic meters,” Kyari added.
He listed some of the infrastructural projects being undertaken by the NNPC Ltd to help bridge the energy access gap in Nigeria to include the Obiafu/Obrikom/Oben (OB3) and Ajaokuta-Kaduna-Kano (AKK) pipelines, adding that they are designed to enhance the nation’s gas supply network.
On the global front, Kyari said NNPC Ltd was working on expanding gas supply to the international market primarily through the NLNG Train 7 project while efforts were also being made to kick off Train 8 as well as the various floating LNG initiatives.
Kyari called for support in leveraging Nigeria’s abundant gas resources for economic prosperity, emphasizing the need to bridge access gaps in



electricity and clean cooking fuel.
He assured stakeholders and investors of the support of President Bola Ahmed Tinubu, whom he said is committed to the gas revolution.
Also speaking at the event, Chairperson of the Society of Petroleum Engineers (SPE) Nigeria Council and Head of Asset and Investments Management, NGPIS, Engr. Salahuddeen Tahir, emphasized the critical role of energy in modern society, stating: “It’s a trigger for essential services such as transportation, heating, electricity generation, medical services, security, banking services, and communication.”
Tahir said there was need to develop a diversified and sustainable energy transportation system as a measure for mitigating climate change and enhancing energy security.
Seplat JV STEP Graduates 358 Teachers in Edo, Delta States. The NNPC E&P Limited/ Seplat Energy Joint Venture (JV) has graduated 331 teachers and 27 Chief Inspectors of Education (CIE) at the 2024 edition of the Seplat JV Education Summit and Seplat Teachers Empowerment Programme (STEP) graduation ceremony for Edo and Delta states. The events, held in Benin City, are hinged
on the Joint Venture’s continued quest to contribute towards the improvement of quality education in the communities and states where Seplat Energy operates, and by extension Nigeria. Public and private school teachers were beneficiaries of the programme.
STEP is designed to promote teacher’s creative thinking, provide training on teaching applications for Science, Technology, Engineering, Arts and Mathematics (STEAM), provide leadership and self-improvement training, allow for higher student’s engagement, and offer a well-rounded education for recipients of the programme.
For this edition, which is the fourth, a total of 358 teachers graduated from the programme and were presented with requisite certificates.
The programme is targeted at secondary school teachers in public and private schools in Delta and Edo states, including the communities where Seplat Energy operates. It is a six-month intensive training programme which kicks off with a four-day residential workshop aimed to provide leadership and self-improvement training, training on STEAM modules and its application to teaching. The teachers are also provided with STEAM gadgets and Apps to support their delivery of quality teaching in their schools. •
48
MIDSTREAM & PIPELINES


Online TOC Analysis in Return Condensate and Boiler Feed Water
TOC analysers as money makers in refineries
Crude oil refinement is a very energy intensive process. Steam and hot water are of a big concern for processing. Its contamination leads to corrosion in, for example, pipes, boilers and heat exchangers. The monitoring of these can provide enormous cost savings. Therefore, an oil-in-water analyser is required and in this case a TOC analyser is an excellent choice.
Theproduction of steam and hot water is vital for the operation of many types of installations and facilities in crude oil refinement. High pressure steam is used for generating electrical power, for driving turbines, utility pumps and for process heating. Medium pressure steam is typically used for heat transfer to refinery products via heat exchangers and the low pressure steam is used for a variety of purposes e.g. pipe tracing, process heat exchange and deaerators. Although the temperature of the steam continues to decrease and it becomes hot condensate, it still contains a lot of energy and remains very valuable. Significant cost savings can be attained through the reuse of the socalled return condensate or steam condensate.
Condensates’ purity is vital
The purity of return condensate is of vital importance and should be monitored by an online TOC analyser that measures any oil type in a range from 10 ppb to over 100 ppm together with organics that do not belong to oil groups. At refineries, the alarm thresholds are about forty times cleaner than drinking water (100 to 1,000 ppb range). Therefore, the analytical performance of the TOC analyser must be outstanding and tough demands are made by the industry regarding accuracy, response times and traceability.
Typically, in an oil refinery, there are cogeneration plants in operation. A cogeneration plant consists of a demineralisation water plant and a steam boiler. Even traces of carbon dioxide can harm the boiler installation. Inside the boiler at the elevated temperature and pressure carbon dioxide (CO2) will be
Commissioning and startup of a TOC analyser.

transformed to carbonic acid, a corrosive substance that causes the pit corrosion of metals. Dissolved oxygen, especially when it increases rapidly to a high temperature, will cause pit corrosion in the boiler system, too. Oxygen pitting is a costly problem and it can be minimized when even traces of dissolved oxygen are removed from the make-up water using a deaerator. The oxygen solubility in water decreases tremendously at increasing water temperatures. The make-up water flows through a deaerator where it is heated using steam, consequently purging out the oxygen. Any remaining traces of oxygen are removed by a chemical reaction through the introduction of oxygen scavengers. Additionally, a variety of other chemicals are dosed. Examples include amines to build up a protective film over the metal surfaces, anti-scaling chemicals to maintain the heat distribution and anti-foam chemicals to prevent the forming of foam in the boiler.
The costs involved in the production of pure make-up water are very high and savings can be made by reusing the steam condensate. For every ton of steam, that has past numerous heat exchangers and is returned to a feed water holding tank at the boiler facility as return condensate, saves on the production of one ton of demineralised water. Another lucrative aspect to the recycling of return condensate is that normally it is still hot, e.g. 90 to 120°Celsius, thus representing yet another large energy saving. However, the drawback of this well thought out cost saving system is the risk of importing contaminated steam condensate.
The steam’s energy is transferred to process fluids e.g. crude, mineral oils and other products by use of heat exchangers. A common type is the pipe bundle heat exchanger and in a refinery hundreds of these heat exchangers are used. Due to the high temperature of the steam and the presence of traces of oxygen that have penetrated into the plant’s steam piping system, these heat exchangers are also subject to pit corrosion. Despite the associated inspections and maintenance intervals, there is always a risk of a break through, leading to pure products e.g. hydrocarbons, crude oil, petrol, kerosene and lube oils leaking into the return condensate. This contaminated return condensate can flow into the holding tank,

finally entering the boiler, where it could lead to disastrous metal corrosion. However, it is possible to monitor the quality of the return condensate using a quick online TOC analyser and to drain it off as soon as a trip alarm TOC level is exceeded. Here, it is important to note that all organics will harm the boiler, and that non-oily types of organics, just as any other type of organic, the smallest amounts of hydrocarbons or oil traces are measured by the TOC analyser.
A TOC analyser system should respond quickly to a breakthrough of an oily matter, triggering an alarm as fast as possible, to allow the prevention of oil from entering and fouling the installations. This early warning system activates a process valve with any abnormal TOC increase, allowing the contaminated condensate to be drained off and the leaking heat exchanger to be located and repaired.
Requirements of a TOC analyser within a refinery
Generally, a TOC analyser monitoring system should measure accurately, giving precise TOC measurements at a ppb level, respond quickly, and presenting the result within minutes. The TOC levels to be monitored are in the low ppm or even ppb region. The hydrocarbon molecules have a tendency to stick to the whetted parts of the sample transfer pipes and analyser parts (adsorption). After a while saturation takes place and a more or less stable equilibration level is reached, however, minutes later these absorbed molecules can become free, so-called desorption. Not only are the analytical TOC results influenced by this cross contamination, but the memory
50
PROCESSING
Heat exchanger with 5 plugged heat pipes.
effects can cause the entire analyser system to operate very slowly. The extent of these phenomenon depends on the type of material of the whetted parts, the flushing velocity, the flushing time, the temperature of the fluid and, more specifically, the type of organic matter. Oily matter in particular is subject to adsorption and desorption. This all becomes especially challenging when a single TOC analyser is used to monitor several sample streams. The multi-stream TOC analyser should rapidly and sequentially measure samples with different TOC levels and different compositions.
However, cross contamination and carry over effects are then hard to avoid. Nevertheless, the TOC analyser must be able to rapidly return to accurate TOC values, even after having been exposed for hours to a highly oily mixture. Many TOC analysers continue to suffer from severe memory effects because of the pollution of the wetted parts by the sticky oil. As a consequence these analysers show very high measurements over long periods, during which plant operators keep flushing expensive pure condensate down the drain.
Another potential problem to be faced is the fact that the TOC analyser is placed in the centre of a refinery. The CO2 and volatile organic carbon (VOC) content of the ambient air here is often at a higher level than normal and these gases should not be able to influence, penetrate, permeate or leak into the analyser system nor the samples.
Besides all this, there is a need to be able to calibrate or validate the TOC analyser quickly and easily. Usually, it is performed by the use of wet chemical standards using an expensive water purifier producing 5 liters ultra pure water per day with a TOC purity of 10 ppb. Under stringent circumstances and using a considered time frame, these standards can be prepared. But as soon as they are ready, they are subject to degradation and contamination, as they can
only be stored at ideally cooled conditions in totally filled, sealed bottles for a few days at a time. When a TOC analyser measures a TOC peak, it becomes suspect to the plant operator, as they are not happy to drain their expensive return condensate. The analyser engineer must prove immediately that his TOC analyser is taking correct measurements. An ad hoc certified standard is needed. However, it is not possible to prepare such a standard in an instant.
Outstanding TOC analyser
At the heart of the QuickTOCpurity TOC analyser is the well designed multiloop injection system as the pre-eminent methodology for sample transference and injection of oily samples. During a programmed determined time period all parts, including the sample injection loop, are flushed with a fresh sample. Then a precise volume of the sample is blocked inside the injection tube. Seconds later the content of the sample injection loop is pushed by carrier gas via the injection port into the 1,200ºC reactor. Normally, one single loop injection is sufficient to achieve a high resolution detector signal. However, for the lower ppb TOC range the sample loop can successively be injected multiple times. This loop injection system is constructed of inert material to avoid absorption and memory effects and can resist temperatures of up to 90ºC.
The second important analyser building block is the high temperature reactor. Its principle is based on non-catalytic thermal oxidation at 1,200°C. The sample, containing hydrocarbon molecules, is injected into this reactor tube. At 1,200°C it is physically impossible for compounds to survive. Experience demonstrates a full recovery rate even for very hard to oxidise compounds e.g. fluorocarbons, chlorinated hydrocarbons, amines. Without exception all hydrocarbon compounds are completely oxidised thereby forming CO2 gas. A carrier gas flows through the reactor and transfers this CO2 gas to a non-dispersive infrared CO2 gas detector (NDIR CO2 detector).


the operator can easily and immediately calibrate or validate the analyser by using a cylinder filled with a certified gas mixture. This gas calibration gas, such as a methane and nitrogen mixture, is very stable and can be stored over a period of several years, making it readily available and always ready for use. The injection loop is filled with the gas and injected into the reactor. There the gas is oxidised to CO2 and the amount is then measured by the NDIR CO2 detector. Within 10 minutes the calibration and validation routine is complete. Another important feature of the Process Insights QuickTOC for pure water is the possibility to analyse grab samples from individual heat exchangers. This can save a lot of time in identifying which specific heat exchanger is leaking.
Cash Savings
The amount of carbon dioxide that is measured, is linearly proportional to the amount of organic carbon molecules (TOC) in the sample. This shows that Process Insights´ ultra high oxidation technique is free from memory effects, giving excellent low TC and TOC level performances in comparison to other oxidation techniques, such as 800-900°C catalytical oxidation systems, which do suffer from this phenomena.
The QuickTOCpurity uses a smartly designed carrier gas system. Its flow circuit is kept at a stable overpressure of 0.4 bar. This design eliminates the risk of any ambient air interferences which occur frequently at refineries.
The third important analyser building block is the calibration and validation system. The Process Insights QuickTOC analysers offer a unique patented validation feature. Whenever needed, Process Insights QuickTOCpurity.
Money is to be saved not just through cutting energy costs in reusing return condensate alone, but also by the effective analysis of its purity. The TOC analyser used, needs to be fast and reliable and the QuickTOCpurity analyser is just that. Its patented thermal oxidation technique guarantees that all hydrocarbon compounds are completely oxidised without exception, and offers the added saving of this technique negating the need to use expensive catalysts, as with other catalytic oxidation analysers. The totally sealed system, maintained at an overpressure of 0.4 bar, means that only the sample is measured without any environmental interferences influencing the measurements. Furthermore, the well designed multi-loop injection system has reduced internal dimensions and minimised wetted surfaces, as well as no dead volumes, meaning that memory effects are avoided. The quick and easy calibration and validation of the Process Insights analysers offers operators the assurance that their analysers are giving accurate results and that they are not pouring expensive condensate down the drain. •
Author: Dr. Vitali Scherbahn
Process Insights GmbH
Contact:
Process Insights GmbH
Tel.: +49 69 20436910
E-Mail: info@emea.process-insights.com www.process-insights.com

51
Heat exchangers in a refinery.

GOOD CHOICE: How Optimal Process Filtration Boosts Sustainability
The right choice of filtration equipment helps oil and gas producers avoid costly interference to critical upstream processes, midstream and refinery capacity and downstream energy supply.
For many customers, products and solutions from Amazon Filters make a positive difference to business-as-usual activity, OPEX reductions and commercial performance.
Asupplier of depth filters and bespoke pressure vessels since 1985, the company has just become the first process filter maker in the UK to use polypropylene from renewable resources in production of its meltblown filter media.
The move effectively lowers the carbon footprint of each filter in the SupaSpun II, SupaGard, Contour and VisClear II ranges while ensuring the same, robust level of polymer quality as in fossil-based plastics.
Rigorous testing has shown that replacing one tonne of conventional polypropylene with the sustainable material will stop 2.1 tonnes of carbon emissions. In terms of filter use, that translates to a reduction of 1 kg in emissions for every 30” meltblown filter.
Amazon Filters’ key message is that choosing quality design proves far more sustainable over time and is a sensible decision from the outset of procurement.
Four examples illustrate the point, involving:



produced water treatment; diesel hydrogenation; the protection of membrane filters; and optimal housings design. Produced water

The operators of an offshore rig asked for help to tackle the repeated blocking of filters used in the polishing stage for preparation of produced water.
Managers were facing high costs because of the logistical challenge of transporting and installing high numbers of cartridge filters offshore and the downtime required for frequent change-outs.
Working with the operators and their treatment system provider, Amazon Filters’ team analysed the on-site conditions and the state of returned spent cartridges. The key issue was found to be sludge contamination.
Project Specialist Padrig O’Hara says: “We developed a bespoke filter media construction based on our SupaPleat XP extended life depth technology. We tested and validated

the solution to ensure the required cut-off of solids removal and guarantee efficiency. We also optimised the structure of the depth media to provide more resistance to surface blinding from the fouling mechanism. And we recommended changing the upstream chemical injection to minimise the precipitation of waxy crudes and coagulation of oil that was interacting with the solids and contributing to the fouling.”
Following the upstream process improvements and the adoption of the new filter cartridges, the client saw a noticeable
52
PROCESSING
Padrig O’Hara, Amazon Filters
Riaz Esmail, Amazon Filters
Above: Example of Sludge.
improvement in filter life.
“It went from under one week to an on-specification life of a month or more with associated cost, logistical, and environmental benefits,” explains Padrig. “There is a 30-fold decrease in the number of cartridges used compared to the worst-case performance of the previous filters. Not only does this deliver huge cost savings, but it also has a major impact on the amount of used cartridges going to landfill.”
Diesel hydrogenation
Tighter emissions regulations coupled with the reduced availability of low sulphur crude oil means the process of hydrotreating in the production of Euro 5 diesel is increasingly critical. It begins with mixing straight run and heavy diesels before the fluid passes through a filter to remove unwanted particulate.
This prefiltration stage is vital in ensuring the catalyst bed, typically cobalt molybdenum, is sufficiently protected. Particulate contamination onto the bed can severely impact process flows and efficiency, risking higher OPEX.

Problems with prefiltration upstream were reported by process engineers at a giant diesel hydrogenation unit reactor in Southeast Asia. The main issue was the service life of the original filters, which had to be able to operate in a continuous, high-temperature process stream.
Made with glass microfibre media, the filters were becoming stuck in the tube sheets and had to be changed, at worst, every shift and, at best, every three days.
Super duplex housings Amazon Filters has recently designed, built and shipped to an FPSO off the coast of Brazil. The vessels weigh 3,750 kgs and have a diameter of 1.8 metres.

“The upshot was not only the added expense of significant additional consumable filter costs but also extended maintenance time required for change-out,” says Padrig. “Working with the operator’s process engineers, we designed, manufactured and supplied prototype filters of three different micron ratings for trials of performance and fit. Made with pleated nylon media, they were at the customer’s site in Malaysia within four weeks. We also supplied them as single-piece construction, replacing the previous multi-weld which was another potential source of failure in such an aggressive environment. Since installation, they have continued to deliver the specified filtrate quality while demonstrating a significant increase in on-stream service life.”
Membrane protection
Reliable pre-filters play a crucial role in seawater filtration by ensuring the membrane filters that reduce sulphates are not damaged by larger particles. But pre-filters themselves are vulnerable to biofouling from algal growth.
To combat this, Amazon Filters has introduced KilBac technology to its SupaSpun depth filters. SupaSpun KilBac harnesses the power of micron-sized zeolite particles containing active silver, zinc, and copper to suppress the growth of algae and bacteria.
“With absolute removal ratings of 1 to 20µm, SupaSpun KilBac provides a highly consistent and reliable solution,” says Padrig. “Our tests show it can more than double the service life of the prefiltration stage. Producers can expect substantial cost savings on their filter spend from reduced
downtime, more effective throughput and the avoidance of costly clean-in-place cycles.”
Housings design
Amazon Filters supplied a pair of 1.8m diameter housings for an FPSO off the coast of Brazil. Weighing 3,750 kgs each and manufactured from high-performance super duplex stainless steel, they were required because the previously installed coated carbon steel housings had failed within two years of implementation.
Padrig says: “This was due to incorrectly designed geometry for the protective coating coupled with poor ergonomics causing physical damage during filter change outs. Costly design mistakes. Correct material specification and compatibility is paramount. Working with a supplier that can develop and produce bespoke products is priceless when you need to solve problems quickly.”
Padrig’s thoughts are echoed by mechanical engineer and Internal Sales Manager Riaz Esmail, whose team delivers technical proposals and quotes.
“Vessel design issues result in short service life,” says Riaz. “If you need expert help on the design of housing and filters for on- or offshore application, we’re here to help. Remember, experience counts and is often invaluable.” •
For more information on Amazon Filters’ support for oil and gas, including its new sustainable polypropylene meltblown filter media, visit:
www.amazonfilters.com/industry/oil-andgas-filtration.

53
SCHOTTEL: Groundbreaking Ceremony for New Logistics Center in Dörth
SCHOTTEL GmbH is expanding its rudder propeller factory in Dörth with a logistics center measuring around 4,000 m2. Since the official groundbreaking ceremony was delayed, it now took place symbolically against the backdrop of the shell construction that had already begun. The total investment volume amounts to 9.5 million euros.
Commissioning planned for 2025
The construction work by the general contractor Goldbeck is on schedule: supports and the first external walls give an impression of the volume of the 2,634 m 2 commercially used area. In the future, efficiently designed goods delivery, crane systems and a fully automated warehouse will represent state-of-the-art warehouse logistics. The foundation work for the adjacent office wing with 1,326 m 2 of usable space is currently being carried out; construction of the three-story building is scheduled to begin in the spring. After construction acceptance and operational setup, regular work is expected to begin in the first half of 2025. This means that the currently double warehouse logistics of goods from new plant production in Dörth will be combined with those from the spare parts business from Spay, 30 km away.
Drive technology from the Hunsrück for the international market
The new construction business increased significantly in the first few months of this year: SCHOTTEL will manufacture more than 350 large and small systems in the Hunsrück in 2024 for shipyards in global maritime centers. With the orders for the Wismar plant, there are over 500 drives in the order books with a delivery date by the end of December. There is also an increasing need for spare parts in

after sales: around 10,000 ships worldwide operate with SCHOTTEL - sometimes with one, sometimes with up to five engines. In the future, customers will benefit from significantly higher availability of spare parts for these drives.
Sustainability in the building envelope, building technology and energy generation


The new building will meet very high criteria for sustainable construction in accordance with ESG requirements. This refers to environmental, social and responsible corporate management requirements (environmental, social, governance). With regard to the building envelope and building technology, industrial insulation, heat pump technology and heat recovery support the high-quality sustainability concept. The new roof will be structurally prepared to accommodate a photovoltaic system. It will further increase the volume of energy generated in the existing building by 700,000 kWh annually. Around half of the suppliers for the new building will come from the region, which will strengthen the local economy.
The employees of the service warehouse moving to Dörth will find very modern workplaces in the new logistics center. In Spay, employees will remain in the commercial, technical and commercial departments as well as those in the administrative after-sales area. Of the total investment of 9.5 million euros, 7.5 million euros went to the construction of the hall and office wing. They are supported by the industrial investment company SCHOTTEL Industries GmbH. SCHOTTEL GmbH will use two million euros for operational investments. •
54
PROCESSING

H2-content? Calorifc value? Methane number? Z-Factor?
H2-content? Calorifc value? Methane number? Z-Factor?
Using our gasQS™ technology you can determine numerous gas properties with high precision and within shortest time.
Using our gasQS™ technology you can determine numerous gas properties with high precision and within shortest time.
Suitable for hydrogen shares up to 100 % Fast measurement, short response time Metrology
OIML R140 Class B compliant CVDD
OIML R140 Class B compliant CVDD
Suitable for hydrogen shares up to 100 % Fast measurement, short response time
Robust with low maintenance, no carrier gas
Robust with low maintenance, no carrier gas
Swiss
www.mems.ch
Metrology
Made
Swiss
www.mems.ch
Made
Balancing the Grid with Hydrogen Storage
Promising solutions, such as hydrogen storage, can counteract the intermittency of solar and wind energy and optimize the use of stored energy when the wind doesn’t blow and the sun doesn’t shine.
Certification and testing play a pivotal role to ensure hydrogen storage is carried out safely.
“The phase-out of fossil fuels is essential and inevitable to avoid a global climate catastrophe.” That is the position UN Secretary-General Antonio Guterres has taken, voicing what several global leaders have come to realize.
The massive reliance on renewable energies everywhere in the world is one of the ways of mitigating climate change and renouncing fossil fuels. Global investment in renewable energies is steadily on the rise. A report by the International Energy Agency shows that for the past few years, renewables have seen higher investment than fossil fuels. According to the report, in 2023 low-emissions power is expected to account for almost 90% of total investment in electricity generation.
Solar photovoltaic energy is the main beneficiary of this investment surge, while financing for wind energy is more patchy, depending on the years. Hydropower, while also a renewable energy, has seen its share of investment decline over recent years.
Ensuring constant supply to the grid
Wind and solar energy are intermittent and cannot be relied upon to constantly meet the grid’s electricity requirements. Innovative solutions have emerged to ensure a continuous power supply. Solar or wind energy can be stored using batteries and grids can be supported by industrial-scale battery sites or other grid-scale storage technologies. Pumpedstorage hydropower is one of the most widely used technologies in this regard, where water is

pumped up into reservoirs and can be released to generate electricity in times of demand.
For instance, in the UK, when wind and solar are not generating power, the grid infrastructure is supported by a range of technologies including flexible hydro plants that can provide power immediately when needed. Hydropower does not have the same constraints of intermittency as solar and


wind and contributes to the biggest share of renewable electricity generation worldwide. There is also the scope of scaling up “interconnectors” to share energy supplies between countries. The concept revolves around balancing energy supply and demand. When one country faces reduced energy supply, perhaps due to minimal wind activity, it can rely on a shared supply pool, tapping into excess energy from neighbouring countries. Already, countries such as Denmark, Germany and the UK have setup interconnectors to share the supply load from renewable energies with nearby countries.
Periods of under-supply can cause fluctuations in the grid, which may result in brownouts or in complete power outages. Smarter and more flexible grids using advanced energy storage systems and communication technologies are needed to balance supply and demand in real time.
Grid balancing refers to ensuring the correct amount of electricity circulates in the grid to prevent fluctuations resulting in disruptions or outages. Researchers have been working on innovative technologies and storage alternatives for grid management and balancing, and there is a growing interest hydrogen storage. •
56
HYDROGEN


























“Cost


























www.zinga.eu No limitations! No limit of size, design, condition or location of the structure to be treated.
FRONTLINE
effective and time efficient” ZINGA®
MAINTENANCE
Leadership Newspaper Names Seplat Energy as Oil & Gas Company of the Year

Seplat Energy Plc, leading Nigerian independent energy company listed on both the Nigerian Exchange Limited (NGX) and the London Stock Exchange (LSE), has emerged as the Leadership Newspaper Oil & Gas Company of the Year.
The Company was honoured at the recently concluded Leadership Annual Conference and Awards held in Abuja.
According to the Leadership Group, Seplat Energy was recognised for striving to end routine flares in its operations by committing $11.5m towards projects that will end flaring and another $10.8m towards installing gas compression facilities at the flow stations in Amukpe, Oben and Sapele.
The media group stated: “Seplat Energy is a leading supplier of processed natural gas to the expanding Nigerian domestic market with working interest gas volumes averaged 112.3 million metric standard cubic feet per day (MMscfd), 30 percent of processed gas used for electricity in Nigeria.
“In 2023, the company committed $11.5m towards projects that will end routine flares in its operations, including $10.8m towards installing gas compression facilities at the flow stations in Amukpe, Oben and Sapele, and $0.7m towards incineration at the Amukpe flow station.
“With a significantly high indigenous workforce of 98 per cent, Seplat Energy seeks to ensure there is a positive multiplier effect on the local economy through significant local content spend, enhancing the Company’s local supply chain and contributing to a thriving and competitive local market”.
Seeking to use local business partners has also simultaneously reduced Seplat Energy’s operating costs and project risks by developing a mutually beneficial relationship with the Company’s local partners, the Leadership Newspaper said.
The media group also commended Seplat Energy award of the ISO 55001 Asset Management certification, which now subjects the company to annual surveillance audits in 2023 and 2024 and a recertification audit in April 2025 in line with ISO 55001 3-yearly certification renewal cycle.
The Chairman, Leadership Group, Mrs. Zainab Nda-Isaiah, earlier in her remarks, said the conference and awards provided an exceptional platform in setting the agenda and offering solutions to many of the country’s problems and to reward excellence in business and politics.
The keynote address of the event was delivered by the former deputy governor of the Central Bank of Nigeria (CBN) and renowned political economist, Prof. Kingsley Moghalu.
Commenting on the awards, the Director, External Affairs & Social performance, Chioma Afe, thanked the Leadership Group for the honour and recognition. She said: “Seplat Energy has a sustained ability to deliver growth across board and will continue to create the needed value for all its stakeholders. Today, we are challenged by this award to continue to do and give more as a Company.” •
Eni: President Mattarella Visits the Company’s Projects in Côte d’Ivoire
San
Donato Milanese (Milan), Eni today welcomed the President of the Italian Republic Sergio Mattarella at its facilities in Abidjan. The meeting comes as part of President Mattarella’s first State visit to Côte d’Ivoire.
The President visited a gas transportation facility along the road to Grand Bassam. Gas produced from the Baleine field is fed into the Ivorian energy grid, powering electricity generation in the country.
The Baleine field was discovered by Eni in 2021 and production started in 2023. The Baleine project helps ensure the population has access to energy and strengthens Côte d’Ivoire’s position as a regional energy hub. It is the first net-zero Upstream (Scope 1 and 2) development project in Africa: emissions from production facilities are minimized using the best available technologies, and residual emissions are offset by leveraging innovative initiatives.
President Mattarella’s visit then continued at the Vridi school complex, located in the municipality of Port-Bouët, renovated by Eni in collaboration with the Ministry of National Education and Literacy of Côte d’Ivoire. This initiative is part of a project to support access to education involving 20 public schools, benefiting some 8,500 students and 150 teachers. •


58
NEWS - AFRICA
INTERNATIONAL SCIENTIFIC & EXPERT MEETING OF GAS PROFESSIONALS
CROATIA, 8 - 10 MAY 2024


JOIN THE LARGEST CONFERENCE & EXHIBITION IN SE EUROPE 100 % DEDICATED TO NATURAL GAS, LNG & LOW-CARBON SOLUTIONS!
60+ speakers / 600+ high ranking gas and energy experts, managers and decision makers / 20+ partners / 40+ exhibitors
1. Developments in the Natural Gas Market and Future Expectations on the Path to a Reliable and Low-Carbon Energy System
2. Crucial Role of Gas in the Energy Transition: Renewable Gases and Low-Carbon Gases as Key Complements to Renewables
3. New Gas Exploration and Production and Infrastructure Development Projects for Ensuring Security
4. Gas Industry Innovation By Embracing Diversity, Equity and Inclusion and Investing in the Next Generation of Energy Leaders
5. Decarbonising the Gas Value Chain: Reduction of Methane Emissions and the Application of CCUS in the Gas Industry
Confirmed key speakers:
• Marko Babić, Siemens Energy d.o.o.
• Tomislav Baketarić, INA-Industrija nafte d.d.
• Klaus Payrhuber, INNIO Jenbacher GmbH & Co OG
• Jan Sietsma, Macel plin d.o.o.
• Laslo Farkas Višontai, Podzemno skladište plina d.o.o.
6. Current Status and Perspectives for LNG Development and Expanding LNG Use in Europe
7. Digital Transformation of the Gas and Energy Industry in the Era of Decarbonization
8. Natural Gas and Renewable Gases as Sustainable Transportation Fuels
9. Developing the Hydrogen Economy: Challenges and Actions Needed to Scale Hydrogen
10. Improvements in the Gas Transport, Distribution and Storage Systems for Increased Safety, Efficiency and Sustainability
11. Legislation, Technical Regulations, Rules of the Profession and Consumer Rights in the Gas and Energy sector
12. Poster Session: Issues Related to the Gas and Energy Industry

• Brett Henkel, Svante Technologies lnc.
• Mihovil Galić, LNG Croatia LLC
• Marin Sabolek, Plinacro d.o.o.
• Barbara Diaz, Automa Srl
• Luka Klancir, Feromihin
• Eric Six, Heath N/A

Pre-event matchmaking tools and on-site social events will help delegates to network and meet international delegates and key speakers.
CHECK OUT
THE PROGRAMME: programme/
MAIN PARTNER:
Croatian Gas Center Ltd., Ulica Vjekoslava Heinzela 9/II, 10000 Zagreb, Croatia, phone: +385 (0)1 6189 590, e-mail: opatija@hsup.hr REGISTER NOW: TH
39
TH
OPATIJA,
MEMBER OF
Sasol and Transnet Announce Major Rail Transport Partnership

Sasol and Transnet Freight Rail (TFR), an operating division of Transnet SOC Ltd. (Transnet) and owner of South Africa’s railway, ports and pipeline infrastructure, today announced a first-of-its-kind public-private partnership to improve rail transport reliability in South Africa.
Under the five-year agreement, Transnet will deliver ammonia from Sasol’s Secunda and Sasolburg facilities to the company’s customers through a dedicated fleet of 128 ammonia tankers. In turn, Sasol will fund Transnet’s maintenance and repair programme for the fleet.
“Sasol’s partnership with Transnet is an investment in South Africa’s rail infrastructure network, a critical economic driver for the country and a key business enabler for Sasol,” said Sasol Vice President for Base Chemicals, David Mokomela. “The result will improve service to our customers and give us the transport capacity and reliability we need to respond to growing market demand. As one of South Africa’s largest companies, we are proud of this public-private partnership, which signals progress in advancing the country’s growth objectives.”
“This strategic partnership with Sasol demonstrates what is possible through collaboration and partnership—a foundational element of TFR’s Response Strategy,” said Acting TFR Chief Executive Russell Baatjies. “We appreciate Sasol’s support of this deal. It is a significant step toward addressing the industry’s current capacity challenges and protecting the ammonia rail supply—a critical material used in South Africa’s agriculture, mining and chemical markets,” he added.
TFR and Transnet Engineering (TE), who will execute the Sasol ammonia fleet’s maintenance and repair work, expect additional revenue generation from anticipated increased haul volume and the Sasol-funded maintenance and repair work.
TFR, which is Transnet’s largest Operating Division, provides the rail network infrastructure and operates rail services across major corridors to transport a broad range of bulk and general freight commodities, including mining, agricultural, manufacturing goods, bulk liquids, containerised freight and automotive units and components for export, regional and domestic markets. Freight Rail is recognised as a heavy haul rail operator for coal and iron ore on export lines and recently extended this capability to export manganese on the iron ore and Gqeberha lines. The Freight Rail network and rail services provide strategic links between ports, freight terminals and production hubs.
Sasol Chemicals produces and sells more than 540 000 tonnes
of ammonia annually. It is used to make a variety of fertilisers and industrial chemicals for the agriculture, mining, textile, and metalworking industries. •
The President of Côte D’ivoire Alassane Ouattara and The Ceo of Eni Claudio Descalzi Announce a Major Discovery in Block Ci-205, Offshore Côte D’ivoire
The discovery, named Calao, stands as the second largest in the country, following the Baleine field discovered by Eni in September 2021
Abidjan (Côte d’Ivoire), The President of the Republic of Côte d’Ivoire Alassane Ouattara and the Chief Executive Officer of Eni Claudio Descalzi met in Abidjan today to discuss the company’s activities in the country, including the successful results of the exploration well Murene 1X on the discovery named Calao. The Prime Minister Robert Beugré Mambé and the Minister of Mines, Petroleum, and Energy, Mamadou Sangafowa-Coulibaly, also participated in the meeting.
The Calao discovery was greeted as a significant one. Drilling operations took place approximately 45 kilometers off the coast in block CI-205, reaching a depth of 5,000 meters in water depths of around 2,200 meters. The well encountered light oil, gas, and condensates in various intervals of Cenomanian age characterized by good to excellent permeability values. Preliminary assessments indicate potential resources ranging between 1 and 1.5 billion barrels of oil equivalent. Eni operates the block in partnership with Petroci Holding.
President Ouattara and Mr. Descalzi discussed the appraisal and development plans for the discovery, including Eni’s commitment to meet the country’s domestic needs.
Eni operates in Côte d’Ivoire since 2015. In addition to block CI-205, Eni holds participating interests in five other blocks in Ivorian deep waters: CI-101, CI-401, CI-501, CI-801, and CI802, all in partnership with Petroci Holding. Presently, Eni has an equity production of hydrocarbons totaling approximately 22,000 barrels of oil equivalent per day from the Baleine field, which started production in August 2023. •


60 NEWS - AFRICA












June 11-13, 2024 Calgary, Alberta

30,000+ ATTENDEES
500+ EXHIBITING COMPANIES
400+ PRESENTING SPEAKERS
8 AWARD CATAGORIES
Join over 500+ Exhibiting Companies from:
• Government Entities
• Service & Supply Companies
• Gas & LNG
• Integrated Energy Companies
• Transmissions & Distribution
• Refineries & Maintennance
• Clean Technology Companies
• Power Generation & Utilities
• Technology Providers
• Legal & Industry Analysts
• National & International Oil Companies
• Financers & Investors


BOOK A BOOTH AT CANADA’S NATIONAL ENERGY EVENT
SCAN TO LEARN MORE globalenergyshow.com
MAIN HALL 85% SOLD OUT
The President of the Republic of the Congo, the Chairman of the Board of Directors of Eni and the CEO of Eni Celebrate Congo’s first LNG cargo


Pointe Noire (Republic of the Congo), In the occasion of the first shipment of LNG from the Republic of the Congo, the President of the Republic of the Congo Denis Sassou-N’Guesso, the Chairman of the Board of Directors of Eni Giuseppe Zafarana, and the CEO of Eni Claudio Descalzi celebrated the successful start-up of LNG production in the country. With the first cargo, the Republic of the Congo enters the group of LNG exporting countries, opening up opportunities for economic growth while contributing to global energy balance.
Eni CEO Claudio Descalzi commented that: “The first cargo of LNG from Congo is the result of the strong commitment of Eni and its partners and of the unwavering support of the Government of the Republic of the Congo. Eni and the local partners shared work forces, know-how and technologies, ensuring additional revenues to the country while contributing to Europe’s energy security.”
The Congo LNG project, sanctioned in December 2022, came on stream after just 1 year, in line with the initial timeline: an achievement made possible by Eni’s distinctive phased and parallelized approach and its highly efficient execution plan. The first LNG cargo is currently being loaded and will sail to Piombino’s regasification terminal, in Italy, in the coming days.
The project, situated within the Marine XII permit, will achieve a plateau gas liquefaction capacity of approximately 4.5 billion cubic meters per annum and will mark zero flaring from operated activities in country. The volumes will be marketed by Eni, strengthening and expanding the company’s LNG portfolio, and supporting efforts towards energy security and transition.
Eni is present in Congo since 1968 and is the only company active in the development of the country’s gas resources: it
currently supplies gas to the Centrale Électrique du Congo (CEC), which provides 70% of the country’s power generation capacity. Eni is strongly committed to promoting the energy transition in the country through several initiatives, including the Oyo Center of Excellence for Renewable Energy and Energy Efficiency, promoted and supported by Eni and managed by the Ministry of Higher Education, Scientific Research and Technological Innovation of the Republic of the Congo together with UNIDO (United Nations Industrial Development Organization). In addition, Eni is including Congo in the value chain of sustainable mobility through the production of agrifeedstock for biorefining, and promotes clean cooking initiatives, to reduce biomass consumption and the emissions associated with combustion. •
At CERAWeek in Houston, GCEO NNPC Ltd Kyari Meets IOC Chiefs ...Lauds President Tinubu’s Executive Order Promoting Oil & Gas Investment in Nigeria.
Onthe sidelines of the ongoing CERAWeek 2024 Conference taking place in Houston, United States, GCEO NNPC Ltd, Mr. Mele Kyari, on Wednesday held an engagement with the leadership of International Oil Companies (IOCs) operating in Nigeria.
During the meeting, Kyari expressed gratitude to President Bola Ahmed Tinubu for the Presidential Executive Order on Oil & Gas aimed at fostering investment in the Oil & Gas Industry and positioning Nigeria as the preferred investment destination for the sector in Africa.
The partners collectively acknowledged the Executive Order’s significance and the substantial value it has brought to the sector.
It will be recalled that on March 6th, 2024, President Tinubu executed Policy Directives aimed at not only enhancing investment climate in Nigeria, but also positioning Nigeria as the premier investment destination for the oil & gas sector in Africa.
Notable partners present at the engagement included Shane Harris, Chairman/MD ExxonMobil; Fabrizio Bolondi, Vice Chairman/MD ENI; Jim Swartz, Vice President Capital Projects Chevron; Rick Kennedy, Chevron; Osagie Okunbor, MD Shell Petroleum Company of Nigeria Ltd; and Matthieu Bouyer, MD/ CEO TotalEnergies Upstream Companies in Nigeria. •


62
NEWS - AFRICA



We will help you to clear things up! Meet our portable ballast water treatment containers. High flow rate, low power consumption. A 20ft container with a filterless active substance, USCG/IMO approved BWTS, reducing carbon footprint and cost per cubic meter. Ideal for barges, FPSOs, jack-ups, drill rigs and semi-subs. Contact us on info@uniballast.nl www.uniballast.nl OUR PORTABLE


WATER
BALLAST
SOLUTIONS ARE PURE AND SIMPLE
Upstream Asset Management Summit Paves the Way for Sustainable Energy Solutions

KOTA
KINABALU, Malaysia Petroleum Management (MPM), PETRONAS, in collaboration with Kuala Lumpur Section of the Society of Petroleum Engineers, launched the Upstream Asset Management Summit (UAMS) 2024, a threeday event, that serves as a platform for industry leaders, experts, and service providers to exchange knowledge, experiences, and best practices in managing oil and gas assets.
The summit, which takes place from 4-6 March 2024, features a comprehensive programme including 52 technical presentations and panel sessions that covers, among others, topics such as resource sustainability and asset reliability as well as the Oil and Gas Services and Equipment providers’ role in supporting the industry.
A dinner was also held in conjunction with the summit, attended by Sabah Minister of Finance Datuk Seri Panglima Masidi Manjun, alongside senior government officials as well as leaders of oil and gas industry players.
Datuk Seri Panglima Masidi said, “I extend my heartfelt gratitude to MPM for selecting Sabah as the venue for the UAMS as it underscores Sabah’s growing significance in the region’s energy landscape. It’s a testament to our commitment towards sustainable development and upskilling of Sabahan talents, and I am confident that this summit will foster meaningful dialogue and collaborations for the benefit of the broader industry.”
PETRONAS Senior Vice President of MPM, Datuk Ir Bacho Pilong said, “We are delighted to see a great turnout for today’s summit, bringing together key stakeholders and industry players to address the challenges and seize opportunities in the Upstream sector. This gathering solidifies our commitment in driving sustainable management of our nation’s petroleum resources through innovative solutions and collaborative efforts with the State Government and stakeholders across the industry.
Building upon this commitment, Datuk Ir Bacho Pilong, together with PETRONAS Chief Sustainability Officer, Charlotte WolffBye, convened an executive roundtable on the same day with petroleum arrangement contractors in Malaysia. Recognising the need to mitigate methane emissions, the roundtable focused on fostering collaboration and partnerships in support of achieving near zero methane emission levels. Attendees also shared updates on existing collaborations and explored practical approaches in reducing emissions within the Malaysian oil and gas value chain.
Since its inception in 2015, UAMS (formerly known as Reservoir Management & Surveillance Summit -RMSS) has been instrumental in optimising oil and gas production by fostering the exchange of insights and strategies.
The 2022 edition of the summit drew participation of over 200 industry leaders and experts. This year, the event experienced a notable surge in popularity attracting more than 300 attendees. •
Built By CNPC, Bangladesh’s First Mega Sea-Land Oil Storage and Transportation System put into Operation
Thefirst batch of diesel and crude oil delivered by Chinesebuilt pipeline arrived at the Eastern Refinery Limited (ERL), a subsidiary of Bangladesh Petroleum Corporation (BPC). Connecting the tank farm and the refinery, the pipeline is a part of the dual-channel Single Point Mooring (SPM) system built by China Petroleum Pipeline Engineering, a subsidiary of CNPC. This marks the launch of Bangladesh’s first sea-land integrated super-large oil storage and transportation system.
As a flagship project in Bangladesh’s endeavor to achieve its Vision 2041, the facility is a major achievement in the energy cooperation between China and Bangladesh under the Belt and Road Initiative (BRI). The completion of the project marks the end of oil shipping by barge, shortening the oil unloading and transportation time from 11 days to about 48 hours for 100,000ton oil tankers, and providing a solid guarantee for expanding ERL’s processing capacity from 1.5 MTPA to 4.5 MTPA.
Md Sharif Hasnat, Deputy General Manager of ERL, commented, “This project will have a huge impact on our energy production. In terms of oil unloading, our previous approach was inefficient and costly. With the introduction of the sea-land integrated oil storage and transportation system, modern oil transportation facilities will make our energy production more efficient and create more opportunities to expand ERL’s production capacity. These efforts will ultimately benefit Bangladesh.”
Among the first batch of major oil and gas storage and transportation facilities in Bangladesh under the BRI, the project created nearly 4,000 jobs for the country during its construction, and nurtured many outstanding technical talents for the local communities. •


64 NEWS - ASIA PACIFIC


PTTEP Organizes 2024 Annual General Shareholders’ Meeting as Sustainable Event
Mr. Krairit Euchukanonchai (center), Chairman of the Board of Directors, PTT Exploration and Production Public Company Limited (PTTEP), together with directors, and Mr. Montri Rawanchaikul (6th from left), Chief Executive Officer of PTTEP, convened the 2024 Annual General Meeting of Shareholders (AGM) to report the company’s performance of 2023, the progress of operational activities in achieving Net Zero Greenhouse Gas Emissions by 2050, and investment plan. The meeting approved the dividend payment for 2023 at the rate of THB 9.50 per share.
Fostering the approach of “Sustainable Event” by maximizing resource utilization and minimizing environmental impact, PTTEP organized the meeting entirely online for the 2nd consecutive year to mitigate energy consumption associated with participants’ commutes and reducing the usage of resources. Additionally, PTTEP Annual Report 2023 was presented in digital format. •
Morocco successfully commercializing a broad range of both oral and injectable formulations covering diverse therapy areas including diabetes, oncology, cardiology, and central nervous systems.
The acquisition is set to boost the UAE’s global standing in life sciences. With Kelix bio specializing in relevant therapy areas and a leadership team experienced in successful buy-and-build strategies globally, the move aligns with Mubadala’s goal to position the UAE prominently in the global life sciences sector.
Dr. Bakheet Al Katheeri, Chief Executive Officer of Mubadala’s UAE Investments Platform, said: “In line with our role as a responsible investor, today’s acquisition is testament to the role Mubadala continues to play in accelerating the nation’s economic diversification through our portfolio companies and national champions.”
He added: “This partnership marks a key milestone in further advancing Mubadala’s position in the life sciences sector, to deliver important long-term socio-economic returns for our nation including improved healthcare, drug security, job creation and GDP impact.”
Ismail Ali Abdulla, Head of UAE Clusters, at Mubadala’s UAE Investments Platform said: “At Mubadala, we are deeply committed to enhancing the well-being of our communities through strategic investments that address critical health care needs. By amplifying our domestic capabilities in producing essential medications via Kelix bio, our goal is to significantly empower the UAE’s healthcare infrastructure, ensuring wider access to life-saving treatments for all citizens. This investment is a testament to our dedication as a responsible investor, emphasizing our commitment to investing in solutions that address the world’s most pressing challenges.”
Mubadala Acquires KELIX Bio to Further Advance UAE’s Life Sciences Ecosystem and Expand its Footprint in the Sector
• Mubadala supporting UAE’s vision to become a global leader in the life sciences sector.
• The acquisition of KELIX bio will reinforce the UAE’s biopharma ecosystem and increase Mubadala’s presence regionally and globally.
Mubadala Investment Company PJSC (Mubadala), an Abu Dhabi sovereign investor, has entered into a definitive agreement to acquire KELIX bio, a specialty pharmaceutical business focused on delivering complex generics across emerging markets, to further strengthen the development of the UAE’s life sciences ecosystem, position the UAE as a global leader in the life sciences sector and to support the diversification of the economy in the UAE.
KELIX bio was incepted in November 2020, and has since, acquired manufacturing businesses in India, Egypt, Malta and

Hocine Sidi-Said, co-founder, and Chief Executive Officer at KELIX bio commented:“We are immensely grateful to our previous shareholders for their faith in our vision and for supporting a fast-paced acquisition program since inception. With Mubadala’s acquisition of KELIX bio, we embark into an exciting journey that promises to deliver not only economic returns but also cause a durable societal impact in the United Arab Emirates. We are excited to augment the manufacturing capabilities of the nation and drive an innovation agenda in diabetes, oncology, and biologics to name a few.” •

66 NEWS - ASIA PACIFIC

Yinson Production’s FPSO Atlanta Sets Sail to Brazil

Yinson Production’s FPSO Atlanta set sail to Brazil today, marking the successful completion of the project execution phase, and is expected to arrive in the Atlanta field in the Santos Basin offshore Brazil during the second quarter 2024. The sail away follows the grand naming ceremony that was held for the FPSO in December 2023.
FPSO Atlanta is a redevelopment project awarded to Yinson Production by Enauta Energia S.A. (“Enauta”) on 21 February 2022 as an EPCI (“Engineering, Procurement, Construction, Installation”) Project. In July 2023, Yinson Production exercised its option to purchase FPSO Atlanta, which includes a 15-year firm plus a 5-year option contract for the supply and operations & maintenance with a total contract value of up to USD 1,981 million. FPSO Atlanta has a production capacity of 50,000 barrels of oil per day and a maximum storage capacity of 1,200,000 barrels. The FPSO features an efficient carbon management process plant, which utilises fuel gas for cargo tank inertisation that will significantly reduce flare gas emissions through a closed flare system. The plant is part of Enauta and Yinson Production’s continuous efforts in reducing carbon emissions and being the frontrunner in decarbonising the FPSO industry towards the goal of net zero.The project, carried out at Drydocks World Dubai, was completed safely with over 9 million man-hours without lost time incident. The safety performance is an excellent achievement for the project, demonstrating the highest level of safety standards by the project team.
Scott Bendiksen, FPSO Atlanta Project Manager said, “With over 9 million-man hours worked without a lost time incident, safety has remained our top priority throughout every phase of the project. We look forward to seeing FPSO Atlanta contribute to Enauta’s operations in the Santos Basin, further solidifying our position as a trusted partner in the offshore energy sector.”
Vinicíus Passos, Enauta’s Executive Deployment Manager said, “This is one more milestone achieved, which marks the successful conclusion of FPSO Atlanta’s adaptation phase, with the aim of delivering the project on time and within budget. More than 2 years without any incident demonstrates the highest level of safety standards by the team that worked on adapting the vessel.”
FPSO Atlanta is the second of three FPSOs Yinson Production is delivering to clients in Brazil. The first vessel, FPSO Anna Nery, is already operational after achieving first oil in May 2023, while the third FPSO is currently under being built in China and progressing well towards completion this year. •
CNPC’s Deep-Earth borehole Drilling Exceeds 10,000 Meters
InTarim Oilfield, the drilling of Shenditake-1 well exceeded 10,000 meters. As China’s first scientific exploratory borehole designed to reach such depth, it set a new record of the deepest well in Asia, and demonstrated China’s world-leading technologies in deep-Earth drilling and exploration of 10,000 meters.
Located in the hinterland of the Taklimakan Desert in Xinjiang Uygur Autonomous Region, Shenditake-1 well started drilling on May 30, 2023, with a designed depth of 11,100 meters.
From surface to 10,000 meters downhole, the drilling of Shenditake-1 well faces complicated and changeable geological conditions, as well as continental strata with various lithology and pressure systems. To cope with extreme high temperature and pressure, PetroChina Tarim Oilfield Company, CNPC Xibu Drilling Engineering Company, CNPC Baoji Oilfield Machinery Company and other partners carried out joint research and developed a series of key core technologies, such as the world’s first automated drilling rig for 12,000-meter wells, the 220°C super-high temperature drilling fluid, high temperature resistant screw, inclinometer etc. Moreover, the 175 MPa ultra-high pressure fracturing truck and fracturing fluid system were also developed and tested on-site with success.
Currently, deep and super-deep onshore reservoirs account for 34% of China’s total hydrocarbon resources, and an increasing proportion of newly added reserves. The Tarim Basin, where the Shenditake-1 well is located, is the only petroliferous basin in the world with mainly super-deep reservoirs, and also the largest deep-Earth hydrocarbon area in China.
In recent years, CNPC vigorously implemented the “deep-Earth drilling project” in the Tarim Basin, and successfully drilled more than 140 “underground Everests”, each with a depth of more than 8,000 meters. In 2023, Tarim Oilfield Company produced 19.57 million tons of oil and gas from super-deep reservoirs in the Tarim Basin, making it the largest super-deep oil and gas production base in the country. •


68 NEWS - ASIA PACIFIC

Our PWC® technology has evolved, now delivering verified well barriers without a rig in sight. A generation of invention Engineered with purpose. Installed with confidence. www.hydrawell.com

Yinson Production Holds Naming Ceremony for FPSO Maria Quitéria
• Yinson Production held the naming ceremony for FPSO Maria Quitéria at Cosco Shipping Heavy Industry (Shanghai) Shipyard in China on 3 April 2024
• FPSO Maria Quitéria project was awarded to Yinson Production in November 2021
• The FPSO will be deployed in the Jubarte field as part of the Parque das Baleias Integrated Project offshore Brazil for Petróleo Brasileiro S.A. under a 22.5-year lease and operate contract with a total contract value of up to USD 5.3 billion
Yinson Production has officially named FPSO Maria Quitéria during a grand naming ceremony held at Cosco Shipping Heavy Industry (Shanghai) Shipyard in China on 3 April 2024.
The naming ceremony was graced by Lady Sponsor Lim Chern Fang. Also in attendance were Yinson Production’s Chief Executive Officer, Flemming Grønnegaard, and Project Manager for FPSO Maria Quitéria, Noel Denton, Petróleo Brasileiro S.A. (“Petrobras”) Contract Manager, Tiago Pace Estefen, Cosco Shipping Heavy Industry General Manager, Jiang Jijiang, alongside members of the boards of directors, senior management and representatives of Yinson Production, Petrobras and Cosco as well as financiers and key vendors.
FPSO Maria Quitéria is a conversion project with a production capacity of 100,000 barrels of oil per day and a storage capacity of 1,000,000 barrels. The vessel will be the first FPSO in Yinson Production’s fleet to operate heat recovery steam generation (“HRSG”) as part of its combined cycle power generation system. HRSG is one of several technologies that we are implementing across our fleet, in line with our continuous efforts in reducing carbon emissions and being the frontrunner in decarbonising the FPSO industry towards the goal of net zero.
Yinson Production was awarded the FPSO Maria Quitéria project by Petrobras in November 2021 and the conversion works commenced on 25 January 2022. The project has been progressing according to schedule, with all topside modules onboard and integrated, and commissioning underway. Sail away to Brazil will be in the second quarter of 2024 and the asset will be deployed at the Jubarte field located in the northern part of the Campos Basin, offshore Brazil.
FPSO Maria Quitéria is Yinson Production’s third FPSO destined for Brazil, following FPSO Anna Nery, which has been operating for Petrobras since May 2023, and FPSO Atlanta, which is expecting first oil in summer this year and will operate for Enauta Energia S.A. •
PTTEP Ramps up G1/61 Gas Production to 800 MMSCFD Alleviate the Impact of Energy Prices
Bangkok,
PTTEP today ramps up the G1/61 Project’s sales volume to 800 million cubic feet per day (MMSCFD) as planned. The increased gas delivery will help minimize the impact of electricity price and enhance national energy security.
Mr. Montri Rawanchaikul, Chief Executive Officer of PTT Exploration and Production Public Company Limited (PTTEP), said that PTTEP won the bid for the G1/61 in the Gulf of Thailand from the Department of Mineral Fuels in 2018 and signed the Production Sharing Contract (PSC) in 2019. After becoming the operator, PTTEP put all efforts into speeding up the production rate and improving the integrity of facilities and equipment to ensure safety. To date, 12 wellhead platforms and subsea pipelines were installed, along with the drilling campaign of more than 300 producing wells. The gas delivery is increased to 800 MMSCFD on March 20, 2024, to serve the energy demand and support Thailand’s economy.
“Increasing natural gas delivery from the G1/61 Project has been PTTEP’s priority over the past 2 years. As gas from the Gulf of Thailand is a primary source of energy serving both households and industries, PTTEP, therefore has accelerated all operations to ramp up the production. Today, the G1/61 project starts to produce natural gas at 800 MMSCFD. The achievement is attributed to the determination of all employees and supports from the government and related agencies to not only mitigate the impact of energy prices but also sustain energy security for the country,” Mr. Montri said.
PTTEP will continue annual workplan by installing new 8 wellhead platforms and drilling more than 300 producing wells for G1/61 project. For 2024, the investment worth approximately THB 30,000 million has been set aside to carry on the project as one of the primary energy sources for the country’s energy security in the long term. •


70 NEWS - ASIA PACIFIC

In the Presence of H.E. Saleh Al-Jasser Bahri Lays Cornerstone for Logistics Center at Jeddah Islamic Port

Jeddah, KSA – In the presence of H.E. Eng. Saleh bin Nasser Al-Jasser, Minister of Transport and Logistics Services and Chairman of the Saudi Ports Authority, the National Shipping Company of Saudi Arabia (Bahri) today laid the cornerstone for the establishment of a logistics center at Jeddah Islamic Port. The ceremony was also graced by Omar Hariri, President of the Saudi Ports Authority (Mawani) and Eng. Ahmed Ali Al-Subaey, CEO of Bahri.
This state-of-the-art facility, which will cover a total area of 95,436 square meters, will be managed by Bahri Logistics. It will offer multiple storage options in temperature-controlled areas, handling services, and other value-added services, with the aim of enhancing logistics capabilities and supply chain in the Kingdom of Saudi Arabia, enabling multinational companies to establish their logistics hubs in the Center.
Omar Hariri emphasized the pivotal role of the Bahri Logistics Center as a key component in Mawani’s efforts to strengthen the maritime transport and logistics sector, in line with the National Transportation and Logistics Strategy (NTLS).
This project highlights Mawani’s commitment to enhancing the infrastructure and capabilities of Saudi Arabia’s logistics sector, contributing actively to economic growth and efforts to boost non-oil exports, as outlined in the nation’s ambitious vision.
Eng. Ahmed Ali Al-Subaey expressed his enthusiasm for cooperating with Mawani and Zakat, Tax and Customs Authority (ZATCA) to establish this cutting-edge logistics facility. He emphasized its potential to significantly impact the national, regional, and global logistics sectors. “Beyond enhancing our capabilities and positioning us favorably in the global logistics sector, the Bahri Logistics Center will allow us to capitalize on new opportunities, substantially enriching our role in elevating Saudi Arabia’s status as a global logistics hub,” he explained.
Expected to be operational in the first half of 2025, the Bahri Logistics Center will offer exceptional storage and handling capabilities with over 80,000 pallet positions, 40,000 shelving units, and an annual throughput exceeding 900,000 pallets. The facility will be equipped to store reefer, insulated, and dry containers. It will also provide a wide range of services to its customers, such as container maintenance, repair, and cleaning, bonded storage, and haulage. •
ADNOC Signs Second Long-Term Heads of Agreement for Ruwais LNG Project

15-year
LNG supply agreement with SEFE for 1 mmtpa reinforces ADNOC’s position as a reliable global natural gas provider
LNG agreement demonstrates UAE-German Energy Security and Industry Accelerator in action, advancing cooperation in energy security, decarbonization and lower-carbon fuels
Set to be one of the lowest-carbon intensity LNG facilities in the world, the Ruwais LNG project will leverage the latest technologies and AI tools to lower emissions and drive efficiency
Abu Dhabi, UAE – March 18, 2024: ADNOC announced today the signing of a 15-year Heads of Agreement (LNG agreement) with SEFE Marketing & Trading Singapore Pte Ltd., a subsidiary of Germany’s SEFE Securing Energy for Europe GmbH, for the delivery of 1 million metric tonnes per annum (mmtpa) of liquefied natural gas (LNG).
The LNG will primarily be sourced from ADNOC’s lowercarbon Ruwais LNG project, currently under development in Al Ruwais Industrial City, Abu Dhabi. The Ruwais LNG plant has been designed to run on clean power and will leverage the latest technologies and Artificial Intelligence (AI) tools to drive efficiency. This is the second long-term LNG supply agreement from the Ruwais LNG project, following the 15-year agreement with China’s ENN Natural Gas signed in December 2023. The deliveries are expected to start in 2028, upon commencement of the facility’s commercial operations.
Fatema Al Nuaimi, Executive Vice President, Downstream Business Management at ADNOC said: “This LNG agreement, the first with a European company from the Ruwais lowercarbon LNG project, underscores ADNOC’s position as a reliable and responsible global energy provider. Gas accounts for almost a quarter of Germany’s primary energy use, and we look forward to supporting its efforts to diversify its energy sources and enhance its energy security.”
This LNG supply agreement reinforces the Energy Security and Industry Accelerator (ESIA) agreement, signed by the UAE and Germany in 2022, further strengthening bilateral cooperation in energy security, decarbonization and climate action. It builds upon ADNOC’s delivery of the first LNG cargo from the Middle East to Germany in 2023. •

72 NEWS - MENA
Hughes Safety Showers is a premier manufacturer of emergency safety showers and eye/face wash equipment.
Our award winning, carbon saving option for emergency tank showers will temper the water within the tank in hot ambient climates, without the need for power!
Hughes Zero Power Cooler® provides you with a safer working environment, greater protection against serious injury and peace of mind that you’re compliant with crucial safety standards.
Delivering safety, from the essential to the exceptional.

The


Effectiveness independently verified

Get in touch. T: +44 (0)161 430 6618 E: sales@hughes-safety.com Models pictured L-R: External section of the Hughes Zero Power Cooler (Patent pending); 1500L jacketed emergency tank shower with eye wash, fitted with the Hughes Zero Power Cooler
emergency tank showers, without the need for power.
world’s first cooler for
TUV third party assessment.
by
Stay safe. Stay compliant.
Designed and developed in collaboration with: 2-5 October 2023 Visit stand #8430
In the Presence of H.E. Saleh Al-Jasser Bahri Lays
Cornerstone for Logistics Center at Jeddah Islamic

Jeddah,
KSA – In the presence of H.E. Eng. Saleh bin Nasser Al-Jasser, Minister of Transport and Logistics Services and Chairman of the Saudi Ports Authority, the National Shipping Company of Saudi Arabia (Bahri) today laid the cornerstone for the establishment of a logistics center at Jeddah Islamic Port. The ceremony was also graced by Omar Hariri, President of the Saudi Ports Authority (Mawani) and Eng. Ahmed Ali Al-Subaey, CEO of Bahri.
This state-of-the-art facility, which will cover a total area of 95,436 square meters, will be managed by Bahri Logistics. It will offer multiple storage options in temperature-controlled areas, handling services, and other value-added services, with the aim of enhancing logistics capabilities and supply chain in the Kingdom of Saudi Arabia, enabling multinational companies to establish their logistics hubs in the Center.
Omar Hariri emphasized the pivotal role of the Bahri Logistics Center as a key component in Mawani’s efforts to strengthen the maritime transport and logistics sector, in line with the National Transportation and Logistics Strategy (NTLS).
This project highlights Mawani’s commitment to enhancing the infrastructure and capabilities of Saudi Arabia’s logistics sector, contributing actively to economic growth and efforts to boost non-oil exports, as outlined in the nation’s ambitious vision.
Eng. Ahmed Ali Al-Subaey expressed his enthusiasm for cooperating with Mawani and Zakat, Tax and Customs Authority (ZATCA) to establish this cutting-edge logistics facility. He emphasized its potential to significantly impact the national, regional, and global logistics sectors. “Beyond enhancing our capabilities and positioning us favorably in the global logistics sector, the Bahri Logistics Center will allow us to capitalize on new opportunities, substantially enriching our role in elevating Saudi Arabia’s status as a global logistics hub,” he explained.
Expected to be operational in the first half of 2025, the Bahri Logistics Center will offer exceptional storage and handling capabilities with over 80,000 pallet positions, 40,000 shelving units, and an annual throughput exceeding 900,000 pallets. The facility will be equipped to store reefer, insulated, and dry containers. It will also provide a wide range of services to its customers, such as container maintenance, repair, and cleaning, bonded storage, and haulage. •
Aramco Awards $7.7 Billion Contracts to Add 1.5 bscfd of Raw Gas to Fadhili Gas Plant
• Company awards EPC contracts for development of Fadhili Gas Plant Increment
• Project to add up to 1.5 billion standard cubic feet per day to the capacity of the Fadhili Gas Plant
Aramco,one of the world’s leading integrated energy and chemicals companies, today awarded engineering, procurement and construction (EPC) contracts worth $7.7 billion for a major expansion of its Fadhili Gas Plant in the Eastern Province of Saudi Arabia. The project is expected to increase the plant’s processing capacity from 2.5 to up to 4 billion standard cubic feet per day (bscfd).
This additional 1.5 bscfd of processing capacity is expected to contribute to the company’s strategy to raise gas production by more than 60% by 2030, compared to 2021 levels. The Fadhili Gas Plant expansion, which is expected to be completed by November 2027, is also expected to add an additional 2,300 metric tons per day to sulphur production.
Wail Al Jaafari, Aramco Executive Vice President of Technical Services, said: “The award of these contracts reflects Aramco’s goal to increase supplies of natural gas, help efforts to reduce greenhouse gas emissions, and free up more crude oil for valueadded refining and export. Together with leading international companies, we are advancing our goal to increase gas production. The expansion also supports our ambitions to develop a lowercarbon hydrogen business, while associated liquids from gas are an important feedstock for the petrochemical industry.”
Aramco awarded EPC contracts for the Fadhili Gas Plant increment project to SAMSUNG Engineering Company, GS Engineering & Construction Corporation, and Nesma & Partners. •


74
NEWS - MENA
IMET was founded in 1988 and is today, one of the pioneering companies in the development and manufacturing of industrial safety radio remote controls.
Today, IMET can boast a very wide and articulated range of products, capable of suiting the majority of requirements inside the industry, the construction, agricultural sectors and many more. In addition to the standards models, which have been designed for the most traditional applications, such as construction cranes, bridge cranes, etc., the company places at the disposal of its customers a staff of technicians that is specialized in the design and creation of customized models of radio remote controls, according to specific requirements. The complete range of products include from the smallest to the biggest transmitters: RAY, WAVE2 S and L, AXT, ARES2, KRON, ZED, ZEUS2, THOR2, G4S and TITAN.
All IMET equipment is entirely designed and assembled in the Sacile plant, in Italy. It is then subjected to a series of intermediate checks and final tests, aimed at guaranteeing maximum reliability and compliance with current product and safety regulations. IMET has, in fact, its own laboratories and a fully equipped anechoic chamber with numerous test options and test instruments.
The propensity of the company towards careful planning of its resources, has allowed it to obtain the UNI ENI ISO9001 quality certification since 1998.
The remote controls designed by IMET are devices that are used where it is essential to physically separate the user from the machinery and to control the latter “remotely”, without the aid of a physical connection and using radio waves as a means of transmission. In all these contexts, the IMET product reveals high-reliability, stands-out for its safety, productivity and freedom of movement.
IMET introduced recently a new radio remote control range designed and realized in accordance with ATEX and IECEx Directives for environments with potentially explosive atmospheres. As a result of its features, the line can be safely used in areas classified as gas 1 and 2 zones, combustible dust 21 and 22 zones, and mines. Customisation is a proven bonus for IMET: each application is tailored to the customer’s needs, always in keeping with the relevant legis. The product and the production process with Notified Quality System by Eurofins Product Testing Italy S.r.l. (NB 0477), EN ISO IEC 80079-34, respect the most recent and high-safety standards. The new ATEX/IECEx version of KRON, ZEUS2 and THOR2 radio remote controls, models al-






ready with a consistent presence and proven functionality, allows now to operate in applications which were unthinkable before, where the operator may experiment a cutting-edge technology, together with the explosion proof rating.
The KRON model, designed for top performance with extremely small footprint, it is the ideal solution when the application requires no more than four single-axis joysticks. Equipped with a practical clip for quick coupling to the belt, you will be surprised how easy and effortless it is to use KRON, thanks to the design of its handle, which will make any work situation comfortable.
The ZEUS2 model, is a perfect mix of reliability and versatility combined in a single control station. ZEUS2 boasts top features in terms of ergonomics and functionality. Thanks to the compact size of the panel, with a rational distribution of spaces, the transmitter can be easily customised according to specific needs. Suitable for applications requiring up to 6 single-axis or 2 dual-axis joysticks, it is a masterpiece of technology that will enable you to smoothly supervise any operations.
THOR2 is the perfect combination of efficiency, ergonomics and a high degree of customisation. A supreme mix of design and functionality that make it rank at the top of its category even for explosion-proof uses. Up to 9 single-axis joysticks or 4 dual-axis ones on the main panel, with spacious side compartments. Numerous push buttons, toggle or rotary selector potentio meters make THOR2 a perfect choice for machi nes of any complexity.
A compact design, light-weight and simplicity of use, allow an excellent freedom of action and precision maneuvers for greater productivity, while ensuring the protection of your opera tors. The transmitter is powered by a specific rechargeable 3,6V battery, specially realized by IMET that can be used up to 40 hours on a single charge. The batteries can be replaced surely in hazardous environments.
The transmitters suitable for use in potentially explosive environments - such as the petroche mical, off-shore, recycling, chemical, pulverised products, mining, painting system industriesare available in different models and configura tions depending on the customer’s requirements and can be coupled to various receiving unit mo dels; in standard casing if the receiver is located outside an explosion risk area or, alternatively, in an explosion-proof case as appropriate. The radio remote controls in the ATEX version


are not only perfectly suited to a variety of applications but also render processes more efficient. Compact design, low weight, easy use and great battery life - offer exceptional freedom of action, precision operations and movements as well as greater productivity, without ever losing sight your operators’ safety.
There is also the explosion proof certified receiving units. They are mainly used for systems in duct pipe or with barrier cable glands, and can have applications on the walls such as control panels and signalling. They are built according to European regulations.
Today, IMET’s sale network covers 40 countries around the world and can boast a very wide and articulated range of products, capable of suiting the majority of requirements inside industrial automation, forestry & agriculture applications and recycling applications, etc.
IMET will continue to be flexible and to respond to new technology challenges and customer needs with products that can go along and adapt themselves quickly. At the same time, IMET will keep its well-known customer oriented attitude, which has been the main company driver and the reason of success!




s.r.l. 33077 Sacile (PN) Via Ronche, 93 - t. +39 0434 7878 - info@imet.eu - www.imet.eu MADE IN ITALY
Global partner for innovation
$500 Million
in
Value Generated
by
ADNOC through Deployment of AI Solutions in 2023

Over 30 AI tools have unlocked significant value across ADNOC’s full value chain, from field operations to smarter and quicker corporate decision-making
Deployment of AI tools abated up to 1 million tonnes of CO2 emissions between 2022 – 2023
Milestone marks start of a multi-year program to accelerate deployment of AI solutions across ADNOC’s value chain
Abu Dhabi, UAE – March 5, 2024: ADNOC announced today that it generated $500 million (AED1.84 billion) in value by deploying artificial intelligence (AI) solutions in 2023.
The value was generated from the integration of over 30 industryleading AI tools across ADNOC’s full value chain, from field operations to smarter and quicker corporate decision making. Together, these applications also abated up to 1 million tonnes of carbon dioxide (CO2) emissions between 2022 and 2023, the equivalent of removing around 200,000 gasoline-powered cars from the road.
The achievement is testament to ADNOC’s longstanding strategy to develop and deploy pioneering technologies such as AI, robotic automation, and advanced data analytics. The milestone marks the start of a multi-year program to accelerate the deployment of a suite of AI solutions across ADNOC’s value chain to further enhance safety, while driving down emissions and driving up value.
His Excellency Dr. Sultan Ahmed Al Jaber, Minister of Industry and Advanced Technology and ADNOC Managing Director and Group CEO, said: “Artificial intelligence is one of the most important economic and social game changers of our era and it can play a crucial role in accelerating a just, orderly and equitable energy transition. At ADNOC, we have integrated artificial intelligence across our operations, from the control room to the boardroom, and it is enabling us to make smarter decisions and better protect our people and the environment. As we grow our diversified portfolio to ensure secure, reliable and responsible supply of energy, we are further integrating AI to future-proof our business and drive greater and more sustainable value from our assets and resources.” •
The announcement was made at ADNOC’s Leadership Forum held at the Abu Dhabi Energy Center, where employees across the ADNOC Group gathered to discuss strategic priorities and initiatives as the company delivers on its mandate to transform, decarbonize and future-proof and ensure a secure, reliable and responsible supply of energy.
In ADNOC’s upstream operations, AI applications play a central role in mapping subsurface resources, optimizing drilling, production activity and smarter reservoir management. This enables ADNOC to quickly and efficiently grow its production capacity and ensure the continued delivery of lower-carbon intensity energy to the world.
Across upstream and downstream facilities, ADNOC’s Centralized Predictive Analytics and Diagnostics (CPAD) program harnesses AI to remotely monitor critical operational equipment. CPAD has drastically reduced the frequency of unplanned shutdowns and streamlined routine maintenance activity, while simultaneously improving operational efficiency to enable the production of maximum energy with minimum emissions.
AI is also supporting ADNOC’s net zero by 2045 ambition and its target to achieve near-zero methane emissions by 2030. Tools such as Emission X gather historic and real-time data from hundreds of sources on operational sites to accurately predict emission sources up to five years in advance, allowing operators to take preventative action. Emission X was developed by AIQ, a joint venture between ADNOC and G42 established in 2020 to drive an AI-powered transformation of the energy sector towards a more sustainable future.
Other AIQ products in operation at ADNOC’s facilities include SMARTi, an intelligent computer vision system that uses AI to detect safety hazards across industrial and operational environments. AR360 uses AI to visualize reservoirs and optimize development, reducing planning time and increasing well life and ultimate recovery rates. Robowell uses AI to remotely operate equipment like flow valves in upstream facilities, reducing cost, enhancing safety and increasing production capacity.
OPEC Daily Basket Price Stood at $90.29 a Barrel
Vienna, Austria, The price of OPEC basket of twelve crudes stood at $90.29 a barrel on Monday, compared with $91.12 the previous Friday, according to OPEC Secretariat calculations (view archives).
The OPEC Reference Basket of Crudes (ORB) is made up of the following: Saharan Blend (Algeria), Djeno (Congo), Zafiro (Equatorial Guinea), Rabi Light (Gabon), Iran Heavy (Islamic Republic of Iran), Basrah Medium (Iraq), Kuwait Export (Kuwait), Es Sider (Libya), Bonny Light (Nigeria), Arab Light (Saudi Arabia), Murban (UAE) and Merey (Venezuela). •

76 NEWS - MENA

OKEA and Partners take FID on Brasse Oil and Gas Field Offshore Norway

OKEA and its partners in the Brasse oil and gas project have made a final investment decision (FID). The Brasse field is located in the shallow waters of production licence 740 in Norway’s section of the North Sea, about 13km south of the Brage field.
It’s calculated that Brasse holds 24 million barrels of oil equivalent (boe) in recoverable reserves. The developers plan to explore it with a two-well subsea tieback to Brage, which is operational since 1993.
The next step for OKEA is to submit Brage’s plan for development and operation (PDO), which the company expects to do this month. Once this is approved, the project will be renamed to Bestla.
Operations are scheduled for the first half of 2027. •
JGC Corporation Secures FEED Contract for Green Hydrogen Project in Malaysia
JGCCorporation has been awarded a front-end engineering design (FEED) contract for ENEOS and Sumitomo’s green hydrogen and methylcyclohexane (MCH) project in Malaysia. The initiative is under development in partnership with SEDC Energy.
The plant, to be built in Bintulu, Sarawak, is planned to have a production capacity of over 90,000 tonnes of hydrogen per year. Most of this output will be exported to Japan to be used within the marine transportation industry.
The facility’s hydrogen production will be powered by renewable energy coming from hydroelectric power plants. •

Shell Chooses MODEC for Gato do Mato’s FEED Contract in Brazil
MODEC has been awarded a front-end engineering design (FEED) contract by Shell related to the Gato do Mato project offshore Brazil. According to the deal, MODEC will be responsible for the design of the hull and associated topsides of the floating, production, storage and offloading (FPSO) unit.
The Gato do Mato FPSO will be moored by a SOFEC spread mooring system, almost 250km off the coast. It will be tied at a water depth of approximately 2,000 metres.
Plans for Gato do Mato envisage the installation of an FPSO with oil and gas processing capacities of 90,000 barrels per day (b/d) and 8.5 million cubic metres per day (MMcm/d), respectively. The unit, which would have an oil storage capacity of 1.6 million barrels, would be linked to four production wells, four gas injection wells and two water injectors. •

India Launches Two New Nuclear Power Reactors at Krakapar
Two new nuclear reactor have been inaugurated in western India. The units, which have a combined capacity of 1.4GW, are additions to the Kakrapar atomic power station in Gujarat, and have been built by the Nuclear Power Corporation of India (NPCIL).
The total investment required for the conclusion of both reactors surpassed US$2.71bn. The new assets increase Krakapar’s total number of units to four, with a final capacity of 1.8GW.
Unit 3 has been operational since June 2023, with Unit 4’s commissioning following soon after in December. According to NPCIL, they are India’s largest pressurised heavy water reactors (PHRWs). •


78
NEWS - OIL AND GAS INDUSTRY NEWS FROM EIC
Making and Maintaining the Right Connection
Destec Engineering has specialised in the manufacture of high pressure Flanges, Seals & Connectors for the Oil, Gas & Renewable Energy Industries for over 50 years.



PRODUCTS WE DELIVER:
— Destec Compact Flanges
— DESALIGN Misalignment Flange
— G-Range 4 Bolt Connectors
— Compatible Seals
— GSB Subsea Single Bolt Clamps
SERVICES WE OFFER:
— On-Site Machining
— Bolt Tensioning
— Special Purpose Machine Tools
— Laser Alignment Services
— NDT Services
— Regenerator & Vessel Head Removal



T: +44 (0) 1522 791 721 F: +44 (0) 1522 790 033 service@destec.co.uk sales@destec.co.uk WWW.DESTEC.CO.UK
Shell Publishes Energy Transition Strategy 2024
Shell will continue its drive to halve emissions from its operations (Scope 1 and 2) by 2030, compared with 2016 on a net basis. By the end of 2023, Shell had achieved more than 60% of this target. Shell also reduced the net carbon intensity of the energy products it sells by 6.3% compared with 2016, the third consecutive year it hit its target.
To help drive the decarbonisation of the transport sector, Shell has set a new ambition to reduce customer emissions from the use of its oil products by 15-20% by 2030 compared with 2021.
Shell confirms it will invest $10-15 billion between 2023 and the end of 2025 in lowcarbon energy solutions, making Shell a significant investor in the energy transition.
London, Shell plc (Shell) has published its first energy transition update since the launch of its Powering Progress strategy in 2021. At our Capital Markets Day in June 2023, we outlined how our strategy delivers more value with less emissions, emphasising the “more value” part. In this energy transition update, we are focusing on how the same strategy delivers “less emissions”.
Our target to achieve net-zero emissions by 2050 across all our operations and energy products is transforming our business. We believe this target supports the more ambitious goal of the Paris Agreement to limit global warming to 1.5°C above pre-industrial levels. Shell’s strategy supports a balanced and orderly transition away from fossil fuels to low-carbon energy solutions to maintain secure and affordable energy supplies.
“Energy has made an incredible contribution to human development, allowing many people around the world to live more prosperous lives.

Today, the world must meet growing demand for energy while tackling the urgent challenge of climate change. I am encouraged by the rapid progress in the energy transition in recent years in many countries and technologies, which reinforces my deep conviction in the


direction of our strategy,” said Wael Sawan, Shell’s Chief Executive Officer.
“Shell has a very important role to play in providing the energy the world needs today, and in helping to build the low-carbon energy system of the future. Our focus on performance, discipline and simplification is driving clear choices about where we can have the greatest impact through the energy transition and create the most value for our investors and customers. We believe this focus makes it more, not less, likely that we will achieve our climate targets. By providing the different kinds of energy the world needs, we believe we are the investment case and the partner of choice through the energy transition,” said Sawan.
Our energy transition plans cover all our businesses. Liquefied natural gas (LNG) is a critical fuel in the energy transition, and we are growing our world-leading LNG business with lower carbon intensity. We are cutting emissions from oil and gas production while keeping oil production stable, and growing sales of low-carbon energy solutions while gradually reducing sales of oil products such as petrol, diesel and jet fuel. As one of the world’s largest energy traders, we can connect the supply of low-carbon energy to demand, as we have done for many years with oil and gas. •
80
HEALTH, SAFETY & ENVIRONMENT







LISBON ENERGY SUMMIT & EXHIBITION 2024 27 - 29 MAY 2024 FIL - Lisbon Exhibition & Congress Centre Lisbon I Portugal GREEN HYDROGEN WIND & SOLAR CARBON MITIGATION CREATING TOMORROW’S ENERGY SYSTEM TODAY ENERGY STORAGE FOR FOR MORE INFO ON PARTICIPATING LNG Jonathan Haselden Event Director sales@lisbonenergysummit.com lisbonenergysummit.com ORGANISED BY FROM THE ORGANISERS OF #LESummit 150+ 250+ INDUSTRY LEADING SPEAKERS 3,000+ GLOBAL ATTENDEES 90+ COUNTRIES REPRESENTED SPONSORS AND EXHIBITORS
Reducing Emissions from Sleipner and Gudrun
The Sleipner field centre, along with the Gudrun platform and other associated fields, is now partly operating on power from shore. This will reduce annual emissions from the Norwegian continental shelf (NCS) by 160,000 tonnes of CO2.
All installations on the Utsira High are now receiving power from shore, saving emissions amounting to about 1.2 million tonnes of CO₂ per year. The electrification of the installations on the Utsira High is in line with the plan for development and operation (PDO) for Johan Sverdrup phase 2, which was approved by the Norwegian parliament in 2019.
“Electrification is the most effective tool in our toolbox in our quest to achieve the national target of halving greenhouse gas emissions from Norwegian oil and gas production by 2030,” says Geir Tungesvik, executive vice president for Projects, Drilling & Procurement.
One of two operative gas turbines on the Sleipner A platform will gradually be shut down as a relevant systems transition to using power from shore. The other gas turbine will stand by as a back-up power source during a run-in phase. In the longer run, Sleipner will have the opportunity to fully operate on power from shore.
The Sleipner field centre has been supplied with onshore power via a cable from the Gina Krog platform since 24 March 2024. Starting on the same date, the Gudrun platform was connected to electricity through the existing cable to Sleipner.
“The Sleipner area has delivered vast volumes of energy, created long-term ripple effects and contributed substantial values to the Norwegian society. With power from shore, we can develop

new discoveries and resources from lowemission production, and gas export from the area can be maintained for a long time to come,” says Kjetil Hove, executive vice president for Exploration & Production Norway.
The Sleipner fields are among the largest


gas producers in the North Sea and serve as a hub for gas transport to Europe. Norwegian gas plays an important role in the EU’s energy transition. Now, also the gas that would otherwise be burnt on the installations can be utilised more effectively in Europe.
“The electrification of the Sleipner field centre has created important jobs and ripple effects for the Norwegian supply industry. I’m also very pleased with that we, our partners, and suppliers, have succeeded in implementing the project safely, with zero HSE incidents,” Tungesvik says.
Overall investments in the project total NOK 1.08 billion.
In 2020, the Sleipner partnership exercised an option with Aibel for an EPCIC contract (engineering, procurement, construction, installation and commissioning) for the modification work on the Sleipner field centre. NKT was awarded the contract to manufacture and lay the power cables.
The EPCIC contract has a value of about NOK 700 million and has contributed to 250 fulltime equivalents at Aibel’s Stavanger office, offshore and at the shipyard in Haugesund. ABB has carried out substantial work as a subcontractor within installation of high-voltage equipment and updating the power control system. •
82
HEALTH, SAFETY & ENVIRONMENT
Subsea Test Tools
Save time & money on subsea testing operations. C-Kore subsea testing tools are simple and automated, no specialised offshore personnel are required. With their compact size, they can quickly be mobilised anywhere in the world for fault finding, umbilical installation or sensor testing.
Automated Testing
Hand-carry mobilisation

No personnel required
Remote C-Kore support

www.c - kore.com Tel: +44 1904 215161 • Email: sales@C-Kore.com
• SUBSEA TDR • OPTICAL TDR • SENSOR
NEW! Optical TDR version now available SIMPLETOUSE!
INSULATION RESISTANCE
MONITOR
BP Pulse Acquires One of Europe’s Largest Truck Stops, Unveiling Ambitious Plans to Help Heavy Goods
Vehicles (HGVs) Electrify
bp pulse acquires the freehold of a strategically placed truck stop in Ashford, Kent – one of the largest in Europe
The truck stop’s proximity to Dover and the Eurotunnel, where 3.5 million heavy goods vehicles (HGVs) cross the English Channel annually, provides bp pulse with the opportunity to support HGV operators transitioning to EVs bp pulse plans to transform the site with mega-watt EV chargers for HGVs
bp pulse, bp’s electric vehicle charging brand, has acquired the freehold of one of the largest truck stops in Europe, Ashford International Truckstop in Kent, as part of its drive to support HGV fleets as they electrify.
Strategically located off junction 10 and 10a of the M20, Ashford International Truckstop is close to Dover, the UK’s busiest ferry port, and LeShuttle Freight via the Eurotunnel terminal in Folkestone. Approximately 3.5 million heavy goods vehicles (HGVs) travel across the channel via the port of Dover and Eurotunnel each year. The acquisition presents bp with the opportunity to help meet the comprehensive needs of UK and European HGV operators transitioning to EVs.
The site has the capacity to host approximately 20 mega-watt chargers (MCS), 10 x 400kW and 125 x 100 kW chargers. This capacity is subject to power connection availability and the pace of electrification in the UK and European road freight sector. It could enable bp pulse to install a range of charging options suitable for both on-the-go and overnight HGVs.
“For fleet operators to consider going electric, they must be confident that the infrastructure is in place to support them. That is why we are thrilled to have secured the land to a crucial site near Dover as we strive to meet the evolving needs of HGV operators transitioning to EVs.”
Stefan von Dobschuetz, general manager, bp pulse Europer
The first mega-watt chargers are expected to be in place from 2026. A mega-watt charger has the potential to fully charge an HGV in up to 45 minutes, enabling an onward range of ~310 miles (500km) in a single charge1, depending on EV model, battery, the weather and driving conditions.
Stefan von Dobschuetz, general manager bp pulse Europe, said: “For fleet operators to consider going electric, they must be confident that the infrastructure is in place to support them. That is why we are thrilled to have secured the land to a crucial site near Dover as we strive to meet the evolving needs of HGV operators transitioning to EVs. The location


of this truck stop aligns with our mission to provide accessible and strategically positioned charging infrastructure for our customers along the major truck corridors in Europe.
“Now we need to unlock the EV charging potential at this site. We look forward to working with national energy infrastructure partners to facilitate timely power connections for our ambitious project.”
Ashford International Truckstop is currently owned by the GSE Group. The 21-acre site already offers 660 secure parking bays and convenience services for HGV drivers. As part of the agreement, bp pulse will lease back the site to Ashford International Truckstop Ltd, part of GSE Group, to operate the existing site facilities and secure parking on a long-term lease. bp pulse will operate and manage the EV charging infrastructure.
Darrell Healey, chairman of GSE Group, said: “We know the industry, including many of our clients, want to go electric. They will need convenient and quick charging infrastructure in the right locations, which is why the combination of the truck stop at Ashford and bp pulse works so well.
“Our knowledge and experience of operating arguably the best truck stop in the UK, combined with bp pulse’s capabilities in building the EV-charging infrastructure required by our existing and future customers, is a perfect partnership. We’re looking
forward to seeing our site evolve and serve such E-trucks and to continue to explore other potential truck stop projects in the UK.”
bp aims to create a network of mobility hubs along key logistics corridors across UK and Europe, providing freight operators with a range of energy options, including traditional fuels to support its fleet customers at every stage of their decarbonization journey.
Already in action, bp is supporting the decarbonization of road transportation.
“bp fleet solutions provide innovative energy and mobility solutions to help fleets of all shapes and sizes decarbonise, today, tomorrow, together. Across Europe, we support 1.8 million fleet drivers providing fuels, charging and convenience offers across key logistics routes. This acquisition will be a great addition to our offering,” said Alex Eftimiu, vice president Fleet Europe, bp.
In January 2023, bp launched Europe’s first truck-charging corridor along a 600km stretch of the Rhine-Alpine corridor across Germany. 21 Aral pulse (bp’s brand in Germany) EV truck stops are already operational in Germany enabling an electric truck to cover over 750km across multiple routes throughout Germany. Once the EV chargers are installed on the acquired site, bp pulse is set to establish a link between the UK and its German charging corridor to further encourage HGV operators to shift to electric. •
84
HSE

Valves for Hydrogen, Carbon Capture, Topside, Subsea, and Pipeline Applications.

Instrument & DBB Valves
• Manifolds, Needle, Check and DBB Valves to 22.5K psi
• Cryogenic

• Severe Service 650ºC, 10K psi
• Forged & Bolted Construction

Hydrogen & Carbon Capture Valves
• Instrumentation, Ball, Needle and DBB Valves for Hydrogen and Carbon Capture Applications
• Pipeline Ball Valves upto 18”


Pipeline Valves
• 1” to 20” Bore Size
• High Temperature
• High Pressure
• Cryogenic
• API 10K Design






• 10K Ball Valves for Hydrogen Fuelling Stations



Subsea Valves
• Diver & ROV Operated Needle Valves
• Ball Valves Upto 15K
• Manual & Hydraulic Parallel Slide Gate Valves 3/8”, 1/2”, 3/4” and 1”




World-leading We
Manufacture Valves for Global Energy Projects. To Find Your Local Supplier, Contact Us Today.
+44 (0)1565 632 636 | sales@valves.co.uk | www.valves.co.uk Reliability Under Pressure Oliver Valves Ltd Parkgate Industrial Estate, Knutsford, Cheshire, WA16 8DX, United Kingdom We Innovate Valves. We Build Valves. We Are Valves.
Conocophillips Reports Fourth-Quarter and Full-Year 2023 Results, 123% Preliminary Reserve Replacement Ratio; Announces 2024 Guidance and Planned Return of Capital of $9b; Declares Quarterly Ordinary Dividend and Variable Return of Cash Distribution
ConocoPhillips reported fourth-quarter 2023 earnings of $3.0 billion, or $2.52 per share, compared with fourth-quarter 2022 earnings of $3.2 billion, or $2.61 per share. Excluding special items, fourth-quarter 2023 adjusted earnings were $2.9 billion, or $2.40 per share, compared with fourth-quarter 2022 adjusted earnings of $3.4 billion, or $2.71 per share. Special items for the current quarter were comprised of a benefit related to the reversal of a tax reserve, partially offset by a loss on foreign exchange contracts.
Full-year 2023 earnings were $11.0 billion, or $9.06 per share, compared with full-year 2022 earnings of $18.7 billion, or $14.57 per share. Excluding special items, full-year 2023 adjusted earnings were $10.6 billion or $8.77 per share, compared with full-year 2022 adjusted earnings of $17.3 billion, or $13.52 per share.
“During 2023, ConocoPhillips continued to demonstrate strong financial and operational performance, executing on our returnsfocused value proposition,” said Ryan Lance, chairman and chief executive officer. “We achieved record production, reached several key milestones across our global operations and returned $11 billion to shareholders. We also continued to enhance our portfolio by opportunistically acquiring the remaining 50% of Surmont, reaching a final investment decision on the Willow project in Alaska and further progressing our global LNG strategy. We remain committed to our Triple Mandate of responsibly and reliably meeting energy transition pathway demand, delivering competitive returns on and of capital, and achieving our net-zero operational emissions ambition. Our deep, durable, and diversified portfolio continues to generate robust cash flow, enabling us to start the year with a $9 billion return of capital target.”
Full-year summary and recent announcements
• Generated cash provided by operating activities of $20.0 billion and cash from operations (CFO) of $21.3 billion.
• Distributed $11.0 billion to shareholders through a threetier framework, including $5.6 billion through the ordinary dividend and variable return of cash (VROC) and $5.4 billion through share repurchases.
• Achieved 17% return on capital employed; 19% cashadjusted return on capital employed.
• Ended the year with cash and short-term investments of $6.9 billion.
• Delivered record full-year total company and Lower 48 production of 1,826 thousand barrels of oil equivalent per day (MBOED) and 1,067 MBOED, respectively.
• Acquired the remaining 50% interest in Surmont for approximately $2.7 billion as well as future contingent payments of up to $0.4 billion CAD ($0.3 billion).
• Made final investment decision (FID) on the Willow project.
• Progressed global LNG strategy through expansion in Qatar, FID at Port Arthur LNG, regasification agreements in the Netherlands and offtake agreements in Mexico.
• Reached first production at several subsea tiebacks in Norway, Surmont Pad 267 in Canada and Bohai Phase 4B in China.
• Commenced startup at the second phase of Montney’s central processing facility in Canada.
• Awarded Gold Standard Pathway designation by Oil and Gas Methane Partnership 2.0.
• Accelerated the company’s GHG emissions-intensity reduction target through 2030 from 40-50% to 50-60%, using a 2016 baseline.
Borr Drilling Limited – Announces Pricing of Additional $200 Million Offering of 10.000%
Senior Secured Notes due 2028
Hamilton,
Bermuda, Borr Drilling Limited announced today that its wholly-owned subsidiary Borr IHC Limited has priced an offering of an additional $200 million in aggregate principal amount of 10.000% senior secured notes due 2028 (the “Additional Notes”).
The Additional Notes will have the same terms and conditions as the $1,025,000,000 aggregate principal amount of senior secured notes due 2028, which were issued on November 7, 2023 (the “Original 2028 Notes”). The Additional Notes mature on November 15, 2028. The Additional Notes will be treated as additional notes under the indenture and will be issued bearing the same ISIN and common codes as the Original 2028 Notes, and will be fully fungible and constitute a single series with the Original 2028 Notes.
The proceeds from the offering are intended to be used for general corporate purposes, which may include, among other things, capital expenditures, including delivery costs for newbuild rigs on order, costs in connection with activations of these rigs, optimization of the shipyard newbuild financing currently in place and select asset additions, or funding of our working capital.
Settlement of the notes offering is expected on or about March 12, 2024, and is subject to customary closing conditions.
This information is considered to be inside information pursuant to the EU Market Abuse Regulation and subject to the disclosure requirements pursuant to section 5-12 of the Norwegian Securities Trading Act. •

86 NEWS - FINANCE
FUTURE ENERGY ASIA
Queen Sirikit National Convention Center
Bangkok, Thailand
Hosted
By
Hosted by the Ministry of Energy, Thailand and co-hosted by PTT Group and EGAT, the Future Energy Asia Exhibition and Summit, incorporating the Future LNG Asia, and Future Mobility Asia events, will be held in Bangkok, Thailand, on 15 – 17 May 2024, convening over 22,000 international energy professionals, investors, and innovators to influence, support and deliver Asia’s clean energy vision.
Once again serving as the platform to showcase Asia’s energy transition and clean mobility mission on the global stage, Future Energy Asia is more than an annual international industry event; it is a collective call to action for Asia to harness the immense potential of its own transformation journey.
Register today and be a part of the crucial public and private sector dialogues and cross-sector industry partnerships that will help enable Asia to lead the world on the pathway to secure, affordable and sustainable energy generation.




15
17
2024
-
MAY
GET YOUR VISITOR PASS TODAY www.futureenergyasia.com International Speakers 600+ Strategic, Technical & Partner Conference Sessions 300+ Conference Delegates 2,500+ Global Energy & Mobility Attendees 22,000+ Exhibiting Companies 350+ Participating Countries 70+ Associate Sponsors Supported By Organised By Technical Conference Sponsor Innovation Partner Co-Located With Gold Sponsors Bronze Sponsors Silver Sponsors Co-Hosts Diamond Sponsor
2024 IMPORTANT EVENTS CALENDAR
AUVSI XPONENTIAL 2024
APRIL 22, 2024 - APRIL 25, 2024
San Diego, USA
https://www.auvsi.org/events/xponential/xponential-2024
SPE Norway Subsurface Conference
17.04.2024
Bergen, Norway
https://www.spe-events.org/norwaysubsurface
Offshore Technology Conference
1-4 May 2024
Houston, Texas, USA
Global Energy Show 2024
Calgary, Canada
June 13-15 June 2024
https://www.globalenergyshow.com
SPE Oilfield Scale Symposium
05.06.2024 - 06.06.2024
Aberdeen, Scotland
https://www.spe-events.org/oilfieldscale/welcome
SPE Europe Energy Transition Conference
26.06.2024 - 28.06.2024
Turin, Italy
Carbon Capture Technology Expo & Conference North America
26.06.2024 - 27.06.2024
Houston, Texas
https://www.ccus-expo.com
Rio Oil & Gas 2024
09.09.2024
Rio de Janeiro
World Hydrogen Week
30.09.2024 - 04.10.2024
Copenhagen https://www.worldhydrogenweek.com
World Hydrogen Mobility
10.12.2024 - 12.12.2024
Stuttgart
https://t.ly/Z1xH4

89
April 22-25, 2024 | New Orleans
The International Partnering Forum (IPF) is the premier offshore wind energy conference in the Americas.
Hosted by the Oceantic Network, formerly the Business Network for Offshore Wind, IPF connects global leaders and businesses in the supply chain, offers unparalleled networking opportunities, and delivers the most timely and relevant updates on the industry. With the rapid expansion of offshore wind on a global scale, IPF attendance helps secure your place as a leader in the industry.
Located in the heart of America’s offshore energy industry, New Orleans will host 2024 IPF just as the Gulf of Mexico begins developing its offshore wind market. Gulf companies are already hard at work building America’s next energy industry and moving to integrate new technologies like green hydrogen into offshore wind. Embracing its offshore energy past and embracing the future of offshore wind, New Orleans and the state of Louisiana are emerging as a center of experience, expertise, innovation, and heart of this new industry.
OCEANTIC NETWORK oceantic.org Oceantic Network @oceanticnetwork
Beacon Offshore Energy takes FID on Winterfell, offshore US Gulf of Mexico

Afinal
investment decision (FID) on the Winterfell field development has been taken by Beacon Offshore Energy (BOE). The field, operated by BOE’s subsidiary BOE Exploration & Production and located in the US zone of the Gulf of Mexico, will be developed as a subsea tie-back.
The development plan includes the connection of Winterfell to the Heidelberg spar (operated by Anadarko Petroleum) through a 21km subsea tie-back. First oil is scheduled for the second quarter of 2024, with Winterfell’s three initial wells reaching a production of approximately 22,000 barrels of oil equivalent per day (boepd).
Besides BOE’s operating stake (35.41%), the project is also owned by Kosmos Energy (25.04%), Westlawn GOM Asset 3 (15%), Red Willow Offshore (12.5%), Alta Mar Energy (7.55%) and CSL Exploration (4.5%). •
Noting a growing trend of companies wanting to move toward vendors that offer holistic solutions, Verdantix reviewed 15 providers of energy management solutions around the world.
“Schneider Electric’s EcoStruxure Platform, scoring highest both in capabilities and in momentum in this Green Quadrant report due to its comprehensive offering,” said Harry Wilson, industry analyst and lead author of the report. “The solution provides true end-to-end energy management, helping customers on their journey to net zero.”
“The report’s findings showcase not only our commitment to delivering comprehensive solutions that drive electrification and digitalization — which together are the fastest route to net zero — but also our preparedness to serve as a trusted partner and consultant across every aspect of energy management,” said Olivier Blum, Executive Vice President, Energy Management at Schneider Electric. “We have identified a list of 10 tangible priorities for driving the decarbonisation buildings – with energy management software and data at the core of these actions – and it’s great to see external validation for our approach.”
Verdantix highlighted Schneider Electric’s technological expertise, calling out the company’s ability to provide comprehensive packages that capture and combine data from both building management and power management solutions, and turning that data into actionable insights for customers. The report assessed several Schneider Electric products, including EcoStruxure Building Advisor, EcoStruxure Building Operation, EcoStruxure Microgrid Advisor, EcoStruxure Power Advisor, EcoStruxure Power Monitoring Expert, and EcoStruxure Resource Advisor. •
Schneider Electric Recognised as a Leader in Energy Management Software by Independent Research Firm
Schneider Electric, the leader in the digital transformation of energy management and automation, earned the leader ranking in Verdantix’s recent “Green Quadrant: Energy Management Software 2023.” This recognition highlights Schneider Electric’s comprehensive capabilities and solutions and progressive approach to system integration.
The global energy and climate crises have generated a surge of interest in energy management software, as organisations actively seek solutions to address energy price volatility and accelerate the decarbonisation of buildings and other facilities. Recognising this pressing need, Verdantix’s report, the first of its kind by the respected research and advisory firm, addresses the growing demand from real estate and facilities executives for information on high-quality energy management solutions.
Buildings account for 37% of global carbon emissions, with 26% attributed to building energy consumption, according to the IEA Tracking Clean Energy Progress report. With digital solutions providing the fastest path to net zero, organisations that prioritise efficiency can make significant progress in tackling the climate and energy crisis while unlocking substantial cost savings.
Construction Begins in Australia for 414MW Uungula Wind Farm
SquadronEnergy has disclosed that the construction phase of its Uungula wind farm project has officially begun. The 414MW power plant is being built in New South Wales, Australia, and will feature 69 turbines capable of producing enough power to meet the demands of more than 220,000 homes.
The facility, located 14km east of Wellington, will also include an energy storage element. GE Vernova is Uungula’s turbine supplier and engineering, procurement and construction (EPC) contractor.
Uungula is calculated to avoid the emission of at least 560,000 tonnes of carbon per year once it’s operational. •

NEWS - OIL AND GAS INDUSTRY


ading the way to FPSO AGOGO Emissions F Emissions F
garded as an industry leading pro mission design and implementatio


Closed Flare and Hydrocarbon Blanketing | Combined Cycle Power Generation
Carbon Capture and Storage | Electrification | Seawater Turbine Generator

Yinson Production is one of the largest independent FPSO leasing companies globally, driven by its excellent project management team, industry-leading safety and uptime performance and leadership position in sustainable FPSO design.
Yinson Production's Zero Emission FPSO Concept is paving the way for the decarbonisation of the FPSO industry and aligns with Yinson Group’s Climate Goals to be carbon neutral by 2030 and net zero by 2050.
www yinson com